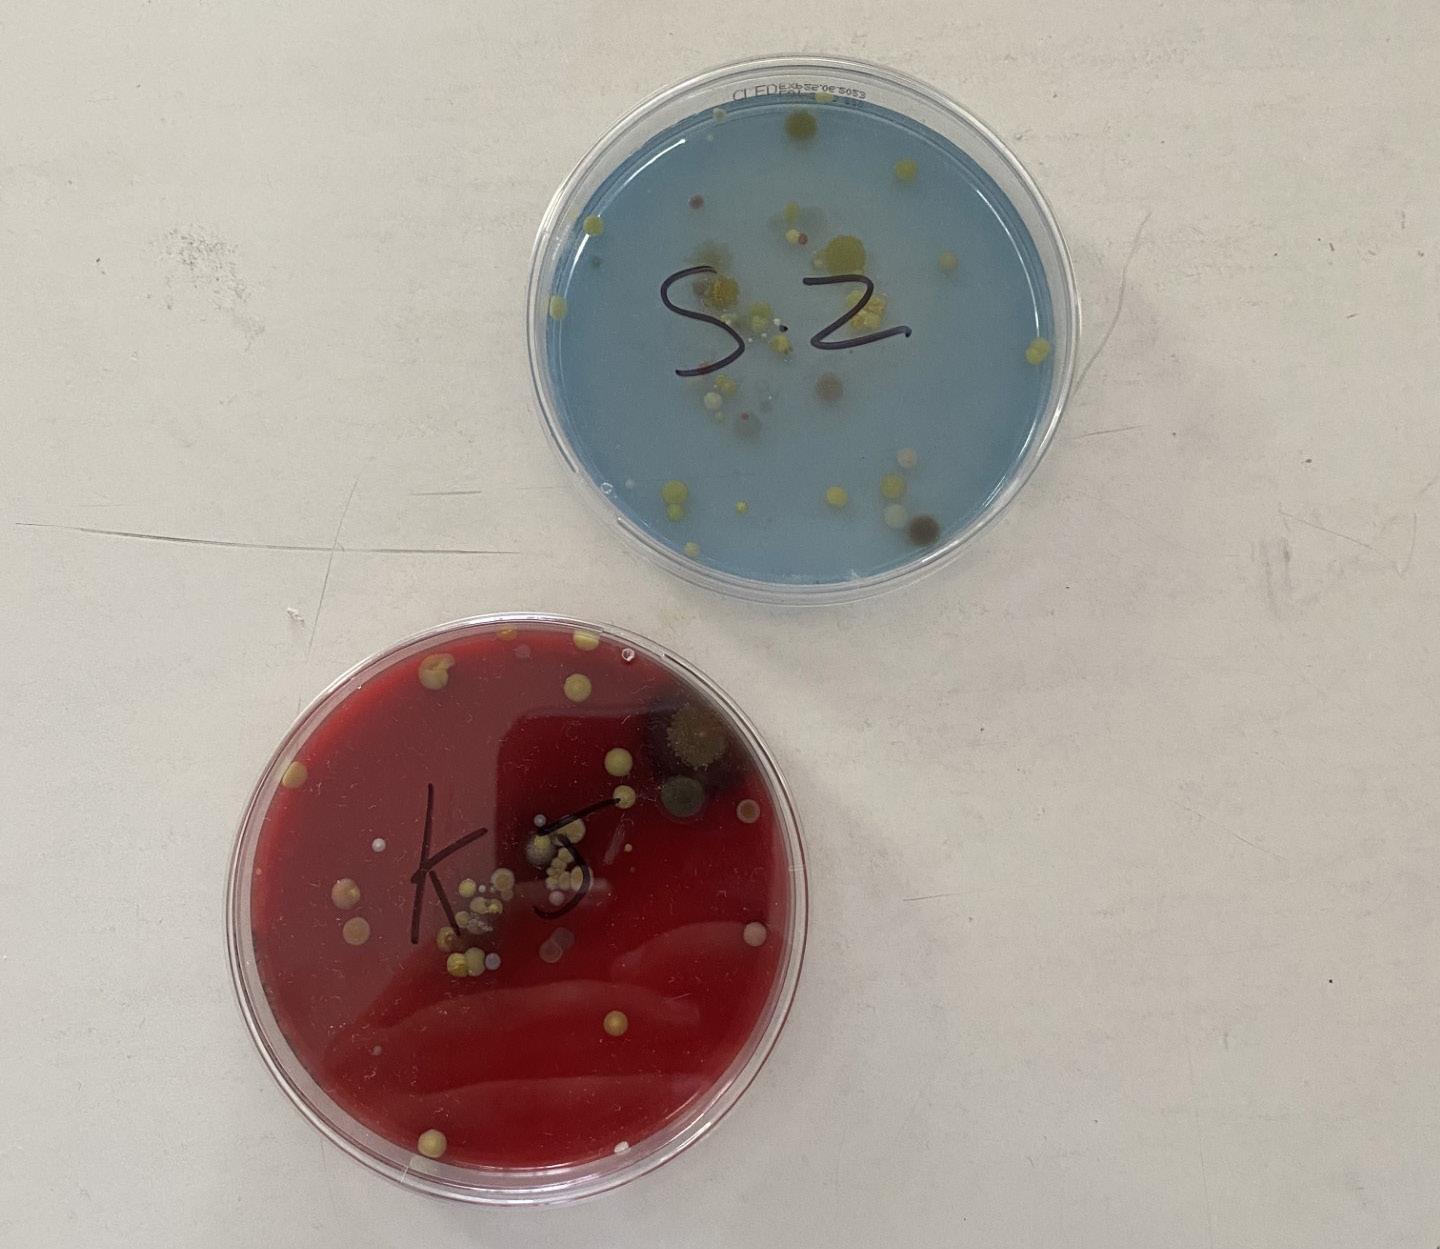

The International Voice































We all want what is best for our children, seeking to provide the very best opportunities to prepare them for a bright future. Our proposal is to build their future together, by offering your children access to a world-class educational experience, at a top private school.
Now you can access the educational programmes at International British School of Bucharest (IBSB) through the new Education Loan product available from UniCredit Consumer Financing.
• Financing for school fees of up to 120,000 de Lei.
• Loan reimbursement in equal intalments
• Easy application process, directly at the IBSB Admissions Office.


insurance premium financed by the Lender is 3,240 Lei, calculated as a percentage of 0.5% of the loan value of 54,000 lei and multiplied by the 12-month loan period, resulting in a borrowed value of 57,240 lei. The cost of financing by the Lender of the single life insurance premium is 0 Lei, calculated by applying the annual interest rate of 0% to the value of the loan representing the single insurance premium. EAR is calculated according to the legal regulation in force and includes annual fixed interest rate, file analysis fee (0 Lei), monthly credit administration fee (0 Lei) and, in the case the client acquires a life insurance, the cost of the insurance premium.
The decision for crediting belongs solely to UniCredit Consumer Financing IFN SA, the Creditor reserving the right to request, when the case requires, any documents necessary in the crediting analysis, according to its internal regulations and the legal effective settlements. The present does not value, according to the law, the offer to contract financial products / services from UniCredit Consumer Financing IFN S.A., which can be modified or revoked at any time. According to the law, the product or financial service offer is the one valid at the time of registration of the product / service request and, regardless of the elements of the respective offer, the contract is considered concluded only on the date of its formal signature or, as the case may be, according to the legal provisions applicable to the remote contract conclusion. For the avoidance of any doubt, this document is not a binding offer and does not create any obligation or liability whatsoever for UniCredit Consumer Financing IFN S.A., does not represent an offer as defined by Romanian law, and any understanding between the parties will be concluded only at the moment of signing of a credit contract. The above mentioned financial terms are subject to: (i) the applicable legal provisions and could suffer modification in case of any material changes in legal provisions related to the consumer protection and products pricing.

Editor’s Note: Embracing New Horizons and Unforgettable Journeys
by Medeea Constantinescu (Year 13), Student Editor and Deputy Head GirlDear IBSB Community,
Today is the da following the Year 13 End of Year Graduation Ceremony. Today is also the day I am writing my final Editor’s Note for the TIV.
As we turn the pages of our lives, we more often than not find ourselves at poignant and exhilarating crossroads. The time has finally come for me to bid adieu to the familiar halls of our beloved IBSB and embark on a new chapter that awaits me at Bocconi University. Our hearts brim with a mix of emotions - excitement, nostalgia, and a touch of apprehension - as we step onto the threshold of the future.
Throughout my 13 years at IBSB (Its hard to beleive I have been here since 2010), I have grown not just academically, but also as an individual with dreams, passions, and the unwavering determination to pursue excellence. Our school has been more than just a place of learning; it has been a canvas upon which we have painted memories, formed friendships, and nurtured the seeds of our ambitions. From early mornings spent in classrooms to school trips away in different countries, we have faced challenges head-on, celebrated triumphs, and forged connections that will endure the test of time.
It is, therefore, with mixed feelings that I leave IBSB, having spent 3 quarters of my life iwalking these hallowed halls. We have a saying

in Romanian: “ With one eye smiling, with one eye crying”. While change is necessary for growth - and I have high aspirations for the future - a large part of me also wishes I didnt have to leave.
Before I leave, I would like to convey a loud, genuine ‘Thank you!’ to all my teachers, to all the supporting staff, and to my colleagues. I cannot wait to see all of you at the future IBSB alumni reunion.

Fare Well From Your Head Girl
by Maria Sticlea (Year 13), Head GirlAs someone who has spent the better part of a decade at IBSB, witnessing the many changes that have taken place over the years, it feels almost unbelievable that my class and I have finally graduated, saying farewell to childhood and the IBSB community, which has been an extended family to many of us, as we prepare to take our next confident step into adulthood and our lives to come.
This school has, over time, done more than simply provide us with a holistic education: being put in charge of our own learning in the Sixth Form and being granted more autonomy has allowed us to experience first-hand what life at university will be like, enabling and encouraging us each to develop the self-management skills that make us well-balanced adults and soon to be working professionals.
Through Community Action Service, we have grown and mature as individuals learning how fulfilling altruism and philanthropy can be, and how gratifying it is to be dedicated to a cause larger than ourselves, removing us if only for a short period of time from the privileged bubbles we live in to see the challenges that others face.
Our teachers’ generosity and dedication to our learning and development have provided us with role models, whose footsteps we can only hope to walk in, becoming kinder, more passionate, and committed individuals, and so I would like to thank them for everything they have done for me and my classmates. Their involvement has fostered growth and a passion for learning on so many occasions, guiding us towards the academic path we will be pursuing at university and beyond, and I am so grateful to have had teachers that went above and beyond when explaining and teaching their subjects, instead of just sticking to the curriculum.

After so much time spent together, it is almost heart-breaking to think that my classmates and I will soon become more distant strangers, separated by time and space, with only a shared memory, a shared past, and a previously shared location for 7-8 hours a day as a reminder of your time together. If any of this year’s graduating class are reading this, I want to say to you that it has been an absolute honour and a pleasure to share the last 2,3,5, 10 years with you. Although our paths now separate, as we move into the next stage of our lives, I truly hope that they will cross again, intertwining as we go out into the world to make a name for ourselves. I wold like to wish each and everyone one of you the success you deserve in your future careers and lives, and I look forward to catching up with you all at a future IBSB alumni gathering.
I hope that I and the rest of the Senior Prefect team have done our roles justice this year, and that the next generation will learn from our mistakes and setbacks, and succeed in doing an even better job than we have.
Until then, I wish you all a relaxing and refreshing summer holiday and all the best for the year ahead; I hope you get to make the best of your time away from school, and will return in autumn feeling renewed and ready for what is bound to be another busy year. Happy holidays!

Why Become an HPL Peer Accreditor?
by Kendall Peet, Head of SchoolWhy Become an HPL Peer Accreditor?
When Michelle Bradley reached out to ask me if I would be interested in becoming an HPL Peer Accreditor, it didn’t require a lot of thought, or time, to reply in the affirmative. My school had just completed its two year journey as an HPL Pathway School, and I was interested to see the impact that HPL was having in other educational contexts and settings.
Unlike Ofsted and BSO inspections, HPL Peer Accreditation visits guarantee an up close and personal view of an excellent/ outstanding school, which is equivalent to hitting the jackpot in regard to professional development and the potential for takeaways. This was certainly the case for me.
Last year, for example, I was fortunate to have been offered the chance to accredit two HPL Pathway Schools: Gems Wellington Academy Silicon Oasis and GEMS FirstPoint School, two outstanding BSO inspected schools in the UAE experiencing exponential growth, with High Performance Learning at the very heart of their teaching and learning pedagogy.
I read through their inspection reports and pre-accreditation materials with great interest, reflecting on their unique take on HPL, whilst comparing their journey to that of my own school, reviewing the impact of HPL on the quality of teaching and learning, student progress and attainment, and student wellbeing. The samples of evidence provided beckoned further investigation in many areas, and so I looked forward keenly to my visit.
The challenge lay not in finding evidence to support accreditation, for which there was plenty, but rather in deciding how best to use my time, as an accreditation visit takes place on a single day, with effectively 6 hours to walk the halls, visit the classrooms, and speak with the students, staff, parents, and senior leadership team. It’s like a single day pass to a theme park like Disneyland that takes a least three full days to experience all the attractions.

So on the day of my first accreditation visit, I eagerly skipped breakfast at the hotel in order to be standing side by side at the front gate with David Wade, the principal of GEMS FPS, and his senior leadership team, as they warmly greeted their students walking by proudly wearing their HPL Ambassador Badges. I walked a marathon, I interviewed my way through lunch, and keenly used every minute of my available time, right up to the senior leadership team feedback session that took place long after the home bell had rung. My only regret, in fact, was that I didn’t have more time, to see more, to do more, to learn more; I was like a contestant in The Money Machine with Jeremy Beadle and the clock counting down.
In sum, I cannot speak highly enough of my experience as an HPL Peer Accreditor, which is just one of the many benefits of becoming an HPL school. As heads of schools judged outstanding, it is not at all uncommon to find ourselves asking the question ‘What next?’ In this regard, HPL is the perfect answer or antidote. Seeing other outstanding schools up close provides the perfect opportunity to view education anew, to refuel with new ideas, to clarify or refresh your vision, ready to lead your school forward through the next round of school development.

High Performance Learning at IBSB
by Lee Hawkins & Darren Laffar IBSB HPL Coordinators

As we come to the end of the third year of our incredible journey as an HPL School, our first year as a fully accredited World Class HPL school, it is worth pausing for a moment, before we look back over the year, to aprise ourselves or perhaps just remind ourselves of a few basics.
What is High Performance Learning?
High Performance Learning (HPL) is an educational framework and approach that aims to maximize the potential of students by developing a set of high-performance characteristics and skills,
otherwise known as competencies – 30 explicit competencies to be most accurate. The approach is based on twenty years of research by Professor Deborah Eyre, an expert in gifted education and assessment, originally published in a paper titled ‘Room at the Top: Inclusive Education for High Performance’ (2011), which you can access in full at the following link: Room-at-the-top-inclusiveeducation-for-high-performance.pdf. It is admittedly 66 pages long, but well worth reading as in provides keen insights into the thinking behind the evolution of HPL pedagogy to the present day form.
Moving forward from 2011 to 2023, we can now say quite firmly and confidently, having collected a substantial body of firsthand evidence from the growing community of HPL World Class Schools around the world, that focusing on developing a high performance mind-set, based on the HPL framework, which at its core holds the firm belief that every child is capable of achieving high performance over time, results in significant gains made in regard to both student progress and attainment.
When we talk about high performance, we are referring to the aspirational learning journey toward excellence or mastery, which to put it another way, equates to exceeding national expectations...by a considerable amount.
It is important to acknowledge that each student is unique, and that each has their own starting point; this is even more so, when we take into account the fact that students join IBSB at different points in their education. What all students have in common, however, is their shared potential to achieve mastery. It is the commitment and belief of our HPL staff in this journey that ensures every child journey IBSB begins their HPL journey with the opportunity to develop the thirty competencies embedded across the curriculum, from the early years programme right through to year 13 in the Sixth Form.
The core pillars of the High Performance Learning framework resets in developing the competencies related to ‘how good learners think’ and ‘How good learners behave’. These competencies are referred more specifically as the Advanced Cognitive Performance Characteristics (ACPs) and Values, Attitudes & Attributes (VAAs)
Pupils will learn the definitions of these characteristics. They will then also learn how these apply to what they are learning.
IBSB were awarded HPL “World Class School” status in June 2022.
Since accreditation, we have continued our journey, further embedding HPL within the framework of the school to provide ever more opportunities for our students to acquire and develop the competencies that will be essential to succeed in a world where the fast pace of change necessitates lifelong learning.

The IBSB HPL Journey in 2022-23
This year, our staff have focused on developing as HPL practitioners through “PLC (Professional Learning Community) Groups” and “Learning Rounds”. Staff were placed into small groups, consisting of 3 to 5 members, to focus on a specific “Question of practice”. This question had to be HPL focused, possibly directed toward a competency they wished to focus on in order to deliver it more confidently within the subject curriculum content. For example, one group had the goal to “Introduce at least one HPL competency into every lesson, ensuring that pupils were aware which HPL competency they are using and developing and why.” The PLC groups each worked on their question throughout the year, supporting each other along the way, to better develop and devise strategies to improve their practice. It has proven to be a great success, with staff feedback from this strategy of selfdevelopment being overwhelmingly positive.
The pupil focus conversely has been to develop their use of the HPL “language” – for example, the primary school have the definitions of the characteristics clearly visible so the pupils can then use them for explanations and feedback. These are used to reflect in each lesson, something we will look to continue to develop, next year.
Looking forward to 2023-24
Our upcoming actions, as outlined in our updated roadmap, involve increasing parental involvement in our High Performance Learning (HPL) journey, and empowering students to help introduce HPL to the new members of our community. As a starting point, we have supported the Year 6 News Club in creating an informative video, serving as an introduction to HPL at IBSB. This video will be shared with all newcomers, including students, parents, and staff, to familiarise them with HPL.
Furthermore, we will invite parents to participate in lessons once per term throughout the school, enabling them to observe how their children incorporate HPL’s VAAs & ACPs into each lesson. Finally, we plan to visit other World Class HPL Schools and in return will welcome them to our campus, fostering an exchange of knowledge and best practice.
The future shines brightly for us, as we continue together on our High Performance Learning journey.



Secondary School, A Year in Review
by Matt Tansley, Head of SecondaryAnd so we reach the end of another year at IBSB. It is hard to believe that I have now reached the end of my sixth year at the school. IBSB has changed immeasurably since I first arrived in the summer of 2017, as has the world! I still remember the old buildings by the gate, and the outdoor football pitch. There has been much in the way of development, not just in terms of buildings, although the dining room, sports hall, and multi-use games area are excellent editions, which I am not going to complain about! We have also invested heavily in resources for teaching and learning, with the introduction of adaptive AI, in the form of Century, and also Seneca. Both of these platforms have been fantastic in allowing the students to take charge of their own learning, and so we will be using them more and more as time goes on.
AI is going to form a big part of our lives over the coming years, and it is going to be important for us to learn how to use it wisely, as it will have a big impact on education, not just in saving teachers time, to allow us to focus on what is important, but the language models behind AI such as ChatGPT4 and Bard, will allow us to be able to talk to the characters in a novel, or scientists such as Isaac Newton and Albert Einstein, to see into their worlds, and their thoughts. This is exciting stuff!
Something else that is exciting is the news that we will be refurbishing our science classrooms, which will allow us to carry out more science experiments with younger students in KS3 and IGCSE classes. This has been a long-held aim of mine, and I am glad that we have been able to move forward with this, as part of our long-term development plan.
Since the last edition of the TIV was released, there have been many activities, events and successes to celebrate, in fact, too many to list here. In the sporting arena, we have had students participating in eventing and dressage, with Irina Gherghina, Iulia

Florea, and Teodora Albu experiencing success in events. Teodora has also demonstrated her abilities as a dancer, participating with her dance troupe, and placing 2nd and 3rd in two categories in a recent international competition. Victor Sandu has been crowned national champion for his age group, not only in the long jump, but also in the high jump too! Well done Victor! Our school teams have also performed well in a variety of events, ranging from the Lumina Cup and Coupe de Amite in football, to athletics meets against AISB and CSB
In other disciplines also, we have continued to have great success, including in debate, with our middle school debaters living up to the standards set by their older counterparts, by making the finals of every debate competition they have competed in this year, most recently at BSB, where they made to yet another final.
Our MUNers have also continued their string of successes, with best delegate awards and honourable mentions in all MUNs that they have participated in. I would like especially to thank Blessy Savu for her part in this.

We also have lots to celebrate regarding our graduates, as you will have seen in our newsletters. More students than ever before from our graduating class have been offered places by universities in the top 100 ranking universities around the world. A large part in this success is due to the quality of the teaching that they have received, as well as the support they get from their teachers, and also you as parents, and I thank everyone for that.
We have also had more trips and excursions going out this year than ever before: language trips to Niort and Paris for our French learners, a trip to Spain that has just headed off, and a trip to Germany on the calendar for the next academic year. We have had field trips to Cyprus, head off, courtesy of Aidan Ryan, a STEM trip is on the cards for early in the next academic year, to Cape Canaveral in Florida, USA! Exciting times at IBSB, and yet another trip goes out in Term1a to Greece.
Finally, I would like to thank the team. We continue to grow in size, with four new teaching positions being created for the new academic year, as well as replacements for those staff moving on. TO those moving on, Blessy Savu, Iona Tanguay, David Vincent, and Luis Mujica, I would like to thank you on behalf of the entire school community for everything they have done, and to wish you well on the next stage of your journey. You will be missed!
The British Romanian Chamber of Commerce is the premier business -led organisation promoting bilateral trade and investment between the United Kingdom and Romania. Our mission is to facilitate and increase the trade between those two countries through business-to-business dialogue.
The British Romanian Chamber of Commerce plays an influential role in creating and sustaining an environment in which free-trade and investment flourishes. Through the facilitation of partnerships, and with an extensive network of influential corporate a nd individual members, the British Romanian Chamber of Commerce provides the resource, knowledge and infrastructure support vita l to UK companies to make the most of emerging opportunities in Romania, and for Romanian companies to do business in the establis hed markets of the UK.
Established in 1998, the BRCC is an independent organisation, owned entirely by its members, with offices in London, Bucharest, Cluj and Sibiu.

How do we ensure our students are making satisfactory progress?
by Matt Tansley, Head of SecondaryThis is a question that teachers and school leaders ask themselves every day. Our role is to ensure that the students in our care are able to achieve their goals, and hopefully, these goals are aspirational. As you will have seen, our examination results and graduate destinations continue to improve year on year and have played a big part in us attaining HPL World Class School status, as well as achieving an overall ‘excellent’ rating in our BSO inspection with ISI. A big part of ensuring that these successes are attainable is enabling teachers and students to know how well they are doing, what they are capable of achieving, and what they could achieve with a little more effort through the tracking of performance, and this is where Alps comes in.
Alps is a platform that uses the prior achievement of students to predict what they could potentially achieve in their examinations if they are working to their full potential. It uses the data that has been accrued by thousands of schools in the UK and internationally over the past 25 years to identify a minimum expected grade (MEG) that could be achieved by the student. The platform Alps provides then allows teachers, and senior leaders in the school, to be able to see what would happen if students achieved higher grades than the MEG, or god forbid, lower grades. This is a sophisticated tool that helps teachers with their planning, but also allows conversations between teachers and students about what is possible.
How does the Alps culture of aspiration fit with IBSB?
As mentioned previously, IBSB is a HPL World Class School, delivering the Curriculum of England within the HPL framework. For those of you reading this article not yet familiar with HPL (High Performance Learning), HPL is a research-based pedagogy that holds true to the belief that all students have the potential to be

high performing. The HPL framework aims to equip students with the Values, Attitudes, Attributes, and Advanced Cognitive Abilities of successful lifelong learners. As a school striving to continuously improve, the decision was made to utilise the HPL framework to give structure to the maintenance of the growth mindset we had been working to develop at IBSB leading up to the adoption of the HPL framework. At IBSB, we believe that all pupils have the ability to perform and achieve at the highest levels. Using Alps to generate the data and the targets, and track the progress that students are making, allows this aspiration in many cases to become reality.
Using Alps in an international school setting
I was introduced to Alps initially through a conversation with our Head of School, Kendall Peet, who had been doing some research into other top schools going through the process of becoming HPL schools. Kendall had been in contact with the now former head teacher at Jumeirah College in Dubai, Simon O’Connor, and had set up an online meeting to discuss the impact that Alps had had on his setting in the UAE. It was an extremely positive meeting that left us both feeling that Alps would be a useful diagnostic tool to help measure student progress and attainment across the subjects within an international context.

One of the issues that we often have in an international setting is the availability of prior attainment data that you would have in a UK school, such as KS2 SATS data or FFT data. The ability to use GL assessment CAT4 data in the Alps platform, Connect, to generate a minimum expected grade (MEG) for a student in year 10, that will act as a target that progress can be measured against, was a game changer as far as we were concerned as a school. This allowed us to demonstrate to pupils, parents, and teachers exactly what the minimum expectations could be for a student and, extrapolating forward, for a class of students in a particular subject. From this, more aspirational targets could then be negotiated.
How do we use Alps at the International British School of Bucharest?
At IBSB, all pupils in years 7, 10, and 12 take the CAT4 assessment from GL assessment. In years 7 to 9, this CAT4 data is used to generate a target grade in every subject. When pupils move into KS4 the CAT4 assessment is taken again and the CAT4 data is then uploaded to Alps, where a Minimum Expected Grade (MEG) is generated. This MEG is aspirational and is based upon the CAT4. Teachers use the data from previous years, along with conversations with the student to set an aspirational, personalised target (PT) which is reviewed regularly.
In KS5, the results obtained at IGCSE/GCSE are used to generate a point score, which then generates the MEG for A Level. Again, conversations take place between students and teachers regarding personalised targets, and these targets are regularly reviewed over the course of the two years to ensure that they remain aspirational and relevant.
How does Alps help teachers and students?
Alps has been invaluable in allowing staff to be able to track pupil progress within their subject areas and to support middle leaders and senior leaders in identifying areas of strength and areas for development within subject areas, and within the school as a whole. As an HPL World Class School, our philosophy is that “all pupils are capable of high performance” and Alps, and in particular Connect, allows all staff at IBSB to be able to use the data that has been generated to help inform classroom assessment and report writing, to better understand how pupils are progressing, not just in one subject, but in all subjects taken.
Senior leaders are able to use Connect to set targets for middle leaders related to subject T scores, with departments being set the challenging target of achieving Alps scores of 1 to 3.


An Alps score of 1 means we are achieving the top performance in terms of pupil progress in the Alps benchmark, a score of 2 means we are performing within the top 10% of schools in regard to value added progress, and a score of 3 means we are performing within the top 25% against the Alps benchmarks.
Middle leaders are then able to have similar conversations with subject teachers relating to the T scores for the class, and the progress that individual students are making toward their aspirational targets, identifying the need for intervention support to measure the impact that can be had through intervention with students who are working below the targets set.
This reporting data is also used by the KS4 and KS5 Coordinators, cross-referenced with GL PASS data to see how pupils are feeling about school and the possible impact on their progress, looking at the bigger picture.
Now, three years in, I can say with a high degree of confidence that staff feedback has been universally positive in regard to the ease of use and simplicity of Connect, especially the thermometer!
Impact of Alps
Since IBSB began using Alps in 2020, an average T score of 1 has been maintained at AS Level (Year 12) across all subjects for each year that IBSB has been using Alps, with the average T score the Year 13 A Level programme continually improving, with many subjects now also in the red zone (1-3). The goal in the new school development plan is to ensure that all subjects at all levels are in the red zone.
Obviously, the grades achieved by the students cannot be attributed to Alps, but the ability to identify students who are underachieving, leading to a conversation between colleagues and also between students and teachers is invaluable. Alps keeps students and teachers honest and develops increased accountability, feeding into conversations related to whole school development, allowing schools to continually work to improve, which is true high-performance learning in action.



My journey into rhythmic gymnastics
by Teodora Albu (Year 8)Hello, my name is Teodora Albu and this is my journey in rhythmic gymnastics.
Firstly, I would like to tell you how I found out about gymnastics. This sport wasn’t something I discovered on my own. I was introduced to it by a friend who was already practicing for a couple of months. She often spoke about her experience and told me how much fun they have, but also how they much of an effort they put in in the hope of achieving the level they were dreaming of.
One day my mother, my friend, and I went to the mountains. It was then that I came up with this great plan of going away for the weekend, but my friend had to cancel due to having gymnastics practice. She then kind of talked me into going to one of her practice lessons and that was it, I was hooked. Even though everything was new to me- the teachers, kids, equipment- I somehow got over that and slowly got to know everybody and therefore became more comfortable. From the first lessons I joined, I was honestly in love with this sport.
How did rhythmic gymnastics change my life?
First of all, due to the pandemic, I had to quit doing all the group sports I used to practice together with my older sister. I have always followed her steps in sport with swimming, cycling, or athletics. However, after the pandemic I wanted to try something of my own, but was not sure I could achieve the level I wanted with a sport other than the ones I was already doing. I had to start from the beginning, and that was scary. That was when I tried gymnastics. It’s a decision that has actually changed my life in a really good way.


I am now happy to say that I am working really hard to succeed in gymnastics competitions, together with my teammates. As a matter of fact, in May we went to our first world championship in Croatia, where we achieved 2nd place with the ‘Matrix’ dance and 3rd place with ‘Kalinka’.
Why I recommend rhythmic gymnastics
Rhythmic gymnastics is a great sport that helps you improve your flexibility, balance, agility, coordination and dancing skills. You create a great friendship bond between you and your teammates. Rhythmic gymnastics also teaches commitment, dedication, and builds confidence and self-esteem and lastly, develops good posture and confident body movement for sport and life.



Of course, there could be various risks, but this is something you as a dancer are ready and prepared to encounter during the journey of being a Rhythmic gymnast.
How would someone start doing rhythmic gymnastics?
If you want to be a rhythmic gymnast, you’ll need to dedicate yourself to practicing. Flexibility is also crucial in rhythmic gymnast to prevent injury. You’ll need the motivation and possibly even courage to join a rhythmic gymnastics club in your area. Finally, you’ll need to maintain a balanced diet and be ready to have to sacrifice a lot of your free time in order to train. But as I said, it is great way to make new friends and improve as a person, so it is totally worth it!


A message from your PTF President
by Janitha Jayathas, PTF PresidentDear IBSB Community,
I am delighted to say that 2022-23 was a very good year for the PTF with a number of new initiatives successfully introduced and many projects implemented with your support. Reflecting back upon our wonderful school year shared, which for me personally was notable as my first year as your PTF President, there is clearly much that we can celebrate and be proud of looking at the many achievements of our children, but also as the many contributions made by the PTF.
Our involvement and organisation of various events, alongside our productive interactions with the school leadership, have added value in a number of ways across the curriculum and throughout the school year
Than you to everyone for your generous donations to the PTF at the start of the school year, which enabled us to support the following events:
1. Morning Tea for the teachers on Teachers’ Day (October 05)
2. Fruit for the annual IBSB Sports Day (October 07)
3. Carturesti gift vouchers were given for the Halloween contest (October 31)
4. An Advent Calendar was prepared for Christmas (December 2022).
5. All the children received chocolates for St. Nicholas’ Day (December 06)
6. Numerous events were organised during the Christmas season, including a photo booth for the Secondary School Winter Ball (December 08)
7. Martisor Photo booth for the Primary School and Martisor gifts to the female staff (March 01)

8. Women’s Day Photo booth for the Secondary School and Flowers for the female staff (March 08)
9. Summer Show Photo booth
In addition to these events, the PTF also donated 1000 euros to the school library. The school matched our donation, as is the tradition, meaning we add 2000 euros worth of new books to the school library’s collection for the reading pleasure of our children, which our children used to select books they are interested in reading. This is wonderful news for the students, as they now have a much larger collection of fiction and non-fiction books to borrow and read.

As a new initiative, starting September 2022, the PTF has been meeting each Thursday from 8.30am at the weekly PTF Coffee Morning. This informal gathering allows parents from across the school in both primary and secondary to drop in for a coffee or tea, to meet and speak members of the PTF and with other parents, to chat about their kids’ school life and simply enjoy each other’s company. The event is frequently attended by the Heads of School, Alan Cornish, Mathew Tansley, and Kendell Peet, and once a month is host to a Parents’ Workshop, usually led by Delia Ciobanu or Cristina Latcu, the school Student Counsellors, on topics relating to raising our children to be healthy, confident, and successful, such as ‘Parenting Styles’, ‘Internet Safety’ and ‘Childhood eating disorders’. The workshops in general were well attended and are scheduled to continue in the new academic year 2023 –24.
When I initially assumed this role, I was quite tentative about the responsibilities I would have to assume. Thankfully, the role has been much less daunting that I first imagined and richly rewarding and satisfying on a number of levels.


I am particularly fortunate to be supported by a beautiful group of ladies, without whom the PTF could not function the way it does. I would like therefore to take a moment to express my sincere gratitude to Madalina Albu (Vice President), Iulia Pietruschevici (Treasurer), Giuliana Bianchi (Social Media Coordinator), Marie Torres and Ramona Volciuc for their tireless work behind the scenes, ensuring the smooth organisation of the events sponsored by the PTF.
Furthermore, I am grateful to Kendall Peet, Alan Cornish, and Matt Tansley, who always make time to attend the PTF meetings and offer support wherever and whenever needed.
Finally, a big thank you to the parents of the IBSB Community, because it is through your contributions that the PTF can support all of these events, working more successfully to bring the community closer together, adding value to the lives of our children.
I eagerly look forward to the upcoming academic year in anticipation of the fruitful interactions between parents as we work together to further strengthen our PTF Community.



Lumina Cup 2023: An Important Building Block to Future Success

On the 12th and 13th of May, our young football talents took to the field for the exhilarating Lumina Cup tournament. With the U9 and U11 boys’ teams competing fiercely, this edition of the Lumina Cup showcased determination, sportsmanship, and the unwavering spirit of the participants. Let’s delve into the highlights and the invaluable lessons learned during this thrilling football event.
U9 Category: A Display of Tenacity and Effort
In the U9 category, our talented team gave their all, but faced tough challenges throughout the group stage. Despite their best efforts, they were unable to progress beyond the group stage. However, their commitment and perseverance were commendable as they left everything on the field, playing with passion and dedication in every match. Their performance serves as a testament to their potential and provides a solid foundation for future tournaments.

U11 Category: Battling Against Formidable Opponents
The U11 category also witnessed intense battles against some of the most formidable teams in the tournament. Our team, however, showcased exceptional skill and determination in every game, leaving no stone unturned in their pursuit of victory. Although they faced tough opponents, they never backed down, displaying incredible sportsmanship and teamwork on the field.
Despite their exceptional effort, the U11 team narrowly missed out on clinching the title in this edition of the Lumina Cup. Their performance was in every way a true reflection of their dedication and resilience. They faced each match with unwavering spirit, giving their best and pushing their limits. The experience gained from this tournament will undoubtedly fuel their motivation to strive for even greater success in the future.
An Invaluable Learning Experience
Participating in the Lumina Cup was not only an opportunity to compete, but also a valuable learning experience for all our young players. The challenges faced on the field will no doubt serve as steppingstones for growth, emphasizing the importance of hard work, perseverance, and a positive attitude. Each match provided invaluable lessons, instilling in the players a deeper understanding of the game and fostering their love for football.
The Joy of the Game and Determination for the Future
While the Lumina Cup 2023 may not have resulted in ultimate victory for our teams, it served as a platform for the players to embrace the joy of the game. The camaraderie and team spirit displayed throughout the tournament created a bond among the players that will endure beyond the field. They emerged from the competition with newfound determination, vowing to build upon their skills and evidencing their progress in preparation for the next edition of the Lumina Cup.
Looking Ahead
As the Lumina Cup drew to a close, the memories and lessons learned will remain etched in the hearts of the participants. The dedication, sportsmanship, and unwavering effort demonstrated by our U9 and U11 teams serve as an inspiration for future generations of young footballers. We congratulate all the teams who participated in this remarkable tournament this year and eagerly anticipate the next edition of the Lumina Cup, where our players will continue to progress toward their goals, knowing that victory so often rises from the jaws of defeat and the valuable lessons learnt along the way.

Interschool Athletics Grand Prix
by Alexandru Lacraru, PE TeacherOn Wednesday, the 29th of March 2023, 6 boys and 6 senior school girls from IBSB were invited to participate in the annual interschool Grand Prix athletics competition. Selections were held and the team assembly by Ciprian Iacob and Alex Lacraru, our Secondary School PE teachers, and headed Sala Atletism “Gabriela Szabo” Voluntari ready to participate in the following events, divided into 4 age group categories:
Here are the results:
60m Girls:
Daianu Iulia – Bronze (2010-2011)
Eva Wahler - Gold (2010-2011)
Alina Barbu - Bronze (2004-2005)
60m Boys:
Farcas David – Bronze (2010-2011)
Roman Tiderle – Bronze (2008-2009)
Federico Russo – Bronze (2004-2005)
200m Girls:
Eva Wahler - Bronze (2010-2011)
Daianu Iulia – Silver (2010-2011)
200m Boys:
Farcas David – Bronze (2010-2011)
400m Girls:
Alina Barbu -Gold (2004-2005)
Eva Wahler - Bronze (2004-2005)*
Badelita Sarmiza – Bronze (2006-2007)
400m Boys:
Federico Russo – Bronze (2004-2005)
Horia Nitu - Bronze (2006-2007)
800m Boys:
Farcas David – Gold (2010-2011)
Pietruschevici Balan Luca – Silver (2010-2011)
1500m Boys:
Horia Nitu - Silver (2006-2007)
Aizic Theodor – Bronze (2006-2007)
Relay (mix):
4x200m Middle School- Bronze (Radu Nica/Roman Tiderle/ Wahler Eva/Daianu Iulia)
4x200m High School -Bronze ( Bogdan Nenita/ Horia Nitu/ Alina Barbu/Alexia Verdes)
Congratulations to all the students who took part and a big thank you to Cirpain Iacob and Alex Lucraru for supporting the students to achieve such an excellent set of results.






U13 Boys Secure 3rd Place in Lumina Cup
by Luca and Dinu Pietruschevici Balan (Year 7)
On Saturday the 28th of May, IBSB’s U13 boys football team arrived at the Lumina Football Cup tournament with high hopes of bringing home a trophy, which they achieved securing 3rd place in very competitive draw.
Our first match in the group round was against BSB, resulting in 5-0 win to IBSB. The next match against Lycée Français was a little tougher, but still resulted a 2-0 win for IBSB. Having already qualified for the next round, we next played the European School of Bucharest (SEB) to decide draw for the next round, starting confidently as we had not yet conceded a goal in the tournament. At half time we were 2-0 up, but then conceded a goal from a penalty. As the last few minutes approached, we worked hard to secure our advantage, with Deniz curling the ball beautifully into the top left of the goal from a corner kick. 3 games 3 wins! A perfect start to the tournament!


As group winners, we felt we were in a strong position to play the second placed team in group A: Aletheea. The first half finished goalless. Sadly, our strategy was not working and we were not able to pass with the same level of confidence from the early games; anxiety was taking its toll on us. Soon a mistake came, and we conceded from a direct free kick. Everybody seemed to lose concentration as winds of fortune seemed to favour of Aletheea, with a slip-up in our back line in the second half enabling Aleethea to score again. The fate of the match was sealed, 2-0 AletheeaIBSB. We were disappointed, knowing we could have played a much better second half. Team morale was lower than the Mariana trench. A third-place play-off was our only salvation.
After the second semi-final was played, we found out we would be playing against SEB - the very same team we had beaten 3-1 in the group stage. Confidence was building- we had a few ideas about what we were going to do and were ready to make the choices needed to win the 3rd Place cup.
Kicking off the match, we were able to quickly secure possession to get a few good shots at their goa and soon after mounted a clinical counter attack, scoring a goal to make it 1-0 for us. Pass after pass, our game was running smoothly, placing SEB under constant pressure, eventually converting that pressure into a second goal: a mistake from their defenders allowed us to make it 2-0 to IBSB. A few minutes later, the half-time whistle blew. Our team’s hopes were extremely high, but our coach, Mr Ciprian, reminded us that the game was not over. We returned to pitch determined to find the back of SEB’s net a third time, eventually holding our 3-0 lead to secure 3rd Place in the 2022 Lumina Cup!
Thank you our coach Mr Ciprian for his constant support before and during the competition and huge well done to everyone in the team! A huge improvement on our result last year!


Paul Georgescu Swims Strait of Gibraltar
by Kendall Peet, Head of SchoolCongratulations to our Primary School PE Teacher, Paul Georgescu, for once again swimming into the history books, becoming the first Romanian to successfully swim the Strait of Gibraltar without a protective suit. Paul Made the crossing on June 11, swimming a total of 14.4km in a time of 3 hours and 46 minutes.
This was the 5th channel crossing in Paul’s Ocean’s Seven Challenge, having already successfully completed the English Channel in 2016 (54km, 13hours36min, between England and France), the Catalina Channel crossing in 2019 (54km, 10hours25min, from Los Angeles to Catalina Island), the Molokai Channel in 2019 (55km, 13hours6min, in Hawaii), and the Nordic Channel in 2023 (34.7km, 11hours7min, between Ireland and Scotland).
Paul’s final two swims to complete the Oceans Seven Challenge are the Tsuguru Strait (Japan) and Cook Strait (North Island to South Island, New Zealand), in 2024
To date, only 22 swimmers from around the world have managed to complete the Oceans 7 Challenge, so Paul will be joining a very elite group of swimmers, and was himself named World Open Water Swimmer of the Year in 2021, having completed the Triple Crown and setting a new world record for swimming the ice mile, as well and the ice mile world record in the Antarctic Polar Circle. He also established the 7 Lakes Challenge here in Romania.
Well done Paul! You are an inspiration to the IBSB community and wonderful representative for Romania.
We look forward to celebrating your next two swims as you work to complete the Oceans 7 Challenge in 2024.








MFL Spanish Art Safari
by Carmen Raducanu, Spanish TeacherAt IBSB, we firmly believe in the value of learning beyond the classroom walls to stimulate curiosity and inquiry in direct physical contact with the things student study across the curriculum.
With this in mind, the the studnet sin K3 and 4 accompanied by Ms Carmen, our Spanish teacher, planned a trip to the Art Safari Gallery Week in Bucharest, to celebrate Cervantes Day by learning about the wonders of Spanish art history through the collection called “The masters of the Spanish painting, 19th century and the beginning of Impressionsm”.
On the trip, our students were introduced to one of the best pieces of art belonging to Joaquín Sorolla, Federico and Raymundo de Madrazo, aswell as by the Romanian painter Ion Teodorecu Sion. The two most famous paintings “Ecce Homo” by Tiziano Vecellio and “Man in the Blue Chaperon” by Jan Van Eich were without a doubt the shows’ highlights.
Following their visit to the museum, the students then enjoyed lunch in downtown Bucharest. Whilst waiting for their meal to be served, they had to work in teams to complete a short quiz, answering questions related to their Art Safari visit in order to obtain an additional dessert. Fortunately, there was a draw in the contest, and everyone received some delicious ice cream as a prize.







DIAMUN 2023
by Maria Timbolschi Preoteasa (Year 11)I March 22 students, myself included, were accompanied by Ms Blessy, Mr Ennion, and Ms Tanguay on a trip to Dubai to participate in the 15th annual edition of DIAMUN, hosted by Dubai International Academy. As Mr Peet mentioned in a Term 2 edition of the weekly newsletter, and as was showcased in a presentation in a secondary school assembly, we walked away with 3 Best Delegate awards and an experience that will last for a lifetime.
What is MUN?
Model United Nations, or MUN for short, is essentially exactly what the name suggests: a reflection of the way the real United Nations functions, modelled in a way for middle and high school students to understand, participate in, and get a feel for how the real United Nations works.
Students from a school are called a delegation from said school representing said country. They are then given a choice of committees they would like to take part in, and choose which one they wish to partake in. IN some cases they choose their committees first and then are assigned countries to represent and act as that nation’s delegate in that specific committee in the ensuing debate on one or multiple topics throughout the days of the conference. The aim is to reach a consensus on the current issues plaguing our world and then combine solutions into a resolution, which is voted on and, hopefully, passes.
How does MUN benefit students?
MUN teaches students multiple crucial skills which can help them obtain an edge. These skills involve public speaking, negotiation, conflict resolution, and networking. As delegates are required to give speeches, they develop the ability, confidence, and charisma to speak in front of an audience on a given topic. These skills will go a long way in the future, especially if they plan on working in a corporate, political, economic, or social studies-based environment. Negotiation is a critical skill based that will help them to navigate multiple situations in their future lives, and hopefully, they can come out on top
Lastly, networking is one of the most, if not THE most essential skills obtained from MUN. MUN presents the unique opportunity to meet multiple new people from different cultures and backgrounds. Staying in contact with them can help students in the future. After all, you never know where you will end up in the future or where other people will, and you may end up benefiting from those connections you made.
Summary of the trip
Our trip started on March 1st when we all gathered at the airport for the flight to Dubai. It was great to see the enthusiasm on everyone’s faces. Even though most of the group was going to their first MUN, confidence was high and the motivation to do well was evident.
We arrived at 9pm local time and spent most of the next day finalising our preparations with some occasional leisure sprinkled in as well. The weather was almost perfect as well, rarely reaching above 30 degrees celsius during the day and around 20 degrees during the nights
At 6pm we arrived at Dubai International Academy for the opening ceremony. To be honest, it felt like I was watching the opening ceremony for the FIFA World Cup all over again as there were musical and dance numbers alongside speeches by guests like His Excellency Abdulla Al Awar, CEO of the Dubai knowledge fund establishment, and Mr Giueseppe Finochhiaro, Consul General of Italy in Dubai.
The next day we were all ready and eager for the conference to start. Everyone went off to their committees and started debating, negotiating alliances, writing resolutions, and meeting new people. I’m proud to say that over those three days, our group performed admirably, and was always among the most active, engaged, and enthusiastic people present. We all created many wonderful memories and shared some great moments. Tempers flared occasionally, but in the end, it didn’t affect our enjoyment and experience.

Some of the highlightsfrom the MUN include Poland annexing half the world in UNESCO, the USA getting taken out of GA3 while Russia and Ukraine were duking it out, one of the blocs being named “The Steaua alliance”, Russia getting kicked out of UNEP, 3 times, and taking the flag with him, guest appearances from Joe Biden and Vladimir Putin and a celebration dubbed “The Balkan Ronaldo”. I could go on, but that would take up too much of the article. The point is that many wonderful moments were experienced and they will remain with us forever.
In the end, we walked away with 3 best delegate awards. Congratulations to Maria and Haidar for their great effort. I would also like to thank everyone who has congratulated me on winning Best Delegate in GA3. But in the end, it is not about the awards, it’s about the great things experienced. The delegation from IBSB was widely lauded and praised for being some of the friendliest, easy going, and sociable people, and that is truly something special.
Cultural and Diversity Celebration
This edition of DIAMUN was the 15th conference, with over 500 people attending from over 40 different schools from multiple countries. Whether they were from within the UAE itself, from nearby countries such as Egypt and Saudi Arabia, from Europe like us, or even from places as far away as Singapore and Congo. This has truly been a unique experience and an opportunity to interact with people from all over the world. It has built an appreciation of the diversity for the wide array of cultures throughout our world. Seeing so many people of diverse backgrounds, faiths, and interests coming together is a true statement of global unity and appreciation for one another. I can say with certainty that if it wasn’t for MUN, I wouldn’t have met and made great friends with people from different cultures. All of us had a great time socialising and finding out the many things we have in common during our breaks and during the Social, Event hosted at the JW Marriott. I can’t express how grateful I am that we still keep in touch with the friends we all made at DIAMUN 2023.
This conference was my fifth conference and my first international one. I think I can say that this was the best conference I have attended to date. Sadly, it has ended, but it was certainly an experience that I will never forget and will cherish forever.
I would like thank Dr Blessy Savu for making this trip possible for us and for helping prepare our team of delegates. I would also like to thank Mr Enionn and Ms Tanguay for accompanying us and sharing some funny moments with us. A big thank you also to the school office for sorting out all necessary paperwork and other admin essentials.
On the off chance that somehow my friends made during the conference end up reading this article, I’d like to thank you all, once again, so much for making this an unforgettable experience. I’m sure we will all meet again.
And I’d like to thank all of the guys who were a part of the delegation from IBSB at DIAMUN 2023. You guys are truly a credit to the school, and most importantly to yourselves. I’ll now share a few thoughts and feelings they had to say:
“Great experience probably the most useful I have done all year 100% recommend” - George Vernon Y8B
“It was an amazing opportunity and it was super fun, not just the conference, but during free time and the social too” - Maia Bucura Y8B
“We met so many amazing people and learned so much over the three days, I am looking forward to the next MUN for sure” - Sonia Marta Y10E
“I’m glad I managed to get some Instagram and snapchat accounts because I still keep in contact with some students from there” - Ilana Costache Y10E
“Great people, very friendly, no enemies made” - Sever Y9V
“The trip was super fun and I made lots of new friends as the community was so friendly and open, we made so many jokes and it was all around a great experience” - Andrada Y11P

DUBAI MUN DIARY: DAY 1 Session
by Maria Timbolschi Preoteasa (Year 11)Friday, March 03, 2023
Today was the first day of the conference, and the shaded courtyard was abuzz with delegates and directors. Some 50 Schools from across the globe were gathered to take part - from as far away as Tanzania and the Democratic Republic of Congo, joined by our Romanian team and the many local schools to discuss key issues surrounding the theme of the event: “Collaborating to foster sustainable development”.
The students dispersed into their various committees and councils to present their opening speeches and position papers before the break, when Iulia and Simon were still involved in discussing one of the early resolutions, Maia and Andrada were involved in a committee to counter the effects of natural disasters, and George was involved in a discussion about conserving culturally important sites across the world. Meanwhile, Clara and Vlad were seeking allies to further their respective purposes.
A very promising first day had by all!





DUBAI MUN 2023 – Best Delegate Awards
Collaborating to foster sustainable development
Congratulations to all the students who attended the recent DUBAI MUN, with special mention of the following IBSB students as recipients of the Best Delegate Award. In total there were 10 Best Delegate Awards given out to students from the 50 attending schools, with 3 of the awards going to students from IBSB – an incredible achievement that would not have been possible without the support and commitment of our MUN Club Coordinator, Dr Blessy Savu. Well done to everyone!
Award recipients:
Maria Timbolschi Preoteasa - Best Delegate Award

Vlad Nedelcu - Best Delegate Award

Haidar Mrad - Best Delegate Award


Niort and Paris
by Sara Scarletescu (Year 9) & Horia Nitu (Year 10)The trip to France was a miraculous experience. We had some problems with the hotel and the restaurant on the first night. The restaurant was not very welcoming, but the fact that we were all there and that we made the evening more beautiful together made me realize that a simple fast-food restaurant cannot stop us from having fun.
We were lucky that we could change the hotel after the first evening and from the city center we arrived right at its edge. The rooms were a little cramped, but everything was ok. We also had breakfast at that hotel and dinner.
In the first three days I had three hours of French each. After each French class, we ate lunch and then went to visit. We were also in the center at a fairly old fortress and we had some time for shopping. In a day we went to an art museum and also, to an ecological and historical museum.
One day we went to La Rochelle. It is a nice city at the seaside. We visited the aquarium. It was so nice to see many species of fish, jellyfish and other live creatures. After the aquarium, we had a walk through the city center and enjoyed the empty streets and the shiny sun. All the restaurants were closed because the lunch menu starts between 12-13 (depends on the restaurant) so we ate at a caravan. The food we ordered was pretty good and we also had some very good and long churros :))).
In Paris we started visiting immediately we arrived there. The Eiffel Tower was the first on the list. We had the opportunity to go up to the second floor on the stairs. The view was awesome. After taking some pictures we went on the Champs-Élysées. The famous boulevard in France. Many stores had long queues. I couldn’t stay at them because I had other places to visit. We also passed by the Arc de Triomphe at the end of the boulevard. The next day we chose to go to the Louvre museum. We had the opportunity to see the Mona Lisa portrait up close. We didn’t have enough time to visit everything, but we got to the parts that interested us more. Such as, ancient Egypt, ancient Greece and some scenes from the Renaissance period.

After the museum, we passed by the Obelisk where I took a break to find out information about it. And in the evening, we had a walk on the Seine where it was very nice to see a piece of Paris from the water. And finally, on the last day, I went shopping again at the Lafayette galleries. The time was limited, of course, because afterwards we arrived at the airport to go back to Bucharest. Overall feedback about the trip, I would say that I loved it and we had a good time together. I will be the first one to sign up next time on a trip with Miss Dana and Miss Carmen, of course.
Sara Scarlatescu, Year 9
I appreciate a lot of things we did on this trip. The fact that we visited the Eiffel Tower, Louvre Museum, Champs Elysées, the cruise on the Seine River, The Tuileries Garden and the most important the Lafayette Galleries. I also enjoyed the lessons and I also want to thank Miss Dana and miss Carmen for laughing at my jokes. I am glad I spent such an amazing week in France that I surely won’t forget. Just for you to know, I did not forget about La Rochelle and the aquarium.
The only thing I did not enjoy about this trip was the fact that I wished to stay a bit longer in Paris. And perhaps going to a restaurant to eat Fondue.
A piece of advice for someone going on a school trip: I would personally suggest for kids to bring an extra phone or a laptop in order to use it at night after the teachers take yours. And also, never be late when turning your phone in. Thanks for this amazing opportunity to miss a week of school, but also to see France.
Horia Nitu, Year 10





Seminar in Goethe Institute about the book and movie “When Hitler Stole Pink Rabbit”
by Alex Serban (IBSB Alumni 2020)Year 11 and a former student (currently studying in Vienna, Alex Serban) went to Goethe Institute to take part in a seminar about the anti-semitism presented in the book Als Hitler das rosa Kaninchen Stahl (When Hitler Stole Pink Rabbit) by Judith Kerr.
The book takes place around the 1930s, around the time Hitler started rising to power, and follows the story of a jewish, 9 year old girl named Anna as her and her family attempt to flee from Germany. The book showcases the struggles and difficulties the family experienced as they had to relocate and leave their old lives behind (such as learning new languages and adapting to different cultures and environments) as well as gives some insight into the innocent view Anna, a very young child, had on the dangerous situation herself and her family found themselves in (commonly throughout the book Anna, expressed she saw this ‘journey’ as a fun adventure).
The seminar was split into 3 parts; The first one consisted of a brief introduction and general discussion on anti-semitism (which included analyzing German propaganda and the intentions behind it) held by the director of Goethe Institute, Dr. Joachim Umlauf. The second one was an open discussion about the book, its themes and how it links to anti-semitism lead by two young German practicants, Pauline and Luka and the last part consisted of a group activity in which we were split into 3 groups and had to do a short project and presentation on either the way Anna and her family were presented in the book, the events that were happening around the time Anna and her family fled from Germany or the journey Anna and her family had to undergo. We had studied this book during our German lessons and we are happy to have made a great impression in Goethe Institute.



Visit to Goethe Institute Library
by Ioana Anghel, German TeacherOur motivated and hardworking German students from year 7 and 8 were invited to the Library of Goethe Institute, where they had the chance to explore the various and adapted resources for children. The students were excited to try the wide range of games they could find in the library and they borrowed Mangas in German. Some students were so keen on and looking forward to reading the Mangas, that they finished in a few days. We would like to say thank you to Miss Cristina, the librarian, who welcomed us so kindly and explained to us with so much patience what we can find in the library. It was interesting to find in the library a collection of useful objects that people can borrow, use and bring back which is aiming to encourage a sustainable lifestyle.
We are very grateful to Goethe Institute for offering us a free subscription and for ordering for the library the resources that we need for our learning.




KS4 British Biology Challenge
by Rares Stanciu (Year 10)The KS4 British Biology Challenge was a competition held between the 3rd and 19th of May, it consisted of two papers taken by over 43,000 students across 621 schools. 19 students from both years 11 and 12 took part in the competition with a large proportion achieving great results and a few even managing to get the Gold award.
The two papers consisted of knowledge learned in the IGCSE curriculum plus knowledge students gathered from documentaries, magazines/ books and articles outside school in order to test the students’ passion and interest in biology. More than a test it was a way to challenge the students, encourage them to achieve highly and build interest in the subject. Being a competition, participation was voluntary giving students the choice to challenge themselves or not. This ensured that only those the most interested in biology took part, while avoiding an excessive burden or those with different interests. The grade boundaries were organised by the percentage of people in each section with the top 5% getting gold, the top 10% getting silver, and the top 15% getting bronze, going all the way down to commended. Tommaso Bianchi, Rares Stanciu, Malin Bololoi, Ana Nanau, and Alessia Grozea got the Gold award. Following them, achieving the silver award were the following students, Sarmiza Badelita, Andrei Stoenescu, Theodor Aizic, Anushka Laha and Alexandru Oltean. Making their way in third place were, Maria Yang, David Cernea, Augadh Aurora, Ana Branescu, Nina Culea, Anastasia Tarnovet and Titi Lin got bronze.


EUSDC Space Competition
by Science Department Secondary School
On Saturday, the 10th of December 2022, 4 IBSB students, Sarmiza Badelita, Rares Stanciu, Andrei Stoenescu and Tudor Georgescu, went to ICHB to take part in a STEM competition. This competition is known as RoSDC and it’s a competition which usually takes place in the UK but some students managed to bring this competition to Romania. So this is the first time the Space Design Challenge took place in Romania. Students from high schools around Bucharest competed against each other in teams of 25 each. After spending 10 hours of continuous team effort to design a space settlement on the orbit of Mercury, the team containing the IBSB students won 1st place. This qualified them for the next stage which took place at an international level where they represented Romania.
Nearly 4 months later, on the 1st and 2nd of April, the European stage was held: Participants from a wide range of countries such as Portugal, Spain, Italy, and the United Kingdom all got together for the second stage where they were required to design a space settlement called Dias orbiting the sun at approximately 0.25 AU’s from the Sun, nearly halfway between Mercury and the Sun.

Teams were assigned with the IBSB students being grouped into Earhart. Other teams included Kepler, DaVinci. On the 1st of April, after a brief introduction to the project, the teams were delivered the Request for Proposal, the document containing all of the requirements and specifications expected to be provided in the final presentation. Besides he Request for Proposal students had to take in consideration all sorts of factors that could damage the settlement. The teams shortly proceeded to begin work at 11:30 AM (Saturday) worked until 15:00 the next day. After more than a day of working tirelessly with little sleep, the teams handed in their final presentations and soon after the presentations were given.
It was a tight competition for the teams with many bringing forth commendable presentations. Although in the end, only one team could win and after the judges debated for nearly an hour it was concluded and announced that Kepler Automations won and would proceed to travel to the Kennedy Space Center in Florida where the final competition would be held.


UK Olympiad KS4 Biology Challenge
by Dr Darren Laffar, Secondary School HPL CoordinatorUKBC have extensive experience in writing biology competitions for all ages of secondary school students.
Each year, they deliver three high quality competitions for over 60,000 students. They work closely with the Royal Society of Biology and University of Warwick to bring these competitions to as many students as possible.
• Over 25 years of experience
• 100% medal success at the IBO
• Three competitions for secondary school students
The Biology Challenge is open to students aged 13 to 15 years old. Questions will be set on the school curriculum, but the competition will also reward those students whose knowledge of the subject has been increased by reading books and magazines, watching natural history programmes, taking notice of the news media for items of biological interest, and are generally aware of our natural flora and fauna.

Over 43,685 students from 621 schools worldwide took part in this year’s competition. We are very proud, therefore, to announce that our BSB pupils were outstanding. Here are the results:
5 gold certificates (this puts them in the top 5%): Tommaso
Bianchi, Malin Bololoi, Rares Stanciu, Ana Nanau and Alessia Grozea
5 silver certificates: Theodor Aizic, Andrei Stoenescu, Sarmiza
Badelita, Anushka Laha, Alexandru Oltean
7 pupils bronze certificates: Heng Maria Yang, David Cernea, Augadh Arora, Ana Branescu, Nina Culea, Anastasia Tarnovetchi, ZuYa Emilia Jiang
2 pupils received a “commended” or “highly commended” certificate: Mara Mestecaneanu, Qichao Titi Lin
Well done to all those taking part, offering positive an example to the rest of the school.






The Tourism Project
by Jayne Baker, Year 9 Tourism Project CoordinatorThe Humanities Department six years ago created the Tourism Project. The reason behind it:
• Romanian children should understand Romanian history
• The landscape of Romania is so diverse - it needs to be celebrated more
• An introduction to Business Studies prior to learning it at IGCSE
• Romania is missing out on the incredible opportunities of having tourists - what could the students do to encourage tourism to the country.
The thinking behind this project is that it is student led. They decide their groups, their tour, the amount of work that they want to put into it, and the construction of their marketing materials. From a teacher’s perspective Ms Baker, Mr Ryan and Mr Hudson do very little. They each run one lesson on their subject, relating to Romania. The students spend the day in Sinaia, undertaking geography fieldwork and market research activities. The rest is down to the students. As teachers, we do not monitor their progress; we leave it to them - letting them know that they will be in front of a panel of external industry judges, their peers, and their parents, on the showcase day.
On that day, the students create their trade fair and welcome visitors and the judges, spending time informing them about their tourism proposal. This can be slightly nerve wracking for them - everyone is expected to present. They also find the day tiring - being organised prior to the event, bringing in their projects, displaying their projects as best they can, and talking to people for

nearly two hours. Of course, there are prizes for the winning project - but we hope that everyone feels that they have won, as they should have developed their independent learning skills - which will give them excellent skills for the future.
This is HPL at it’s finest! Thank you to Ms Baker and the Humanities Department for such a wonderful event!





IBSB 2023 Graduating Class
Congratulations to the Graduating Class of 2023.We are incredibly proud of all you have achieved in your time with us,and we wish you future success in your future studies and career.














Ciju Adriana


Iliescu Vlad


Musat Luca



Constantinescu Calin


Iordachescu Bostan Thea


Prajisteanu Anya


Verdes Alexia


Constantinescu Kyra


Iosiper Sara

Rosca Nichita


Vernon Andrei


Constantinescu Medeea


Koek Merel


Simion-Popescu Stefan Liviu


Voiculescu Andrei

Dobre Angela


Lin Zexuan (Alex)


Sticlea Maria


Wu Si-Cheng (Alexandru)


Gradinariu Antonia


Mikhael Mariam


Tansley Patrick


Xie Kaiwen



Head of Primary Message
by Alan Cornish, Head of PrimaryWelcome to the Primary School section of the Summer TIV, a place of creativity, achievement, and fun. Ms Orla O’Dwyer and our talented team of teachers and pupils have chosen the highlights from the past few months in Primary and created something special to share with you.
Summer term holds a special place in our hearts, particularly as it is followed by the summer holiday. But before that, we always manage to cram in many day trips, residential weeks, graduation, bake sales, competitions, GL assessment, House Games, the Summer Show, reports, and a lot of learning. We even had time to enjoy our very first Early Years Teddy Bear Picnic, which was such a success that we will do it again next year. Witnessing parents actively participating in events like this, reading to the kids in class and enjoying assemblies and shows, is the essence of primary school life.
As you peruse the memorable events captured in this issue of TIV, remember that none of them would have been possible without the invaluable contributions of our teachers. They created, organized, and coordinated these activities, ensuring they were not only educational, but also fun, safe, and infused with HPL competencies, such as creativity. We extend our heartfelt appreciation to our teaching team, who have once again demonstrated their dedication, energy, and imagination throughout the year.
Looking ahead, there is much to anticipate next year, working together to achieve even greater heights of success.


Early Years Outdoor Education
by Madalina Soare & Deborah Ferguson, EYFS TeachersAlthough the weather has been temperamental, that hasn’t stopped us from getting outside for our final topic “What if I could only learn outside?”
We’ve enjoyed exploring colour in the garden by using colour charts and matching as many colours as possible. Some of us have used nature to create our own pictures, soups, stick wands, and ladybug houses. We have been trying to remember the most important rule – plants and trees are alive. If the leaves are on the ground, then we can pick them up. We are still working on this…
We even managed to celebrate a birthday outside. It made the cake even tastier.

We didn’t just stay in school. We went on trips too. We went on a treasure hunt and followed a map that led us all the way to the fruit shop. “What was the treasure?”, we hear you ask. It was big, red, juicy strawberries. Delicious!
Since we behaved so well, we went to Ferma Animalelor. Obviously, we enjoyed seeing the animals, but we really loved the big, bouncy trampoline, and even Ms Deborah got on to bounce around. We then went to Parc IOR to try some fresh activities: we measured trees, spotted some clouds, had fun making nature rubbings, and finished it all off with the parachute.
Now, we’re



Year 1 Students Embrace the Magic of Nature
A Journey into the World of Plants
by Victoria Fay, Year 1 TeacherIn the vibrant and lively classrooms of Year 1, a group of young explorers embarked on an incredible adventure—a journey into the enchanting world of plants. With boundless enthusiasm, these budding botanists dove headfirst into the captivating realm of flora, discovering the needs, parts, and functions of these marvelous living organisms.
One sunny afternoon, the classroom buzzed with excitement as the children prepared to plant their very own bean seeds. Armed only with eager hands, and beaming smiles, they took charge of this hands-on experience. With careful guidance, they learned the delicate art of planting a seed and what they would need to do to nurture it into a thriving plant.
The children marveled at the complexity of a seed—a tiny package bursting with life. They discovered that plants, just like us, require certain essentials to flourish. Water, sunlight, nutrients,and space were all essential ingredients for their green companions. Through stories and interactive lessons, the young learners absorbed knowledge like sponges, grasping the importance of each element in a plant’s life cycle.
Inspired by their newfound understanding, these young champions of nature are motivated to make a positive impact on their environment. With a shared sense of purpose, they brainstormed ideas to create a greener school community. Their young minds brimmed with creative solutions—planting more trees, starting a vegetable garden, and beautifying the surroundings with colorful flowers.
Their dedication to the survival of their young seedlings continues. Armed with watering jugs, they take turns caring for their precious plants, developing a sense of responsibility and empathy for all living things. Through their hands-on experience, they discovered that nurturing plants not only benefits the environment, but also brings joy, fulfillment, and a sense of accomplishment.
The journey of Year 1 students into the world of plants has been an incredible voyage of discovery and growth. These young hearts and







Year 2O Travels Back to Ancient China
by Orla O’Dwyer, Year 2 TeacherThis year, one of the cross curricular topics Year 2O studied was ‘What if I was a news reporter in Ancient China’. We researched China’s location on the world map, physical features, the Shang dynasty and its culture.
The children loved learning about the different landmarks so much that they wanted to make their very own Great Wall of China: in pairs, the children chose a section of the wall they would like to create out of clay. Their choices varied from stone path to bricks, turrets, and steps.
Before making their section of the wall, the children researched the history of the wall, the length, and uses of the wall in Ancient China.
While building the wall, we kept 4 questions to the fore of our minds – What it was made from? What does it tell us about life in the Ancient China? What was it used for? and Who might have used it?
It was evident from the children’s open mindedness and ability to link back to previous lessons, that they learned a lot of interesting facts on this topic.








Year 3O Make a Magic Potion
by Orla O’Dwyer, Year 2 TeacherIn Term 3, the children in Year 3O have been exploring the unit of measurement in Maths. We have also been looking at the importance of collaboration and effective communication in science and English. One of our most recent group activities took skills from Maths, Science, and English to create instructions on how to make a magic potion for a fictional character.
The children worked together to measure out and record a range of ingredients, such as pig blood and whale saliva, then used their knowledge of grammar in English to create a set of instructions using fronted adverbials, bullet points, and commas. The children were able to successfully link their learning and thoroughly enjoyed creating their magical potions, even though they were not allowed to drink them!





Year 3T’S Favourite Cross-curricular Topics
by Alison Tansley, Year 3 TeacherCross-curricular work fosters the development of children’s knowledge, skills, and understanding in an engaging and interconnected manner. Establishing connections between different academic subjects, Cross-curricular projects offer students a creative approach to enhance learning. Through cross-curricular learning, students can explore the history of a specific topic and apply their knowledge across various lessons, enabling them to identify patterns of information between subjects and reinforce key concepts. Our aim is to naturally integrate literacy, math, science, and other subjects, ensuring that the connections between lessons are seamless and meaningful. The success of this approach lies in empowering students to apply their learning from one subject to another, ultimately fostering their engagement and facilitating progress for all.
This year, in Year 3, our ‘What if’ guiding questions over the year were:
• What if plants did not exist? (Ancient Maya in History, Plants and Animals in science)
• What if you could be a character in a Greek myth? (Ancient Greece in History)
• What if the Romans had never invaded other countries? (The Romans in History)
• What if the Earth was not made up of tectonic plates? (Volcanoes, Earthquakes and Tsunami’s in Geography and Pompeii/The Romans in History)
• What if Vikings had pet dragons? (The Vikings in History)
As we approach the end of our time in Year 3, I encouraged the students in my class to reflect on the various topics we have explored throughout the year. I requested them to select the one topic that resonated with them the most and articulate the reasons behind their choice. Let us delve into their captivating selections:
I asked the students in the class to reflect upon the topics we have studied. I asked them to choose the topic they enjoyed learning the most and explain their reasons. Here are their choices:
Letitia found great joy in delving into the topic of ‘Plants’ during the thought-provoking exploration of ‘What if plants did not exist’
As someone who appreciates nature’s wonders, Leti expressed her love for plants and flowers. Her memory latched onto a fascinating detail: she remembered it was interesting to see that the flowers on the Cacao tree are white and pink.
Leti, Liam, Lucas, and Ralph were fascinated by the Roman civilization, hence their favourite topic was learning about the Roman civilisation during the ‘What if the Romans had never invaded other countries’ topic. They explored the Romans’ cultural impact from their conquests, including language influences and architectural wonders like the Colosseum. Leti’s visit to Rome heightened her appreciation for Roman engineering. Lucas delved into Roman sports and entertainment, particularly chariot racing. Ralph discovered intriguing facts about Roman society, including the gender disparity in the army.


Dimitra, Helena, Noga, Robert, and Vlad eagerly immersed themselves during the Ancient Greece ‘What if’ topic, learning about Greek Gods, Goddesses, mythological creatures, and captivating tales. among the group, Helena was particularly intrigued to discover the famed character Helen, a princess who appeared in the myth of ‘The Wooden Horse’ and the Trojan War. Meanwhile, Dimitra found herself captivated by the tales of Gods and Goddesses being about to assume different forms or wielding their powers to transform humans into creatures such as spiders. A memory for Dimitra was the story of Hades and Persephone, an enchanting explanation for the Earth’s four seasons. For Vlad, the highlight was the opportunity to unleash his creativity by designing a mythological monster, a daunting 13th Labour for the valiant Hercules to conquer. Robert, on the other hand, revelled in reading vivid descriptions of mythical beasts like the Hydra, the Chimaera, and the formidable Cerberus, who played significant roles in mythological narratives. Noga was fond of the myth of Perseus and Medusa, feeling genuine sympathy for Medusa’s transformation into a monster with serpents for hair, all due to an unfortunate clash with the mighty Goddess Athena.
Ella and Miruna selected the ‘What if’ topic about the effect of the Earth’s structure being made up of tectonic plates. They know that the tectonic plates moving cause earthquakes, volcanoes and tsunamis. Ella enjoyed reading the story ‘Escape from Pompeii’, by Cristina Balit. She thought that the characters in the story Tranio and Livia, a little boy and girl from Pompeii, were very brave and lucky to escape onto a merchant ship before their town was destroyed by ash. Miruna liked finding out more about the different levels of the Earth’s structure. She knows that the movement of the tectonic plates causes the earthquakes to take place.

Ella and Miruna selected ‘What if the Earth was not made up of tectonic plates?’ as their favourite. They understood that the movements of the plates gives rise to powerful natural phenomena like earthquakes, volcanoes, and tsunamis. Ella liked reading the class novel; Cristina Balit’s gripping tale, ‘Escape from Pompeii.’ The bravery and good fortune of the young protagonists, Tranio and Livia, who managed to flee Pompeii aboard a merchant ship just moments before their town was engulfed in volcanic ash, was something that Ella remembered clearly. Miruna’s fascination lay in discovering more about the different layers that compose the Earth’s structure. She was able to understand the pivotal role played by the movement of tectonic plates in generating powerful earthquakes.
Finally, both Hizran and Orijah gravitated towards the captivating topic of ‘What if Vikings had pet dragons.’ They eagerly absorbed the class novel, ‘How to Train Your Dragon’ by Cressida Cowell, during read-aloud sessions. Hizran found immense joy in unleashing his creativity by designing his very own dragon using computers, followed by engaging in descriptive character writing exercises to bring his creation to life on paper. On the other hand, Orijah loved discovering more about the reputation of Vikings as formidable raiders characterized by their mean-spiritedness, greed, and danger.
It was truly a gratifying experience to witness the unwavering enthusiasm and deep engagement exhibited by each and every student throughout the entire academic year, as they delved into a myriad of diverse cross-curricular topics, allowing their knowledge and understanding to flourish.


Year 4’s National Park Adventure
Exploring and Learning in the Great Outdoors
by Aliviana Sanders, Year 4 TeacherIn a wonderful culmination of some of our term’s learning objectives, the Year 4 students embarked on an educational expedition to the picturesque National Park. Our trip served multiple purposes, intertwining our studies in Geography and Mathematics, while ensuring that we also had a delightful dose of fun. With collaborative spirits and curious minds, we set out to explore the local area, conduct surveys, and revel in the joys of a brand new playground.
Guided by our study of Geography, we aimed to conduct a thorough survey of our surroundings. As we ventured from the school to the National Park, the students took on the responsibility of tracking and documenting the various types of places we encountered along the way. They independently chose locations ranging from parks, schools, grocery stores, and coffee shops to restaurants. The journey became an exciting adventure, as we observed our community with fresh eyes and an appreciation for the diverse amenities that surround us.
Our Mathematics studies in statistics seamlessly intertwined with our geographical exploration. Armed with precision, speed, and accuracy, the students diligently compiled their data and transformed it into vibrant bar charts. The collaborative effort shone, as they shared their findings, engaging in lively discussions and learning from each other’s perspectives.
But our adventure was not limited to learning alone. The essence of our core values of bravery and happiness resonated throughout the day. As the students soaked in the beauty of the park, they embraced their courageous side by conquering the exciting new playground equipment. It was a perfect opportunity for them to enjoy the rewards of their dedicated efforts and bask in the joy of being part of a vibrant school community.









Year 5 Dragons Den
by Lee Hawkins, Year 5 TeacherIn Term 3, Year 5 focused on studying the Industrial Revolution and its profound global impact. This era marked the greatest technological advancements in history, and so our exploration set out to cover the various aspects of the Industrial Revolution, including timelines, significant figures, historical events, and its influence on the modern world.
A key focus this year has been to foster a love for learning and encourage an independent growth mindset. To help achieve this, we implemented project-based learning, incorporating our HPL values and attitudes. With this in mind, the teaching team decided to transform our Cross-Curricular lessons into a setting inspired by the popular TV show ‘Dragons’ Den’ (Imperiul Leilor).
The students were assigned a task and spent six weeks collaborating to incorporate essential elements, such as branding, detailed product information, the inventor’s history, advertising, costs, and profits. Ultimately, they would pitch their product to a panel of ‘Dragons’ to secure investment for their ‘business’.
Each group of students conducted research on significant inventions and inventors before selecting the product they would represent. They then proceeded to create a recognizable brand for their new product and company. Some impressive logo designs and slogans showcasing their ideas can be seen here.




With a product, inventor, and company brand in place, the aspiring entrepreneurs now needed to advertise their revolutionary products. Using online design tools and their creative imaginations, they produced billboards and TV commercials (see images).



Alongside the advertising campaign, the self-proclaimed business magnates ensured that potential consumers were well-informed about their product. To accomplish this, they designed eye-catching, professional, and informative brochures (see images).
The final step involved convincing a panel of business moguls (our ‘dragons’) to invest in their company and product. Parent volunteers took on the role of ‘dragons’ and were welcomed to the school for the students’ final pitches, where they sought investment for their groundbreaking products.
The students demonstrated exceptional teamwork, and their final presentations were truly excellent, showcasing their hard work. Both I and the ‘dragons’ were thoroughly impressed and proud of their accomplishments.
Giulia Canale: I liked when we presented our company because we finally presented the wonderful work that we had been doing, to our parents (the dragons). Because we accomplished the task that we had been working on really hard in the past few weeks. We were all very proud of our work and it was wonderful working together as a team.
Lucas Cornish: I would say that my favourite part was the branding (creating our name, logo and slogan) I liked it because we could be original and creative with the colours, names and designs. I also liked merging together all of our ideas into one great idea. It was great to hear all of my colleagues’ ideas, and how different they were to mine.



Year 6 Students Propose Innovative Mission to Mars, Paving Way for Future Exploration
by Robin Morrison, Year 6 TeacherIn a remarkable display of creativity and scientific acumen, groups of Year 6 students recently presented a groundbreaking proposal for a manned mission to Mars. The budding young minds showcased the ambitious plans of their company, outlining their unique strategies for reaching the Red Planet to ensure the survival of future astronauts.
One of the most intriguing aspects of their proposal was the idea of cultivating insects as a sustainable food source. Recognising the limited resources available on Mars, the students proposed harnessing the nutritional value and high reproduction rates of insects to supplement the astronauts’ diets. Such a solution could provide a protein-rich diet while minimising the need for traditional food sources.
Moreover, the students delved into the challenges of radiation by proposing subterranean habitats. By constructing living quarters underground, the astronauts would be shielded from the harmful radiation that permeates the Martian surface. This innovative approach prioritises the safety and well-being of the astronauts during their extended stay on the planet.
Additionally, the students highlighted the importance of oxygenation and the potential benefits of introducing carefully selected plants. Their proposals also included a comprehensive plan to cultivate vegetation capable of slowly oxygenating the Martian atmosphere, paving the way for future colonization efforts.
With their imaginative ideas and scientific prowess, these Year 6 students have showcased a promising vision for humanity’s future on Mars.






Year 6W Hospital Fieldtrip
by Tom Wilson, Year 6 TeacherIn an effort to promote scientific curiosity and inspire the next generation of young minds, 6W students recently embarked on a memorable field trip to a hospital and laboratory, providing a unique opportunity to witness first-hand the wonders of medical research.
On the morning of the trip, the students arrived at the hospital laboratory brimming with excitement. Greeted by enthusiastic lab technicians and researchers, they were given a tour of the stateof-the-art facility, equipped with cutting-edge technology. It was an exciting experience for the students and aspiring scientists, who were all very fascinated by the lab’s sterile environment and bustling activity.
One of the highlights of the trip, was the opportunity for students to conduct their own analysis, enabling them to grow their own bacteria in class. In order to do this, the children needed to either blow or imprint a fingerprint into some jelly made out of agar. As you can see from the pictures attached, some students fingerprints contain a lot of bacteria!

Early Years Open Mornings
by Deborah Ferguson, EYFS TeacherWe have had two fabulous open mornings this year, with the most recent event in May being the perfect opportunity to welcome many of our new families joining us in August 2023, along with a number of prospective families, into our Early Years Centre. We are also delighted that a lot of the prospective families have now confirmed that they will also be joining us in the next academic year.
We were very lucky that we had perfect weather for the entire morning, with warm sunny skies enabling the children to go outside to enjoy the sandpit, tumble hill, bikes, and scooters.
The children also listened to the story of The 3 Little Pigs and made their own story hats and then had fun exploring the toys and free flow interactive activities arranged for their visit.
Finally, we had an impromptu dance competition for the parents, who definitely rose to the occasion, and are now very much looking forward to seeing lots of new faces in the Early Years programme in the final week of August






Y2 & Y3 Residential Trip to Snagov
by Year 3 TeachersToward the end of Term 3, in the final weeks of the school year, Years 2 and 3 had the opportunity to enjoy a special adventure, on a two-night residential in Snagov. It was a wonderful way to reward the children for a busy year of learning, with the children taking part in a wide range of activities and developing key skills, such as independence, teamwork, and confidence in themselves.
The countdown had been on for weeks for some children who were extremely excited about up-coming trip, and so when the day finally arrived, the smiles were clearly visible on the faces of all the students. Once the final goodbyes were said, with hugs given to all parents, the luggage was placed in the bus and the children boarded, ready for our first stop of the trip, Bucharest Zoo.
At the zoo, we saw a wide variety of animals, including crocodiles calmly waiting for their next meal, and monkeys playfully jumping about and taking only a little interest in the passersby. We marvelled at the height of the giraffes, took great interest in the lions and tigers, and only after covering the vast majority of the exhibits, eventually stopped to enjoy our lunch amongst the many exotic animals, which we discussed with excitement on the bus trip to the hotel. At Casa Vlasia, we all got to play games with the animators before dinner time arrived, ate a delicious meal, and then watched ‘Luca’ together, eating popcorn in our favourite pyjamas.

On the second day, we were all up super early for a trip to Edenland, where we got to enjoy some time in the park and even got to ride on ponies. When we returned to the hotel, where the children were warmly greeted with several teambuilding activities organised by the animators, and had fun singing songs from the Summer Show around the campfire later in the evening.
On the final day, we enjoyed three hours completing a variety of jobs at Destiny Park, which was fun for the kids getting to be adults for a while, acting out their dream career, and for some draw inspiration for a future possible career.
The children thoroughly enjoyed their residential trip, exuding confidence and growing through the experience of challenging themselves in new situations. It was a pleasure to see the children having so much fun with their peers, watching films, visiting fun places, and taking part in the various team-building activities arranged across the three days. All the children showed an immense amount of courage and resilience and are already looking forward to next year’s residential trip!








Year 4&5 Residential to Poiana Brasov
by Giulia Canale and Lucas Cornish (Year 6)This year,Y4&5 joined forces on an end of year residential trip to Poiana Brasov,staying at the Ana Sports hotel for 5 days/ 4 nights full of action and adventure with the wonderful people from Progressive Sports.
Hello, I am Giulia Canale and together with Lucas Cornish we will be walking you through this year’s amazing residential trip!
DAY 1
We left school bright and early at 9:00am, and after a long 4 hour drive to Ana Hotels, arrived safely and met our activity leaders: Adi, Mihai and Andrei, who told us the itinerary for the week. But first, unpacking and lunch. The food, by the way, was amazing all trip and there was plenty to go around. Despite the cloudy and wet forecast, fun was still had in the afternoon. The amazing guys at Progressive kept us entertained with improv. games, activities, and lots of fun stuff. Then it was nighttime, and lights out at 10:30 pm, to be up ready for the next day.
DAY 2
Up early for breakfast and off on foot to the Telecabina. When we arrived at the end of the Telecabina’s course, we started hiked to the summit of the mountains in Brasov and back down the steep path to the Telecabina as it started to rain, but we were not going to let that stop our fun! Back at the hotel, we had lunch and 1h and a half to relax in our rooms. After, we hit the pool, which was soooooo much fun! We played games and relaxed in the hot tub. We then had dinner, played some games in the Activity Room, and lights out at 10:30.
DAY 3
On the third day, we went into the woods, where the trainers had set up a super mini-Olympics track with tires, a labyrinth, and an Indian bridge. Shortly after, we went to the field on which they had organised a fantastic capture the flag game. Once we had finished,
we headed back to the hotel for lunch, and then went to the activity room to play multiple games, including MAFIA! If you’ve never played Mafia, you’re missing out! We love it! Then a delicious dinner and after phone time, in which we called our parents to share all the fun we had had that day (actually, we called them every night, not just on Day 3). Bedtime again at 10.30.
DAY 4
On the fourth day, we went to the Adventure Park. It was super fun to explore many types of courses, and the forest too. At one point, it started raining lightly, but in the end it was raining buckets! Back at the hotel, we changed our clothes and headed to… wall climbing! It was very cool! After that, we went to another centre and were split into 2 groups. One half went bowling and the other went to the arcade, then swapped. A big shout out to Aron Gherasim in Y5 for being the best at bowling. Both places were super fun. Then back to the hotel. Most of us were really tired, so we had some relaxing time in our rooms before inner and then… PARTY! As it was our last night, so the trainers had organised a very enjoyable party. We even had a talent show, in which we sang karaoke, told jokes, and enjoyed JustDance. That was a late one!
DAY 5
On our final day, we had an extra half an hour to sleep in. Then packed our bags and went to a delicious breakfast. After, we went with the buses to a mind-blowing cave. It was huge! However, the most amazing thing was when they turned off all of the lights and it was complete DARKNESS…. I’ve never seen it this dark before. After that, we headed to the hotel in order to give our luggage to the driver, who put them on the bus. Time to head home.
Overall, we all really enjoyed this trip and would encourage next year’s Year 5 to go there, too. It was a marvellous experience and we can’t wait to go abroad next year, on the Year 6 residential.









Primary School Poiana Brașov Skiing Adventure
by Alan Cornish, Head of Primary SchoolNestled in the Carpathian Mountains, Poiana Brașov has become the traditional destination for the annual Primary School ski trip, which took place this year in the final week of Term 2a.
Guided by the experienced team of instructors at Progresiv Sport, our young adventurers eagerly tackled the snow-covered slopes, and were lucky to have the best snow of the winter.
And at the end of each, day, having exhausted ourselves on the slopes, our evenings were filled with games, climbing, swimming, and many other fun activities to ensure we all went to bed tired, but happy.
As well as learning to ski, or perfecting our turns, we also learnt the importance of sharing a room, making our own beds, and the benefit of putting wet ski gloves on the radiators - all important life skills!




World Religions Week @IBSB
by Orla O’dwyer, Year 2 TeacherIBSB celebrated World Religions Week this year on April 19-21, as a part of our PSHE programme, offering our students an enjoyable and informative learning experience.
Each class was given a different theme and religion, encouraging the students to discuss various gods, symbols, beliefs, and pilgrimage sites visited by people from around the world.
The aim of the PSHE focus on world religions is to encourage children to understand and appreciate differences in beliefs and customs, to foster tolerance and respect, and promote love for humankind. The central message we want to give to our students is that people have many different beliefs and gods that they worship but everyone is special!
Through the various activities and focus themes, students are enabled to see the imperative need for dialogue among different faiths and religions to enhance mutual understanding, harmony, and cooperation among people. We learned that we need to love and respect everyone, no matter what religion they believe in, and to spread the message of harmony and tolerance in our daily lives.





Primary School MartisorCelebrating Creativity
by Orla O’dwyer, Year 2 TeacherOur Romanian traditions are important to us and one of our favourites is Martisor, marking the arrival of spring and the promise of new beginnings. Thanks to the creativity of our pupils, inspired by the Secondary CAS team, our classrooms were transformed into a tapestry of handmade Martisor trinkets, crafted with love and care by imaginative young minds. From carefully woven red and white threads symbolizing love and purity to crafts representing nature’s awakening, each Martisor was made with love and given, as a token of spring, to mums and nans. We hope you loved them!





PwC România

PwC este o firmă integrată de servicii profesionale, recunoscută pentru calitate, oferind soluţii specifice pentru fiecare situație cu care se confruntă clienţii noştri - companii locale şi multinaţionale, precum şi instituţii publice:
• audit financiar
• consultanţă în afaceri şi management
• consultanţă fiscală şi juridică
Avem o echipă de peste 800 de specialişti, condusă de 24 de Parteneri.

Cu o istorie de 170 de ani, PwC este o rețea de firme, prezentă în 152 de țări la nivel global.
PwC lucrează cu 84% din companii prezente în Fortune Global 500 și cu peste 191.000 de companii antreprenoriale, având peste 328.000 de angajaţi.

Primary School Sustainability Committee Leads the Way
by Victoria Fay, Primary School Sustainability CoordinatorIn the primary school, a group of dedicated students, teachers, and parents came together to form the Primary School Sustainability Committee. With an aim to raise awareness about environmental issues and promote sustainable practices, the committee has been making significant strides towards creating a greener and more eco-conscious school community. From organizing themed events to implementing practical changes, their efforts are inspiring both students and their families.
One of the standout initiatives of the Primary School Sustainability Committee is the Nude Food Week. Every month, students learn about the detrimental effects of plastics on our environment and the importance of reducing waste. During this week, children are encouraged to bring lunches that are free from single-use plastic packaging. By adopting reusable containers and minimizing waste, students learn firsthand about the positive impact of their actions on the environment.


In an effort to conserve energy and promote energy-saving habits, the committee again organised Earth Hour within the wider school community. This event encourages everyone to switch off unnecessary lights and electrical appliances for an hour. By raising awareness about the importance of saving electricity and reducing carbon footprints, the committee aims to instil eco-conscious behaviour that extends beyond the school premises and into students’ homes.
Recognizing the detrimental impact of plastic cutlery and packaging on the environment, the committee successfully eliminated these items from school lunches. By replacing them with eco-friendly alternatives, such as reusable utensils, the committee not only reduced waste, but also educated students about making positive sustainable choices. This change has not only significantly reduced the school’s plastic waste, but has also empowered students to make environmentally responsible decisions in their everyday lives.
The Primary School Sustainability Committee understands that recycling is crucial for preserving our planet’s resources. And have taken steps to ensure that paper used within the school is recycled, promoting a culture of waste reduction. Moreover, they actively encourage families to embrace the principles of “reduce, reuse, and recycle” by organizing recycling challenges to earn precious house points. By involving families in their efforts, the committee aims to extend their sustainability initiatives beyond the school environment and into the community at large.
The Primary School Sustainability Committee has proven itself to be a driving force in creating a sustainable future. Their unwavering commitment to sustainability sets an inspiring example, reminding us all that even small actions can lead to significant positive change. With the committee’s ongoing efforts, our primary school is on the path towards a greener and more sustainable future.



Primary School Francophone Week
by Daniela Momirleanu, Primary and Secondary School French Teacher
Learning French at IBSB is a fun interactive process that takes place both inside and outside the classroom. The Francophonie activities organized for students in years 5 and 6 offered our students the opportunity to visit the French Institute, play board games in French, explore the book selection, and play video games, were really engaging and interactive experiences. These activities provide both a fun and immersive way for our students to practice and improve their French language skills, whilst learning more about Francophone culture.
Playing board games in French not only helps students improve their vocabulary and comprehension, but also fosters social interaction and teamwork. The availability of a book offer is also commendable, as it encourages students to explore French literature, which can enhance both their reading and comprehension skills and enrich their understanding of the contextual information used to set the stories. Incorporating video games into the activities is yet another way to potentially motivate students, making learning enjoyable, by providing an immersive and interactive environment where students can practice their language skills.
For the year 3 and 4 students, they had the opportunity to discuss some of the most famous French monuments and French cuisine, offering a great way to introduce them to some of the key cultural aspects of the Francophonie. Learning about iconic landmarks and exploring different French dishes can spark their interest and curiosity, creating a deeper appreciation of French culture.
Overall, these various Francophonie activities offered a mix of educational, interactive, and cultural experiences, preparing our students for the rigours of language study that await them in the high school programme and beyond.










Primary School Cervantes Day Celebrations
‘Culture, Fun, and Flavour’
by Alexandra Ivascu, Spanish TeacherOn April 23rd, our primary school celebrated Cervantes Day, an event full of colour and the joy of learning, in honour of the famous Spanish writer, Miguel de Cervantes Saavedra, author of Don Quixote de la Mancha.
MFL Spanish students from all grades across school participated in the festivities, wearing traditional Spanish and American costumes in an explosion of vibrant colours. The festive atmosphere filled every corner of the school, with traditional music and decorations related to Hispanic culture.
To encourage interest in Cervantes’ life and work, fun quiz contests were organized, offering students the chance to showcase their knowledge about this important author and his influence on world literature. The winners received prizes and the recognition that acknowledge their enthusiasm for Spanish culture.


The 5th and 6th grade students also had the opportunity to experience a unique culinary journey, enjoying a special lunch at a local Mexican restaurant. There, they tasted a variety of delicious traditional dishes, such as tacos, enchiladas, and quesadillas, sampling the rich Mexican cuisine and broadening their cultural horizons.
Celebrating Cervantes Day served not only to honour one of the greatest writers of all time, but also immerse our students in the cultural richness of the many Spanish-speaking countries. We are confident that this experience leaves them richer, with a deeper appreciation for the diversity of Spanish culture worldwide, reinforcing our commitment to promoting multicultural education and language learning, shaping our students into global citizens capable of understanding and appreciating the diverse cultural expressions of the world.







Black Sea Schools Art Competition - 2023
by Orla O’dwyer, Year 2 TeacherThe Black Sea Schools Art Competition once again offered our students the opportunity to get creative with the theme ‘The World Through My Eyes’. Last year, our students achieved some success, and having won the KS1 category, it was with a sense of excitement that students keenly submitted their entries this year, reaching the podium once again.
Student artwork from as many as twenty-seven schools from around the Black Sea region were exhibited for judging at the British Ambassador`s residence in Ankara. Her Excellency British Ambassador Jill Morris, had the challenging job of judging the art, eventually deciding on 1st, 2nd and 3rd places based on both impact and evidence of technical skill.
Congratulations to all the students for their amazing work and expressing their creativity. We had difficulty choosing just 3 pieces to send on to the final round of judging, so I imagine it was doubly hard for the Ambassador, who had the task of selecting the final winners. We are, therefore, extremely delighted to receive word that Adina from Year 2 was chosen to receive a prize for third place in the Key Stage 1 Category.
A big thank you to the British School of Ankara for coordinating the competitions this year and bravo to Adina!




IBSB Student Wins International COBIS Art Competition 2023
by Orla O’dwyer, Year 2 Teacher
The COBIS Art Competition is an annual competition offering young artists the opportunity to compete internationally, showcasing their talent.
This year the theme was ‘Who Am I?’’, with a total of 670 entries received from students in 140 COBIS schools worldwide. The final round of Judging took place at art faculty at the University of Bournemouth, with a £100 Amazon gift vouchers on offer for the winners.
It is with this in mind, that we congratulate Erika Peet (Y5) as winner of the Key Stage 2 Competition, impressing the judges with her selfportrait as a futuristic traveller on a SpaceX mission to Mars, drawing her inspiration from Supergirl, who she says is one of her role models, intended to show that with education and effort, girls can do anything.



Here is what the judges said:
Thisisabeautifullyexecutedwatercolourpainting.Thegraduatingdepthof coloursinthebackgroundintensifytheappearanceanddepthofendless space.Ourfocusisdrawntothecentralfigureandthedelicatewatercolour brushstrokesonthespacesuitwhichappearsominimalandyetisso effectiveaddtotheotherworldlyqualityofthispainting.Theexcellentuse ofaforeshorteningtechniquecreatesasuperbsenseofillusionwiththe subjectrecedingintodistantspacewhilstfloatingtowardsusaddingtothe senseofanti-gravityfloatinginspace.Thispaintingevokesaremarkable senseoftimelesssuspension.
Bravo Erika, you have made us all very proud!

IBSB Black Sea School Champions 2023
‘Celebrating Mathematical Excellence’
by Orla O’dwyer, Year 2 TeacherThis year, the Primary School has been abuzz with exciting mathematics competitions. The students across the school competed in the Century Cup and Kangaroo Maths, and pupils in Years 5 and 6 also recently joined forces to compete in the Black Sea Schools Maths Cup. Building upon our past successes, we had our sights set on reaching new heights. And indeed, we did just that!
For the fourth consecutive year, our talented mathematicians participated in the Black Sea Schools Maths Cup, where they have consistently secured second place. This year, however, they showcased their unwavering determination and perseverance, propelling them to claim the title of BSS Maths Champions for the 2022-23 academic year. This outstanding achievement is a testament to their exceptional mathematical abilities, collaborative spirit, and unwavering commitment to excellence.
While our team’s collective victory in the Black Sea Schools Maths Cup fills us with immense pride, we must acknowledge the remarkable achievements of our individual students. Many of them took part in the Kangaroo Maths Challenge, an individual competition that put their mathematical prowess to the test. Our students rose to the occasion, achieving remarkable results and demonstrating a range of High-Performance Learning (HPL) competencies.

Precision was a key element showcased by our students, as they meticulously calculated and constructed their diagrams with the utmost accuracy. They adeptly engaged in problem-solving, tackling multi-step challenges that demanded careful analysis and systematic problem-solving strategies. Moreover, our students demonstrated their metacognitive abilities by adapting their thought processes to the diverse range of questions presented to them.
As we prepare to defend our title in the upcoming year, we are filled with excitement and anticipation. We are confident that our school community will continue to foster a love for mathematics and empower our students to push the boundaries of their potential. Congratulations once again to our talented mathematicians. You have made us proud, and your success is a testament to the power of dedication, perseverance, and a passion for learning. Keep shining brightly, and may your mathematical journey continue to inspire and ignite the minds of many.









ASFRomania Workshops
Developing Financial Knowledge, Skills, Attitudes, and Behaviours
by Orla O’dwyer, Year 2 TeacherIn the third week of March every year, schools across the world celebrate Global Money Week. This week shines a spotlight on the importance of ensuring that young children from an early age are financially aware, and are gradually acquiring the knowledge, skills, attitudes, and behaviours necessary to make sound financial decisions and ultimately achieve financial well-being and financial resilience in their future lives.
At IBSB, we celebrated this week by inviting ASFRomania to run workshops with all our classes. The age appropriate topics covered related to needs and wants, investment, and savings. It was particularly interesting to hear the difference in opinions of our students, for example in defining needs and wants, as some children in the younger years responded that we all need a foreign holiday every month!
As financial education is a key part of our PSHE curriculum, and conducting a financial education workshop brings additional value in the development of children’s personality, creates the premises for the development of an independent adult, and increases their interaction with the economic and social environment.





The New Junior Duke
by Orla O’dwyer, Year 2 Teacher
This year, IBSB introduced a wonderful new programme called the Junior Duke Award to the students in the primary school. This programme includes the Micro Duke, Mini Duke and Junior Duke Awards for children age of 3 to 12 to encourage independence, confidence, resilience, and self-motivation, whilst practicing a variety of key life skills.
Each level has its own specific selection of challenges, with the children needing to complete a pre-determined number of these successfully to receive their award. These include skills relating to First Aid, ICT, Eco awareness, Drama, Music, Sport, and life skills such as cooking and puncture repair. The children were each given some of the necessary skills to complete in school, but most of the challenges required a good deal of time and effort out of school with the support of friends and family.
As we approached the end of the school year, we saw a natural increase in the number of students that completed their challenges, with a well-earned certificate and badge given out at the end of the school year.
Thank you to the staff and parents who supported the students on their Junior Duke journey. Feedback has been extremely positive and so we hope to see an increase in the number of students signing up for the Junior Duke Award next year, supporting our students to develop new skills and gain lots of house points along the way.



An HPL Primary School Year in Review
by Lee Hawkins, Primary School HPL CoordinatorHello, and welcome to the final Primary School HPL newsletter. This one is a little different as we take a look back at the year behind us.
Each lesson, we ask students to reflect on their learning and relate that to our HPL attitudes and attributes. I think then, it is only fair that we, as teachers, do the same. Here is a reflection of how HPL has been used from the smaller students in Early Years to the bigger ones in Year 6, about to embark on life in secondary school.
EYFS
In EYFS, we have focused on trying to master a core selection of core HPL Values, Attitudes, and Attributes, with all the children making good progress over the course of the school year. The main focus has been on Self-regulation, which is the key to helping our children to learn. Managing emotions can be tricky for anyone, but it is clear that all of the children have made considerable progress over the year. They have learned breathing techniques and songs that can help them to calm down. They also know how to make use of the calm corners to take time out when needed. As a result of this ongoing focus, we are now seeing more children trying to use words to solve problems and asking for help if they need it.
We have also spent a lot of time practicing different skillscolouring, cutting, gluing, writing letters and numbers - the list is endless. We are now seeing and enjoying the rewards of their hard work as they now work with greater independence, which allows us to give them more challenging learning experiences and to encourage them to develop more resilience in their learning. Another big area that we are continuing to develop is being concerned for society. The children are learning how to take care of themselves, the classroom, resources, and the plants in the garden. This has been a challenging one, as they enjoy picking leaves from the trees and bushes, but are slowly learning that plants are also living things and why we need to take care of them.

The Reception class definitely have a good base to work from in Year 1 next year and our Nursery children are going to be super role models to all of the new children that we will welcome in 2023-24, helping us to teach the others all about HPL.
Year 1
This year has offered many opportunities for the Year 1 students to use and develop the HPL Values, Attitudes, & Attributes in all of our lessons. This year we introduced the HPL language and incorporated it into every lesson, using the attributes as categories in our Class Dojo, awarding points when we identified the attribute. The Values, Attitudes & Attributes we introduced were perseverance, collaborative, practice, connection finding, originality,

risk-taking, concern for society, resilience, self- regulation, fluent thinking, speed and accuracy, automaticity, open-minded and enquiring.
The children use these words independently and can identify the attitudes and behaviours that they imply. In the core subjects, we use perseverance, resilience, and practice to describe the behaviours we would like to see. We also have a lot of discussion regarding speed and accuracy. They understand that this is a balance that needs to be attained.
In CC and English we discussed the need to be collaborative, to make connections and the need to be original and creative. In addition to using Values, Attitudes & Attributes in our lessons, we also sent home accompanying homework. As we introduced each new VAA, we talked about examples in our real lives and asked students to work with parents to think of examples of when they had demonstrated this attribute outside school. They talked about it at home using the vocabulary and often sent photos and examples of them displaying HPL behaviour. It worked out very well and provided parents with the opportunity to learn more about HPL and the VAAs.
It has been a real pleasure to guide the children through their initial experiences with HPL, helping them acquire the foundation needed to become successful HPL students in the future.
Year 2
This year has offered many opportunities for the Year 2 students to use the HPL Values, Attitudes, & Attributes across the curriculum. At the beginning of the school year, we introduced the HPL language gradually into our lessons and homework, and awarded the children for demonstrating chosen attributes throughout the school day.
The Values, Attitudes & Attributes we introduced were perseverance, collaborative, practice, connection finding, originality, risk-taking, concern for society, resilience, self- regulation, fluent thinking, speed and accuracy, automaticity, open-minded and enquiring. In our CC lessons, this was evident across our projects; from our collaborative work on our Ancient Egypt project, persevering and working together to build the Wall of China in our Ancient China topic.
During the many projects completed this school year, the children have deepened their understanding of HPL language and values. In Year 2, as part of our weekly homework, the children spoke with their parents at home about a chosen HPL value and sent photos of them displaying this behaviour. It has been a real pleasure guiding
the children in Year 2 through their first experiences with HPL, helping them acquire the foundation they need to become excellent HPL students as they prepare to start KS2.
Year 3O
Over the course of the year, the children in Year 3O have continually developed and demonstrated many of the key attributes of HPL learning. The projects we have completed during cross curricular lessons, such as our recent news reports on natural disasters, have given the children the opportunity to work collaboratively and build upon skills like fluid-thinking, taking an open-minded approach and showing curiosity and resilience in their learning.
I have been particularly impressed with their originality when approaching more creative tasks and how well children have been able to communicate their ideas respectfully. During maths lessons, we have had many conversations regarding the importance of speed and accuracy, and many have demonstrated their ability to apply their deepening knowledge of maths to reasoning and problem-solving tasks.
Self-regulation has also been a big topic of discussion in Year 3 this year, as the children have been developing their skills of self-control at break times and inside the classroom. It has been a pleasure to guide the class in this stage of their journey in becoming HPL learners and I have thoroughly enjoyed watching them develop their skills and make connections in their learning.
Year 3T
This year, Year 3T embraced HPL Values, Attitudes & Attributes during most lessons. Wherever possible, we incorporated HPL language into our success criteria and we used Class Dojo to award points for identified attributes. Introduced values included: perseverance, collaboration, practice, originality and being hardworking. Students have begun to actively use these words and they are better understanding their associated attitudes and behaviours. In the core subjects of maths and literacy, we emphasised perseverance, resilience and practice, discussing the balance between speed, accuracy and fluent thinking.
In English, the students have made connections when reading texts and answering questions to demonstrate their understanding and when writing texts they displayed originality and creativity. Cross-curricular work is great because it offers opportunities to enhance the students knowledge and understanding through interconnected learning experiences.

The Year 3 ‘What if’ projects encouraged strong analysis skills. The students made connections, such as exploring the impact of tectonic plates and the Romans’ legacy. The students proved they have become more confident at presented their research after analysing data and they were brave when sharing their perspectives. Year 3 PSHE lessons focused on self-regulation, empathy and respect.
Over the course of the year, it is clear that the students are becoming more familiar with HPL vocabulary and they are improving their metacognition. They will further develop their skills as excellent HPL learners as they move on to their new class.
Year 4
Year 4 have whole-heartedly embraced the HPL VAAs and ACPs this year. We learned the new terms by Practicing often and now use them with Automaticity. Meta-Cognition seemed impossible to understand at first, but we use it all the time, especially during Maths lessons. We learn exactly how to think in order to solve particular problems and then are able to solve those problems independently whenever we encounter them.
In English, we love to let our Creative skills shine. We use Intellectual Playfulness to adapt types of texts and make them our own. Once we understand the building blocks of a certain text, we use Originality to create our own and Flexible Thinking and Self Regulation to make it better. During CC lessons, we Collaborate and Confidently present our projects to our peers and teachers. Across the curriculum, we use Linking skills the most often, especially Abstraction and Connection Finding to apply what we already know to help us learn new concepts.
We also use Precision in every lesson, ensuring that our work is neat and that we answer every part of every question. Inside and out of the classroom, our biggest project this year has been improving our Empathy skills by thinking of others, listening to each other and sharing our emotions in a kind and caring manner.
Year 5
This year has offered many opportunities for the Year 5 students to use the HPL Values, Attitudes & Attributes as well as the Advanced Cognitive Performance Characteristics.
In our CC lessons, this was evident across our projects; from the YouTube style educational video in term 1A to the most recent World War 2 performance in term 3. During all of these projects the
children have honed their skills and become very adept in areas such as: Collaboration, Open-Mindedness, Originality, FluentThinking and many more.
Across all of our lessons, there has been a noticeable improvement in Self-Regulation. The students are learning to work through their work, check for understanding and make improvements or corrections themselves. Not only have I witnessed an improvement in Self-Regulation academically, but there have been huge strides made emotionally, too. I have saw conflict resolution be SelfRegulated and Empathy used regularly to ensure that the class dynamic remains a positive and collaborative one.
It has been a pleasure watching and guiding this Year 5 group through their High Performance Learning journey and I am sure they will continue to impress me and their future teachers as they continue to grow into remarkable young people.
Year 6
HPL has been an integral part of the learning journey of students in Year 6, having also experienced this in Years 4 and 5. They are the epitome of the values IBSB promotes and it has been a pleasure to be a part of their learning journey as they now move onto Secondary School.
We could write pages and pages of each HPL value that the students have achieved. However, instead, what is clear to me is that Year 6 students are now set up for lifelong learning and achievement. They are able to engage in their own learning and know what it takes to be successful.
Music
High Performance Learning in music class offered my Y5 and Y6 students an enriching experience that extends beyond musical skills. Through a comprehensive focus on competencies such as musical proficiency, creativity, collaboration, discipline, critical thinking, and cultural appreciation, students thrived and developed into well-rounded individuals.
This approach empowered students to discover their musical potential, express themselves authentically, and cultivate a lifelong love and appreciation for music. This year we explored a wide range of musical genres, styles, and traditions. Music is inherently a collaborative art form, and HPL in music class emphasizes the value of teamwork. We worked through shared rehearsals and performances, during which the children developed essential skills

such as active listening, cooperation, compromise, and effective communication. A very important part of our school community are assemblies and shows.
As HPL fosters a deep understanding of music theory and technique where students learn to read sheet music, recognize rhythm patterns, and grasp fundamental musical concepts, they developed strong instrumental and vocal skills, enabling them to perform with confidence and precision which was evident in every presentation the students took part this year. I look forward to seeing them grow!
I am sure the students in Y5 and Y6 that I had the pleasure of interacting with this year on a weekly basis will transition smoothly into their next academic year and will continue to develop these skills which can be applied in every aspect of their lives.
MFL
HPL is an important part of the MFL lessons given the fact that students are often required to leverage a host of skills. Collaborative skills are front and centre, as students work together in pairs or groups to practice new vocabulary, sentence structures, and cultural concepts. They engage in the termly ‘What if’ projects, where they’re tasked to imagine and explore hypothetical situations in the target language, thereby exercising their creativity, fluent thinking, and originality.
These projects often require them to think outside the box and use the language in non-routine, imaginative ways. Furthermore, resilience is essential as students navigate the challenges of learning a new language. Mistakes are inevitable, but our students persevere and see them as opportunities for growth, practice, and progress. Even when new students join the class with no prior knowledge of the language, they blend in with the help of these skills. They learn to embrace the discomfort of not knowing, and in doing so, they cultivate resilience, becoming a vital part of the collaborative learning environment.
PE
This year demonstrated once more the amazing potential of our students regarding PE. Talking about High Performance Learning, more and more students desired to get into the school football teams, there actually have been some debuts at the Primavera and Lumina Cup competitions this year. Even though we did not win, the boys demonstrated their skills against very tough opponents, giving their best in every match.
All the students increased their level regarding PE during the school year, in all aspects of the subject, especially in football and handball, which involve team collaboration, precision in passing and shooting, controlling the ball, etc.
With the right guidance, the future looks bright for our students, from the PE HPL point of view, and with great results in future competitions.
As you can see, HPL is truly at the heart of everything we do in the Primary School. I look forward to writing to you again in the next academic year but until then, we all deserve a nice, relaxing summer holiday.
Wishing you a wonderful holiday, wherever you are heading,

House Competition Bake Sales Set New Record
by Orla O’dwyer, Year 2 TeacherTerm 3 will be remembered for many fun activities and events, including what can only be described as the best ever set of Primary School Bake Sales, gaining not only valuable house points, but also raising an impressive 11,000 ron for local charities, which is a new IBSB Bakesale record. Well done to everyone!!

4191 house points.

3174 house points.
Here are some opinions about bake sales from a few of our students and staff:
“ItwasreallynicebeingpartoftheBakeSale.Youfeltlikeyoucouldmakeanything!” - Eda Cil

2589 house points.
“ItwasgreattohavetheBakeSalesbackagain,andtohavebakedgoodsmadeandsoldbythekids” - Mr Cornish, Head of Primary
“TheBakeSaleexperiencehelpedmebemoreresponsibleandbetterunderstandthejobofabaker.” - Irene Sanduleasa
“Iwasreallyimpressedbytherangeandqualityofferateachofthehousebakesales-therewassomuchtochoosefrom. Ajobwelldonetoboththestudentsandtheparents!” - Mr Peet, Head of School

Primary House Games Fun x 2
by Orla O’dwyer, Year 2 Teacher
The primary school students were lucky to be able to enjoy 2 House Games in term 3, organised by our hardworking and extremely diligent House Captains.
For those who don’t know much about our House Games events, they are a series of competitions organised by the students for the students in order to earn valuable house points, but more importantly to promote collaboration and teamwork, resilience, perseverance, and a long list of HPL values, attitudes and attributes.
The first House Games event in term 3 was won by Dobrogea and the second by Muntenia, so well done to both houses. For this result achieved. Unfortunately, Transilvania didn’t win any of the house games events this year, so it’s back to the drawing board for Transilvania, who I am sure will be back bigger and better than ever next year.
Here are the opinions of kids who participated in the House Games:
“TheHouseGamesofferagoodopportunityifyourhouseneedspoints.”
- Mihai Nicolaescu“IlikeHouseGamesbecausewearecollaborative,doingactivitiesusing friendshipandcollaboration.Wealsogetpointsforwhatwedo.”
- Aaron Tengku“IlikeditwhenIwasjumpingovertheobstacles.itwasalotoffun.”
- Tudor Popescu


Year 6 Graduation Returns to Carol I Biblioteca
by Alan Cornish, Head of Primary SchoolThe Year 6 graduation and awards ceremony returned to the opulent surroundings of Carol I Biblioteca, a fitting location that added grandeur to the evening and left a lasting impression. The evening was filled with a sense of achievement, excitement, and pride as the Year 6 students celebrated their accomplishments and bid farewell to their Primary School years.
The highlight of the evening was the poise and poignancy of the Year 6 speeches, filled with aspirations, gratitude, and a sense of nostalgia. I doubt many of the adults reading this could imagine standing in front of a packed auditorium to deliver their own speech at the age of 10 or 11 to their peers and families. It is remarkable, they are remarkable, and we should feel a sense of pride and awe for these remarkable young people.
As they received their graduation certificates and threw their mortar boards into the air, they symbolically closed one chapter of their lives and embarked on a new journey towards the new opportunities of Secondary. The future is bright…




Primary School World Book Week
by Orla O’dwyer, Year 2 TeacherWorld Book Week took place this year for the ninth time, from Wednesday March 8-10, 2023, as a celebration of books, reading and all things literature.
Teachers organised many book-related in-class activities. Students in Key Stage 1 and Year 3 worked on creating a new book character who was a fruit or vegetable; they had to create a front cover and an exciting blurb for the book in which this character would appear. The older Key Stage 2 classes completed a book character analysis with an ‘HPL in action’ theme; they had to identify characters who demonstrated the values, attitudes, and attributes of being a good learner. Many students participated, for example, in a Pokémon themed one month reading challenge, and all the classes decorated their doors with a book theme. Each class also took part in a USAstyle Spelling Bee, with the most successful children progressing onto more challenging words during the event!
We had a ‘Guess whose favourite book’ fun activity, where members of staff hid behind the front cover of their favourite childhood book. The students then had to guess which teacher had chosen which book as their favourite. We also had some ‘Mystery readers’ visiting the classrooms as an ‘unannounced’ surprise in the form of parents, who had come to read their favourite story aloud to the class.
For some at-home activities, it was time to get creative and have

some fun. Students were encouraged to decorate a box as a favourite book and bring them to display at school.
Finally, on Friday the 10th of March, we have a non-uniform day, when everyone came to school dressed up as an interesting word for a ‘vocabulary parade’. The only rule was that the definition of the word needed to be displayed. There were a huge array of costumes and the students really enjoyed highlighting their creativity.
All in all, Book Week was another great success, with a huge thank you going out to all those involved in making the week the success it was.


IBSB Alumni Catch-up 2023
by Kendall Peet, Head of SchoolWhen IBSB Alumni Thomas Ferfeli (Class of 2015) approached the school offering to host an IBSB Alumni gathering at his lakeside restaurant in Cernica, it was an offer simply too good to refuse. A date (June 23rd) was quickly set, arrangements agreed, and notices sent out across the IBSB network.
In truth, we knew there wouldn’t be enough notice for everyone to attend, especially those living abroad, but agreed to proceed with the idea of using this event as both a tester to measure the level of interest and a taster of things to come at future gatherings.
In the end, though, the event proved a great success, as the alumni continued to roll in with the evening extending on into night. As you can see from the photos, there were too many alumni present to name each one in person, with perhaps just a special mention of a few of the ex Head Girls and Boys who turned up on the night, including Alex Vlad (Head Boy and School Dux 2012), our first student admitted to Cambridge, Alexandra Lulache (Head Girl and School Dux, 2013), our first student admitted to LSE, Sebastian Mararu (Head Boy, 2015), Catrinel Craiu (Head Girl and School Dux 2017), and Andreea Stefanescu (Head Girl, 2020).
I’m sure all present would agree that it was a wonderugl evening enjoyed good company, with a steady flow of social drinks, an enticing finger food buffet, and the constant sound of laughter filling the airwaves with the excitement of old friends and colleagues reuniting – we think the photos tell the story best.

“It was wonderful to see so many of our alumni all grown up, leading adult lives, many having gone on to complete postgraduate studies, some already married with children, developing their careers, managing their own businesses. I was especially taken by overwhelming sense of gratitude expressed toward their time spent at IBSB, for the encouragement and support received from the staff, and the many cherished memories collected along the way.”
- Kendall Peet, Head of SchoolSee you at the IBSB Alumni Catch-up 2024!





Future Technologies less than 10 Years Away
by Aydin Korucuoglu, Computer Science TeacherOver the past decade, we have seen tremendous advancements in technology that have shaped our lives and transformed various industries. As we look towards the next 10 years, there is much to anticipate in terms of technological advancements and innovations. From artificial intelligence and machine learning to quantum computing and the Internet of Things, technology is set to change our world in ways we cannot yet imagine. This article explores some of the most exciting future technologies that are likely to emerge in the next decade and their potential impact on our lives.
1. Artificial Intelligence and Machine Learning advancements
Artificial Intelligence (AI) and Machine Learning (ML) have been making big strides in the last decade, and the next ten years will see even more exciting advancements in these fields.

Here are a few areas where AI and ML are set to make an impact:
Machine Learning in Personalized Medicine
Machine Learning algorithms can sift through vast amounts of data to identify patterns and insights that humans may miss. In the field of medicine, this could mean personalized treatment plans based on a patient’s unique genetic makeup and medical history. Doctors could use Machine Learning algorithms to predict which treatments

will work best for each patient, minimizing the risk of adverse effects and improving outcomes.
AI-Assisted Creative Workflows
AI is not just for data crunching; it’s also capable of assisting in creative workflows. Designers and artists can use AI tools to generate new ideas and explore different styles and aesthetics. AIpowered tools can also help speed up tedious processes like colour correction and image tagging, freeing up time for artists to focus on more creative tasks.
Autonomous Decision Making in Business
Businesses can use AI and ML algorithms to make more informed decisions based on data analysis. For example, AI could analyze customer data to predict which products will be popular, or to optimize pricing and promotions based on buying patterns. This could lead to more efficient and profitable business models in the future.

2. The rise of the Internet of Things (IoT) and its impact
The Internet of Things (IoT) refers to the interconnected network of physical objects, devices, and sensors that can communicate with each other and exchange data.

Here are a few ways IoT is set to make an impact in the next decade:
The Future of Smart Homes
Smart homes are already becoming more common, with connected devices like smart thermostats and voice assistants gaining popularity. In the future, we can expect homes to become even more intelligent, with everything from kitchen appliances to lighting and security systems connected to a central hub and controlled through our smartphones.
IoT in Agriculture and Farming
IoT can be a game-changer in agriculture, helping farmers to optimize crop yields and reduce waste. Sensors can be used to monitor soil moisture levels, detect pests and diseases early, and automate irrigation and fertilization. This can help improve efficiency and reduce the environmental impact of farming.
Industrial Internet of Things (IIoT) and Smart Manufacturing
IoT is also set to transform the manufacturing industry, with factories becoming more automated and intelligent. IIoT can help improve efficiency and reduce downtime by using data analytics and AI to predict equipment failures before they happen. This could lead to more efficient supply chains and more sustainable manufacturing practices.
3. Advancements in Quantum Computing and its potential applications
Quantum Computing is a relatively new field that uses quantum mechanics to perform computations more efficiently than classical computers.

The Google Quantum Computer
Here are a few potential applications for quantum computing in the next decade:
Quantum Computing in Cybersecurity
Quantum Computing has the potential to revolutionize cybersecurity, with the ability to break some of the most common encryption methods used today. However, it also has the potential to make encryption more secure, with quantum-resistant algorithms being developed to protect against this new threat.
Quantum Machine Learning and Optimization
Quantum Computing can also be used to optimize processes more efficiently than classical computing. Machine Learning algorithms could be used to analyze vast amounts of data and identify patterns that would be impossible for classical computers to find.
Quantum Computing in Drug Discovery
Quantum Computing could also have a profound impact on drug discovery, with the ability to simulate complex chemical reactions and predict the effectiveness of potential drugs. This could lead to more efficient drug discovery and treatment methods for complex diseases like cancer.
4. Augmented and Virtual Reality developments in various industries
Augmented Reality (AR) and Virtual Reality (VR) technologies have been around for a while but are becoming more mainstream and affordable.


Here are a few areas where AR and VR are set to make an impact in the next decade:
AR and VR in Education and Training
AR and VR can be used to create immersive learning experiences that can help students better understand complex concepts. For example, students studying anatomy could use AR to visualize the human body and interact with it in a more hands-on way.
AR and VR in Healthcare
AR and VR can also be used in healthcare to provide more personalized treatment plans and improve patient outcomes. Surgeons could use AR to overlay virtual models of organs onto a patient’s real body, improving accuracy and reducing the risks associated with surgery.
The Future of AR and VR in Retail and Entertainment
AR and VR are already being used in retail and entertainment to create more immersive shopping experiences and games. In the future, we can expect these technologies to become even more advanced, with virtual storefronts and immersive game worlds that blur the line between reality and fiction.
5. The future of autonomous vehicles and smart transportation systems

Here are a few areas where autonomous vehicles and smart transportation systems are set to make an impact in the next decade:
Self-Driving Cars and the Future of Mobility
The era of self-driving cars is almost upon us, and it’s set to revolutionize the way we travel. Automation in transportation will reduce the number of accidents caused by human error, increase mobility for those who are unable to drive, and improve traffic flow. In the next ten years, we can expect to see more autonomous vehicles on the roads, from self-driving taxis to long-haul trucking.
Smart Cities and Transportation Infrastructure
As the population grows, the demand for efficient transportation will only increase. Smart cities will emerge with transportation systems that use data to optimize traffic flow, reduce congestion, and improve safety. In the next decade, we can expect to see major investments in transportation infrastructure, such as smart traffic lights and connected vehicle systems.
The Potential Impact of Autonomous Vehicles on Society
The widespread adoption of autonomous vehicles will have a profound impact on society, from reducing the number of traffic accidents to changing the way we work and live. Cities will be able to reclaim space previously used for parking, and people who are unable to drive will have greater mobility. However, the transition to autonomous vehicles will also have significant economic and social implications, and it’s important to address these issues as we move forward.
6. Biotechnology and Bioengineering breakthroughs in healthcare

Here are a few areas where Biotechnology and Bioengineering are set to make an impact in the next decade:
Gene Editing and CRISPR Technology
Recent advances in gene editing and CRISPR technology have opened up the possibility of curing genetic diseases, such as sickle cell anemia and cystic fibrosis. The ability to modify DNA will also have numerous

applications in agriculture and environmental conservation. In the next ten years, we can expect to see more breakthroughs in gene editing, which will have a significant impact on healthcare and the broader world.
3D Printing in Healthcare
3D printing has already transformed manufacturing, but in the healthcare industry, it’s set to revolutionize the way we approach patient care. The ability to print organs, prosthetics, and other medical devices will improve patient outcomes and reduce costs. In the next decade, we can expect to see more widespread adoption of 3D printing in healthcare, as the technology continues to improve and become more affordable.
Nanotechnology for Disease Diagnosis and Treatment
Nanotechnology is another field that’s rapidly advancing, with potential applications in medicine. By developing nanoparticles that can target cancer cells or deliver drugs to specific parts of the body, we can improve the effectiveness of treatment and reduce side effects. In the next ten years, we can expect to see more research and development in this area, as researchers work to harness the power of nanotechnology for disease diagnosis and treatment.
7. Sustainability and Clean Energy innovations for a greener future

Here are a few areas where Sustainability and Clean Energy innovations are set to make an impact in the next decade:
Solar and Wind Power Advancements
Clean energy sources like solar and wind power are already making significant contributions to reducing greenhouse gas emissions. In the next ten years, we can expect to see further advancements in
renewable energy technology, such as improved battery storage systems and more efficient solar panels. This will continue to drive down the cost of renewable energy and make it more accessible to consumers.
Smart Grid and Energy Storage Technologies
As more renewable energy sources come online, the need for better energy storage and distribution will increase. Smart grid technology can help manage energy demand and supply, while energy storage systems can provide backup power during outages. In the next decade, we can expect to see more investment in these areas, as we work towards a more sustainable and resilient energy system.
Green Building Materials and Sustainable Urban Design
The construction industry is a significant contributor to greenhouse gas emissions, but advances in green building materials and sustainable design practices are set to change that. Buildings that are designed with energy efficiency and sustainable materials in mind will reduce energy consumption and waste, and improve indoor air quality. In the next ten years, we can expect to see more adoption of green building practices, as we work towards a more sustainable future. The next decade is poised to be an exciting time for technology and innovation. With advances in artificial intelligence, quantum computing, biotechnology, and clean energy, we can expect to see a world transformed in ways we cannot yet imagine. As we look forward to the future, it is important to recognize the potential benefits and challenges that come with these emerging technologies, and to work towards leveraging them for the greater good. Ultimately, the future is in our hands, and it is up to us to shape it in ways that benefit humanity and the planet as a whole.
What are some of the ethical and societal implications of these emerging technologies?
Emerging technologies such as AI, IoT, and biotechnology raise important ethical and societal concerns, such as privacy, security, bias, job displacement, and access to healthcare. As these technologies continue to evolve and impact our lives, it is important to have conversations and policies that address these issues and ensure that the benefits of these technologies are shared by all.


Further Mathematics
by Dr Darren Laffar, HPL coordinator and Teacher of Further Mathematics
“Remember you must first use the properties for the roots of the polynomials to find the solution”.
Lucas, Simon and Tony looked at the problem and realised what was needed. They continued to battle on, concentration apparent on their faces…
In the last five years, it has been an honour to teach the gifted mathematicians in year 13 the Further Mathematics A-level. This is, without a doubt, the most challenging course that Cambridge have to offer (and it is one of the most difficult courses in the world). This year though, I am delighted to say that we are offering Further Mathematics as a full 2-year A Level course (previously, it was open to just “fast track” pupils who entered the A-level mathematics course a year early), running consecutively alongside the standard A Level Mathematics course.
The year 12’s have all clearly thoroughly enjoyed the course and the challenges it brings, exploring areas of mathematics that test them to their limit.



Moreover, watching an IBSB pupil rise to the challenge and take something on against the odds has also inspired me as a teacher. It is wonderful when something like this happens, and I am glad I am working at a school that gives pupils the opportunity to do this.
The current year 13’s are the last of the “fast track” pupils completing the course in one year, which takes an extreme amount of dedication. Congratulations must therefore go to Haiming Luo, Maria Sticlea, Si-Cheng Wu, and Andrei Vernon for staying with it and completing the course.
Further Mathematics has a huge benefit to university applications as many universities recognize the difficulty of the course. Indeed, one of the year 13’s even had their required entry grades reduced as a consequence of the fact that they were studying further mathematics.
For next year, I am looking at the possibility of running an “Oxford and Cambridge entrance exam” course during club time for pupils that wish to apply to Oxbridge. Now this will be challenging!




The Everlasting Power of Creativty
by Carola Canale and Malina Stoica (Year 7R)Whether it’s laying down colours on a canvas, gingerly caressing the strings of a guitar, or passionately using your movement and clear voice to tell a story, creative arts are truly life-changing.
At any moment, you can be seized by the urge to sing out loud, or take a paintbrush and fill in a blank piece of paper, to turn nothing into something. It is the moment you discover your inner creativity. And just like that, after a while, the desire to paint, sing, or act and the happiness and freedom that comes from doing it, twist together and bloom beautifully into what is called your passion.
In the Creative Art Department at IBSB, the aim is to create a special place and atmosphere that allows us to put all of our thoughts and feelings into marvellous artwork. We are provided with all the necessary equipment, but most importantly, the ambiance is what we need the most to allow us to extract simple ideas, turning them into something revolutionary.
The people who guide us through the intriguing path of creativity are: Ms Evi in music, Ms Long in art, and Mr Mujica in drama. They are the leaders of the arts at IBSB. They are the people who help us unlock the doors that unleash the sheer power of transforming our ingenuity and self-expression into artworks that become masterpieces. We have interviewed them to discover their perspectives on creative arts.
Q: From all of the projects you and your classes have completed this year, which one was your favourite?
A: I particularly enjoyed making the ceramic periodic table. Every student made an element and then when all were completed, we put them together for a mind-blowing result! I think that what made this project special is the fact that we could mix multiple subjects together, the main ones being art and science.

Ms Long (Art)
Q: How open do you think creative arts teachers are at IBSB?
A: In my opinion, the students at IBSB are really lucky to have teachers that are so open and that allow them to express their creativity without frontiers.
Q: Why did you decide to become an art teacher?
A: I find working with children delightful! Their energy gives me a boost of inspiration and I always feel like I can relate to the way they think.

Q: What was your favourite project that you, together with your students, have completed this year?”
A: My favourite project was the monologues that the year 7s completed as I got to see the real talent of each individual student.
Q: How do you think drama helps students express themselves?
A: I think drama helps them to express emotions that they are not allowed to express anywhere else because they feel safe in an environment where they are not judged.



Q: From all of the projects that together with your students you have completed this year, which one was your favourite?”
A: My favourite project was when the year 7s had to create their own piece of music. I also enjoy it when students take part in the song writing competition, because they are finally able to use their creativity in a competition, and I was really happy to see how many of them took part in it this year.
Q: Why do you think creative arts are so important?
A: Creative arts are important because they teach people life skills. They allow you to explore the phenomenal gift of creativity and express yourself, while also building up confidence.
Q: What is special about music in your opinion?
A: Music is everywhere. It’s there in nature, in the beating of our heart, in the rhythm of ocean waves. It’s inside of us. And the amazing thing is that our brain has the capability to recognise this music and transform it, to create lasting memories of feelings and stories.
As all three teachers believe there is one thing in common between all creative arts: they all offer an opportunity for people to lose themselves in special worlds where anybody, no matter gender, nationality, or age, can express themselves and feel at peace with who they truly are.

Our belief is that the arts will always be there. We are in an era of big changes, but some things will stay the same: the need for creativity, inventiveness, intuition, and visionaries. Robots might be able to complete calculations, create formulas, and one day, perform surgical operations on humans, but they will never be capable of feeling, sensing, or imagining like humans.
Creative Arts is about our opinion, and how we feel things should be. Creative Arts allow us to express our emotions and free ourselves: there are no borders when thinking about who you are, and who you want to be. From emotions shown in oil paintings, to confidence when delivering your speech, and performing music pieces that drag you from sensation to sensation, from excitement to sadness to happiness, creative arts can transform into whatever you want! We would be nothing without our glorious dreams and unique perspectives.
Keep creating and never give up on what is the spectacular power of creative arts!





In the Realm of Hungry Ghosts – by Gabor Maté
Book Synopsis
by Antonia Gradinariu (Year 13)The book In the Realm of Hungry Ghosts by Gabor Maté takes a deep dive into the minds and behaviors of addicts and gives some insight into what triggers addiction. Maté does so without glamorising or demonising people with a drug dependency, making this work a must-read for anyone studying psychology or medicine.
Maté shows the emotional and physical hardships experienced by addicts, which lead them to dependence; this disorder has many layers and cannot be boiled down to one “cause-effect” relationship. The author explains the multiple ‘triggers’ for addiction - in all the cases described, different unresolved underlying problems could be identified as contributing to the person’s route to addiction. Maté also focuses on the developmental causes of dependence, making sure to illustrate how a child’s development can affect their susceptibility to addiction. While exploring the ‘ugly parts’ of addiction, the book also highlights the creativity and potential that addicts have, but rarely find means of expression. Maté acts as a conveyor for those who do not have a voice of their own and sheds light on the wonders addicts could bring into the world if only their situation were different.
Maté shows how demanding it is to treat someone with addiction, despite their numerous health problems associated with drug abuse such as AIDS, hepatitis or ulcers, addicts are driven by their drugs, and under no circumstances will they quit their pursuit of the substance that makes them feel “whole”. The author recounts the difficulties he faced when attempting to help those with addictions to drugs such as methamphetamines, heroin and opiates; it is clearly challenging to help and treat people dependent on a substance that will undoubtedly kill them. One conclusion to be drawn would be that people with drug dependencies are among the most difficult patients to treat because they are the most likely to have suffered with underlying mental disorders for most of their lives, and are using the drugs as a form of self-medication. They

could not get the psychological support they needed, and therefore turned to substance use to deal with anxiety, depression and even ADHD.
In the Realm of Hungry Ghosts details how the rehabilitation system is also at fault for the number of addicts who do not get help; the system is underfunded and usually addicts do not access rehab because of legitimate fear of reprehension. This links to the effects of the ‘War on Drugs’ policies as well, which Maté does not agree with because he believes that criminalising all drugs will only make them more dangerous, not less accessible. The author supports the decriminalisation of drugs, a view that is becoming more common nowadays, showing that the harsh decisions made in the 1970s to imprison drug abusers may not have been the smartest and most conscious decision.
This book looks at addiction from all angles in order for the reader to comprehend the subject completely; it shows heartbreaking ‘mini case studies’ of different addicts that Maté has tried to treat, and scientific proof of every statement made. I warmly recommend this well-documented and compassionate account if you have an interest in the biological, psychological and social factors influencing addiction.

The Psychopath Test - by Jon Ronson
Book Review
by Ana Mihaescu (Year 12)This summer, I occupied my free time reading a bunch of different novels, including genres of romance, adventure and fantasy, but none of them has captivated me more than Jon Ronson’s striking social psychology book, “The Psychopath Test”.
“A Journey through the Madness Industry” is the book’s subtitle and an accurate way to describe this book. As a person who is interested in studying criminal psychology in the future, I picked it out from a list of different psychology books, with the intention of finding out more about how devious minds work; that being only a minor aspect of what the book reveals. Jon Ronson touches upon the subjects of mental disorders detailing aspects related to schizophrenia and bipolar disorder, while also explaining the ways in which psychopaths can be identified and how they are able to successfully blend into communities. It was fascinating to explore why and how a psychopath turns into a vicious serial killer. It was equally interesting to find out how people with psychopathic traits are able to contain their personality disorder and live normal lives among us. Admirably, Ronson is very successful at combining the unsettling and blood-curdling nature of such subjects with the occasional use of comedy that lightens up the mood. Through his story and interviews with specialists or alleged psychopaths, we grow increasingly intrigued to find out about how the human mind works, and how psychopathy affects it.
I ended up being particularly interested in the daunting interviews with the few murderers who Ronson was able to contact, as they provided a different view that challenged my expectations about the reasons why these people committed murders. You will also find some captivating stories of people who faked their mental disorders in order to escape laws, by pleading guilty reason insanity, and about people who were able to challenge the great

minds of criminal psychologists for a long time. What makes it more disturbing is learning about how most psychopaths are just everyday people, sometimes very successful in their jobs, or holding high status positions, perhaps the people you would least expect.
I would definitely recommend this book to anyone who is interested in social psychology, politics or the business world, as it allows insight into how psychopaths are able to infiltrate and rise to the top of any kind of social group, corporate or not. Prepare yourself to get absorbed into Ronson’s series of spine-chilling events.

The Growing Role of Artificial Intelligence in Medicine: Implications for Medical Education
by Andrei Stere (Year 12)Artificial Intelligence (AI) is revolutionizing the field of medicine, transforming the way healthcare is delivered and leading to improved patient outcomes. With its ability to analyze vast amounts of data, recognize patterns, and make accurate predictions, AI is becoming an essential tool for healthcare professionals. As the adoption of AI in medicine continues to rise, its implications for medical education are becoming increasingly significant. This article explores the growing role of AI in medicine and discusses its implications for medical education.
AI in Diagnosis and Treatment
One of the most prominent applications of AI in medicine is its role in diagnosis and treatment. AI algorithms can analyze medical images, such as X-rays, CT scans, and MRIs, with remarkable accuracy, aiding in the detection and classification of diseases. By analyzing patterns and comparing data to multiple databases, AI systems can assist in diagnosing conditions faster and with higher precision than human doctors alone.
Furthermore, AI can suggest optimal treatment plans based on patient-specific data, scientific research, and clinical guidelines. These systems can analyze large amounts of patient data, identify trends, and offer personalized treatment recommendations. This capability allows healthcare professionals to make more informed decisions, leading to improved patient outcomes and reduced medical errors.



Enhancing Medical Education with AI
The integration of AI into medical education has the potential to transform the way future healthcare professionals are trained. By incorporating AI tools and technologies, medical education can become more personalized, interactive, and data-driven. Here are some implications of AI in medical education:
Data-driven Learning: AI can process large volumes of medical data, including clinical cases, research papers, and treatment guidelines, to identify patterns and generate valuable insights. Medical students and residents can benefit from AI-driven platforms that provide personalized learning paths, tailored recommendations, and real-time feedback, enabling them to enhance their knowledge and skills efficiently.
Simulation and Virtual Reality: AI-powered simulations and virtual reality (VR) can create realistic and immersive medical scenarios for training purposes. Medical students can practice complex procedures, surgical techniques, and patient interactions in a safe and controlled environment. AI algorithms can provide instant feedback and analysis, allowing students to refine their techniques and improve their decision-making skills.
Clinical Decision Support: AI systems can serve as intelligent clinical decision support tools, assisting medical students and healthcare professionals in making accurate diagnoses and treatment decisions. By accessing patient data, medical history, and the latest research, AI algorithms can provide evidence-based recommendations, helping students to develop critical thinking skills and stay updated with the latest medical advancements.
Ethical Considerations and Humanistic Training: As AI becomes more prevalent in healthcare, medical education needs to address the ethical implications and humanistic aspects associated with its use. Educators should emphasize the importance of empathy, patient-centered care, and the ethical considerations of using AI in clinical decision-making. Training future healthcare professionals to collaborate effectively with AI systems while maintaining a compassionate and ethical approach is crucial.
Challenges and Considerations
While the integration of AI in medical education brings numerous benefits, it also poses certain challenges. These challenges include concerns about data privacy and security, potential bias in algorithms, the need for regulatory oversight, and the ethical implications of relying on AI systems for patient care. Medical institutions and educators must address these challenges by incorporating appropriate safeguards, emphasizing ethics education, and promoting transparency and accountability in the use of AI technologies.
Lastly, artificial intelligence is rapidly transforming the field of medicine, providing unprecedented opportunities to improve diagnosis, treatment, and patient care. The growing role of AI in medicine has significant implications for medical education. By integrating AI tools and technologies, medical education can be enhanced, enabling personalized learning, simulation-based training, and data-driven decision-making. However, it is crucial to address the challenges and ethical considerations


Why you should get a dog
by Sandra Curtis (Year 9E)
Dogs are the most popular pet in the world. Over 470 million dogs are kept as pets around the world. With their large eyes, soft fur, and loving personalities, dogs are just plain adorable and irresistible. In this article, I will be showing you the reasons why you should get a dog.
Dogs reduce stress
Your canine companion can offer comfort and ease your worries. Multiple studies have revealed dogs help people cope with stress and anxiety. Even just petting a dog lowers blood pressure, slowing the heart rate, relaxing breathing and muscle tension. Scientists at Washington State University have discovered that just 10 minutes of petting a dog can have a significant impact on your general state of health.
Dogs are good for your heart
Owning a dog can help you live longer. Multiple studies published between 1950 and 2019 found that dog owners had a lower risk of death due to heart diseases related illnesses. Studies suggest that dog owners have lower blood pressure levels and improved responses to stress.
Dogs help you to feel less alone
Dogs can be there for you even when people can’t. They offer unconditional love, emotional support, and constant cuddles. An Australian Study discovered that dog ownership reduces loneliness.
Dogs encourage you to get more exercise
A 2019 British Study discovered that dog owners are nearly four times more likely than non-dog owners to meet their daily physical
activity goals. It is recommended that you should walk your dog 3 – 4 times per day for at least 15 minutes. Dog owners spend nearly 300 minutes every week walking with their dogs. That’s 200 more minutes walking than people without a pup of their own.
Dogs make us more social
Walking with a canine companion can make us more approachable and offer people a conversation starter. Think about how many times you’ve talked with other people about pets, whether they’re your neighbours or new friends at the dog park. Researchers have found that about 40% of dog owners had an easier time making friends than people that don’t own dogs: these adorable animals are a very efficient way to make new friends. A study at the Cummings School of Veterinary Medicine at Tufts University has also indicated that people who have a strong relationship with their pets feel more connected in their human relationships and their communities.
Dogs make us happier
Just looking at a dog can lift your spirits: a 2009 study in Japan found that staring into your dog’s eyes raises your level of oxytocin, also known as the “love hormone.” Along with the many health benefits of owning a dog, they are natural mood boosters.
As you can see, there are lots of health and emotional wellbeing benefits that come with owning a dog, which is why you should consider adopting one, as they will change your life for the better. The Bruno Shelter has a lot of dogs in need of a home, so you could consider going there to adopt one. Even if you don’t plan on getting a dog, you can still visit and help out with the dogs.

Year 9L

9L started with 18 pupils along the way we ended up with 3 more pupils joining us; Ariana, Teodora and David.



Felix was voted to be the representative on the student executive and he, along with Irina and Andrei were heavily involved in the middle-school debate team where thery achieved great success.
Lucian won two prizes on awards evening – the IBSB middle-school award and the year 9 HPL award and also managed to get 250 praise points!
Irina also won the sporting excellence award for her amazing achievements in equestrian this year.
Well done 9L and I hope for another great year next year!

An Internship at the Bucharest Stock Exchange
by David Kiiovschi (Year 12), Senior PrefectA student’s future professional path is significantly shaped by their internships, which offer invaluable real-world experience and exposure. Getting practical experience at a stock market is an unrivalled opportunity for any student to get a grasp onto the ever-growing world of finance. This article will follow my journey on a one-week internship at the Bucharest Stock Exchange (Bursa de Valori București).
The first day of the internship began with an introduction to the BVB’s history, role, and function within the national and international financial landscape. I was then assigned a short research project about the process through which state-owned companies must go through when they get listed on the stock market, and about the discrepancies of the rate at which individuals invest in the stock market across the European Union.
The following day, I dove into the world of market dynamics, building on the first day’s foundation. As a result of my interactions with analysts and traders, I gained knowledge about market trends, liquidity, and the variables affecting stock prices. Furthermore, developed an in-depth understanding of investment strategies and decision-making processes by gaining insights into technical analysis, fundamental analysis, and risk assessment.
The fourth and fifth days of the internship concentrated on the crucial function that technology plays in stock exchanges as it continues to revolutionise the financial industry. I gained knowledge of the market surveillance tools and electronic trading systems that support efficient and open trading. I also looked into tax regulations regarding profits made from dividends or from selling shares at the stock exchange, and how countries have worked together on treaties, which avoids double taxation for international traders.

The one-week internship at the Bucharest Stock Exchange proved to be an exciting experience that not only provided me with a glimpse into the daily operations of a stock exchange, but also equipped me with practical experience and a better understanding of market dynamics. I thoroughly recommend that any high school student takes on such programmes, as they can help develop useful skills which are applicable to a vast number of fields.


Art Fraud
by Rucsandra Curtis (Year 9)Art fraud is the false representation of the artist, age, origins or ownership of a work of art. It is done deliberately, in order to get some sort of profit from it. From forged masterpieces to misrepresented artworks and fraudulent art market schemes, art fraud undermines the authenticity, value, and trust within the art market. The consequences extend beyond financial losses, often ruining the reputations of artists, galleries, and institutions. This article will discuss the different types of art fraud, famous cases of it, and how it is detected.
History of art fraud
Art forgery dates back for more than two thousand years. For example, Ancient Roman sculptures would produce copies of ancient Greek sculptures. The contemporary buyers likely knew that they were not genuine, but still bought them anyway because they liked how they looked and didn’t really care about the identity of the artist(s).
The notion of intellectual property—the idea that artists’ works belong to them—dates at least back to medieval Europe, although history records examples of the concept as early as ancient Greece. It took hold sufficiently during the Renaissance for Michelangelo to take his work back when his work was misattributed. It was reported that when he discovered that another artist was receiving credit for sculpting the famous Pietà (which is currently in St. Peter’s Basilica in Rome), Michelangelo returned with his chisel and added his signature across the center of the sculpture, on the prominent sash across Mary’s upper body (in Italian): “Michelangelo Buonarroti, Florentine, made this.”
In the 18th and 19th centuries, the trend of an interest in classification and studying the past resulted in an uprising in forgeries as the art market adjusted to accommodate the new interest in the artistic past. That interest in the classification of the past also led to the founding of academic disciplines such as the history of art. The study of art history and the creation of agreedupon bodies of work for artists and eras, as well as advances in

science, made possible in the 20th century the winnowing out of forgeries, fakes, and misattributions from authentic works. As art historians gained more knowledge about the past and the styles, materials, and working conditions of artists and historical epochs, inauthentic and fraudulent works were more readily exposed.
Types of art fraud
Forgery of a famous artist’s work of art is the most common type of art fraud,
One of the most common types of art fraud is the forgery of famous artworks. There are three varieties of art forgers; The person who actually creates the fraudulent piece, the person who discovers a piece and attempts to pass it off as something it is not, typically in order to increase the piece’s value, and the third who discovers that a work is a fake, but sells it as an original anyways to gain a profit.

An art forger must be at least somewhat proficient in the type of art he is trying to imitate. Many forgers were once fledgling artists who tried, unsuccessfully, to break into the market, but since they weren’t very successful, they had to resort to foraging artworks in order to make a living. Sometimes, an original item is borrowed or stolen from the owner in order to create a copy. The forger will then return the copy to the owner, keeping the original for himself. An example of this happening is in 1799, when a self-portrait by Albrecht Dürer which had hung in the Nuremberg Town Hall since the 16th century was loaned to Abraham Wolfgang Küfner. The painter made a copy of the original and returned the copy in place of the original. This forgery was later discovered in 1805, when the original came up for auction and was purchased for the royal collection.
Some art foragers will also pretend that a piece of art is older than it actually is. For example, an art dealer could lie that a statue was from Ancient Greece or that a wave was from China’s Ming Dynasty, just so that they could get more money, since artifacts from those times are extremely valuable.
In the old times, it was not uncommon for replicas of famous art pieces to be in demand. For example, the bronze Spear Bearer (450 - 445 BC) by Greek Sculpture Polyclitus, for example, was very well known for its seemingly perfect proportions and beauty. As a result, it was often copied in marble for Roman collectors in subsequent centuries. The copies have all survived into the 21st century, but we are aware that none of them are the original sculpture.
In the 18th and 19th centuries, the trend of an interest in classification and studying the past resulted in an uprising in forgeries as the art market adjusted to accommodate the new interest in the artistic past. That interest in the classification of the past also led to the founding of academic disciplines such as the history of art. The study of art history and the creation of agreedupon bodies of work for artists and eras, as well as advances in science, made possible in the 20th century the winnowing out of forgeries, fakes, and misattributions from authentic works. As art historians gained more knowledge about the past and the styles, materials, and working conditions of artists and historical epochs, inauthentic and fraudulent works were more readily exposed.
Although many art forgers reproduce works solely for money, some have claimed that they have created forgeries to expose the credulity and snobbishness of the art world. Essentially the artists claim, usually after they have been caught, that they have performed only “hoaxes of exposure”.
Certain art dealers and auction houses have been alleged to be overly eager to accept forgeries as genuine and sell them quickly to
turn a profit. If a dealer finds the work is a forgery, they may quietly withdraw the piece and return it to its previous owner—giving the forger an opportunity to sell it elsewhere.
Art fraud extends beyond the forgery of famous artworks. Another form of art fraud involves the misrepresentation of artworks, where deceptive practices are employed to sell counterfeit or misrepresented pieces. In such cases, unscrupulous individuals may create fake artworks, imitating the style of renowned artists or producing artworks falsely attributed to well-known creators. They capitalize on the demand for certain artists or art movements, taking advantage of the desire of collectors to own valuable and historically significant pieces. Furthermore, art fraudsters may manipulate provenance and authentication records, providing false documentation to lend credibility to the misrepresented artwork. By intentionally misrepresenting the origins, authenticity, or value of artworks, these fraudsters prey upon unsuspecting buyers and undermine the trust and transparency that are crucial to the art market.
Some forgers have created false paper trails relating to a piece in order to make the work appear genuine. The British art dealer John Drewe created false documents of provenance for works forged by his partner John Myatt, and even inserted pictures of forgeries into the archives of prominent art institutions. Experts and institutions may also be reluctant to admit their own fallibility. Art historian Thomas Hoving estimates that different types of forged art comprise up to 40% of the art market though others find this estimate to be ridiculously high.
Art market scams often involve fraudulent practices by art dealers and galleries, which exploit the collector’s desire to own rare or investment-worthy artworks. In some cases, fraudulent art investment schemes are created, promising returns on art purchases or investments. Some dishonest individuals may convince unsuspecting buyers to invest in artworks that are misrepresented in terms of their value. Such scams can lead to significant financial losses for investors who fall victim to them. Additionally, untrustworthy art dealers and galleries may engage in unethical practices, such as selling counterfeit artworks or misrepresenting the authenticity and condition of pieces to unsuspecting buyers.
Motivations behind art fraud
One of the most common motivations behind art forgery is financial gains. Since a lot of artworks cost a lot, particularly those attributed to famous artists, fraudsters see an opportunity to exploit the market. By creating convincing forgeries or misrepresenting

artworks, they aim to trick buyers and collectors into paying exorbitant sums for counterfeit or falsely valued pieces. The potential profits derived from successful art fraud can be staggering, incentivizing individuals to engage in these deceitful practices.
Some art fraudsters are driven by their own ego and the thirst for fame and recognition. They aspire to create pieces that are admired and celebrated, even if it means falsely attributing them to famous artists or copying their styles. By passing off their creations as original works of renowned artists, they seek validation and acclaim from the art world, attempting to fool critics, experts, and the public in the process.
Art fraud can also be motivated by a desire to challenge the authenticity and reputation of established artists. In some cases, individuals with grudges or vendettas against specific artists may attempt to create fake artworks in the style of those artists, aiming to cast doubt on the legitimacy of their body of work. By introducing doubt and controversy, they undermine the trust placed in the artist’s authenticity, potentially ruining their reputation and market value.
Art fraudsters may target specific artists or artworks with the intention of weakening their market value. By flooding the market with counterfeit or falsely attributed works, they can dilute the demand and decrease the perceived rarity of genuine pieces. This manipulation can have far-reaching consequences, affecting the livelihoods and reputations of artists and impacting the overall dynamics of the art market
How is art fraud detected?
Modern inventions can help with the detection of art fraud. The detection of art fraud involves advanced scientific techniques and the expertise of art historians. Methods such as radiocarbon dating, spectroscopy, and microscopic examination can help experts analyze artworks in detail to determine whether they’re authentic or not.
Art historians with experience play a very important role in spotting inconsistencies and comparing artworks to known authentic pieces. Their extensive knowledge of art history, artists’ styles, and techniques help identify forgeries or raise suspicions regarding misrepresented artworks. By combining scientific advancements with the sharp eye of experts, the art world can better detect and expose fraudulent practices, protecting collectors and investors from falling victim to art fraud.
Famous cases of art fraud
One notorious case of art fraud was when New York art gallery M. Knoedler & Co. sold $80 million of fake artworks claimed to be by Abstract Expressionist artists between 1994 and 2008. During this time, Glafira Rosales brought in about 40 paintings she claimed were genuine and sold them to gallery president Ann Freedman. Claimed to be by the likes of Mark Rothko and Jackson Pollock, the paintings were all, in fact, forgeries by Pei-Shen Qian, an unknown Chinese artist, and mathematician living in Queens, New York. In 2013, Rosales entered a guilty plea on charges of wire fraud, money laundering, and tax evasion. In July 2017, Rosales was ordered by a federal judge to pay US$81 million to victims of the fraud. Pei-Shen Qian was indicted but fled to China and was not prosecuted. The final lawsuit connected with the case was settled in 2019. The case had a Netflix documentary made about it called “Made You Look: The True Story About Fake Art”. It was released in 2020.
Another famous case of art fraud was done byHan van Meegeren (1889-1947). He was a mid-level Dutch artist with a penchant for a naturalistic and realistic style in a time when avant-garde movements were commonplace. It is easy to see why the art critics were not enthusiastic about his work; they recognized his technical talent but found no sign of originality. Out of spite and driven by the desire to humiliate those critics, van Meegeren began to deceive them.
Van Meegeren successfully created and sold numerous paintings attributed to famous Dutch Golden Age artists, such as Johannes Vermeer. His most notable forgery was “The Supper at Emmaus,” which he presented as a newly discovered Vermeer masterpiece.
Van Meegeren very thoroughly studied the techniques, style, and materials used by Vermeer to create his forgeries. He even aged the paintings using various methods to make them appear older than they really were. His creations tricked art experts, collectors, and critics, including renowned art historian Abraham Bredius, who declared “The Supper at Emmaus’ ‘ as a genuine piece by Vermeer.
However, van Meegeren’s career as a forger ended after World War II, when he was arrested for collaboration with the Nazis. It was then when van Meegeren revealed his secret life as a forger and offered to prove his guilt by creating another forgery. He painted a new Vermeer-inspired artwork under police supervision, demonstrating his abilities.

The case attracted international attention, exposing the vulnerabilities of the art world to forgery. Van Meegeren’s trial became a spectacle, and his confessions shed light on the flaws in art authentication processes. Despite his criminal acts, van Meegeren’s forgeries are now considered masterful artworks in their own right, with some of his works displayed in museums as examples of art fraud and the skills that these foragers possess.
Negative impacts of art fraud:
Art fraud has widespread consequences besides financial losses. It messes up the reputation of artists, galleries, and experts while destroying trust within the art market.
Financially speaking, art fraud leads to significant loss of money for collectors and investors who unknowingly acquire bogus or misrepresented artworks. The reputations of artists falsely attributed to false works may suffer, casting doubt on all of their hard work. Galleries and experts involved in fraudulent practices face scrutiny and lose credibility in the art world.
Most importantly, art fraud undermines trust within the art market. It creates doubt regarding the genuineness and value of artworks, making it challenging for honest artists and sellers to gain credibility. This loss of trust hampers the growth and stability of the art market as a whole.
Conclusion:
From all of this we can conclude that although it is very interesting to read about, art fraud is a problem that threatens the integrity of the art world. From forged masterpieces to misrepresented artworks and fraudulent market schemes, the consequences of art fraud extend beyond financial losses. Detecting and preventing art fraud requires the collaboration of experts, scientific advancements, and stringent regulations. By raising awareness, promoting transparency, and encouraging ethical practices, authenticity, value, and trust can be preserved within the art market. Continued caution and a collective commitment are necessary to protect artists, collectors, and the cultural heritage that art represents.


Celebrating Cultural Diversity: Embracing the Richness of Our School Community
by Andrei Stere (Year 12)In our increasingly interconnected world, cultural diversity has become a defining characteristic of modern society. At IBSB, we take pride in fostering an inclusive environment that celebrates and values the cultural diversity within our student body. In this article, we will explore the importance of cultural diversity in schools and highlight the ways in which our school embraces and promotes this invaluable asset.
I would say that our school is a vibrant tapestry of cultures, representing students from various ethnic, religious, and linguistic backgrounds. Our diverse student body provides a unique opportunity for cultural exchange and learning, allowing students to broaden their horizons and develop a global perspective. By embracing cultural diversity, our school fosters an inclusive environment where students feel valued, respected, and represented.
Why is it important to promote cultural awareness and understanding?
We believe that understanding and appreciating different cultures is crucial for nurturing global citizens. Through our curriculum, extracurricular activities, and events, we actively promote cultural awareness and understanding. Our annual UN days, school performances, and CAS events are just a few examples of how we provide platforms for students to showcase their cultures and educate their peers. This encourages dialogue, empathy, and a deep appreciation for the diverse backgrounds within our school community as well as helping students develop open-mindedness and a broader perspective on the world.

Moreover, cultural diversity at school serves as a catalyst for building bridges of friendship among students. Our school encourages interaction and collaboration among students from different cultural backgrounds, fostering connections and meaningful relationships. Through group projects, student organizations, and shared experiences, students develop lifelong friendships that transcend cultural boundaries. These relationships contribute to a supportive and inclusive school community where diversity is celebrated.
In an era of increasing globalization, embracing cultural diversity prepares students for the interconnected world they will inherit. By exposing students to different cultures, we equip them with the skills and perspectives necessary to navigate diverse environments and work collaboratively with individuals from various backgrounds. This prepares our students to be culturally competent and adaptable, essential qualities for success in the 21st century. Lastly, here at IBSB, we recognize that cultural diversity is not just a mere presence within our school community but a tremendous asset that enriches the educational experience of every student. By celebrating cultural diversity, promoting cultural awareness and understanding, and fostering friendships across cultural boundaries, we create an environment that nurtures inclusivity, empathy, and global citizenship. We are proud to be a school that embraces and cherishes the richness of our diverse community, preparing our students to thrive in a multicultural world.

Summer Holiday
by David Kiioschi (Year 12)The summer holiday is a much-awaited break for high school students. It offers a valuable opportunity to unwind, rejuvenate, and engage in activities that can enhance personal growth and academic development. Instead of idling away the days, students can make the most of their summer break by utilizing their time effectively.
The summer holiday provides an ideal time for students to explore their passions and hobbies. Whether it’s painting, writing, playing a musical instrument, or engaging in a sport, students can dedicate time to develop their skills and nurture their talents. Joining local clubs, workshops, or online communities related to their interests can provide valuable learning experiences and foster personal growth. Students can also gain valuable practical experience by pursuing summer internships or part-time jobs. These opportunities not only provide insights into potential career paths but also help students develop essential skills such as teamwork, communication, and time management. Interning or working in a field of interest allows students to explore their passions and make informed decisions about their future academic and professional endeavors.
In addition, numerous educational institutions and organizations offer summer courses and workshops tailored for high school students. These programs allow students to expand their knowledge, explore new subjects, and gain a competitive edge. Whether it’s a science camp, coding workshop, or creative writing course, summer programs provide an excellent opportunity for intellectual growth and personal development. The summer break should also be a time for high school students to set goals and plan for the upcoming academic year. Reflecting on past achievements, identifying areas for improvement, and outlining personal and academic goals can help students stay motivated and focused. Creating a study schedule, researching colleges or universities, or preparing for standardized tests can give students a head start and reduce stress during the next school year.
To sum up, the summer holiday presents a valuable opportunity for high school students to make the most of their time and engage in activities that foster personal growth and academic development. By pursuing personal interests, volunteering, seeking internships,

enrolling in courses, traveling, and setting goals, students can create a memorable and productive summer break. Embracing these opportunities not only enhances their knowledge and skills but also prepares them for future academic and professional success. So, let this summer be a time of exploration, growth, and self-discovery for all high school students.


Discovering Purpose: A Deep Dive into ‘Man’s Search for Meaning’
by Medeea Constantinescu (Year 13)In a world that often seems chaotic and uncertain, Viktor E. Frankl’s influential work, “Man’s Search for Meaning,” offers profound insights into the human condition. I’ve had this book lying around my house for years, but what really motivated me to pick it up was my dad sending me an interview with David Popovici, in which he claims this book changed his mindset and helped him achieve many of his goals. Published in 1946, this timeless book delves into the depths of human suffering, resilience, and the pursuit of meaning in life. Through his personal experiences in Nazi concentration camps, Frankl provides readers with a profound perspective on finding purpose even in the most harrowing circumstances. Let us embark on a profound journey of self-reflection and existential exploration as we dissect this remarkable literary masterpiece.
Viktor Frankl, an Austrian psychiatrist and Holocaust survivor, shares his personal story in the first part of the book. Through his vivid recollections of the atrocities endured during his time in concentration camps, he demonstrates the indomitable human spirit and our capacity to find meaning, even in the face of unimaginable suffering. Frankl asserts that it is this quest for meaning that differentiates humans from other beings, and it is through this search that we can find purpose and fulfilment.
The Three Pillars of Meaning:
Frankl introduces his fundamental psychological theory, known as logotherapy, in the second part of the book. Logotherapy suggests that the primary motivational force in humans is the search for meaning in life. Frankl explains that meaning can be found through three avenues: work or creative endeavours, love and relationships, and finding meaning in our own suffering. By embracing these pillars, individuals can cultivate a sense of purpose that transcends the challenges they encounter.

Frankl writes, “Ultimately, man should not ask what the meaning of his life is, but rather he must recognize that it is he who is asked. In a word, each man is questioned by life; and he can only answer to life by answering for his own life; to life, he can only respond by being responsible” (Frankl, 1959, p. 122).

This quote encapsulates the essence of Frankl’s philosophy, emphasising the importance of taking responsibility for our existence and finding meaning in the choices we make.
Finding Meaning in Suffering:
One of the most poignant aspects of Frankl’s work is his exploration of suffering and its relationship to meaning. He argues that while we cannot control the circumstances that befall us, we have the freedom to choose our response to them. Frankl illustrates this concept by recounting stories of fellow prisoners who, despite their dire circumstances, found purpose in helping and supporting others. In the face of immense suffering, Frankl writes, “Everything can be taken from a man but one thing: the last of the human freedoms—to choose one’s attitude in any given set of circumstances, to choose one’s own way” (Frankl, 1959, p. 66). Page 66, on which this quote can be found, is the first page that I put a sticky note on while reading this book. Whether we have everything or whether we have nothing, the only thing we truly have and no one can ever take it away from us, no matter if it is life challenges or SS guardians, is the choice of how we react to a situation. This profound realisation highlights the human capacity to transform suffering into a catalyst for personal growth and a deeper understanding of oneself. This really struck me, because it was then I had the realisation : people do not differ by their personality, or their favourite colour or their job; They differ by how they choose to approach what life gives them.
The Power of Attitude and Mindset:
Another key theme in “Man’s Search for Meaning” is the significance of attitude and mindset. Frankl emphasizes that even in the bleakest moments, individuals possess the power to choose their mental
outlook. He asserts that this power lies within the “last of human freedoms” — the ability to select one’s attitude towards any given situation.
Frankl writes, “We who lived in concentration camps can remember the men who walked through the huts comforting others, giving away their last piece of bread. They may have been few in number, but they offer sufficient proof that everything can be taken from a man but one thing: the last of the human freedoms—to choose one’s attitude in any given set of circumstances” (Frankl, 1959, p. 66). This powerful quote serves as a testament to the strength of the human spirit and the transformative power of a positive mindset, even in the face of unimaginable adversity.
Legacy and Contemporary Relevance:
More than seven decades since its publication, “Man’s Search for Meaning” continues to captivate readers of all ages. The book’s relevance persists as it offers invaluable lessons in resilience, existential reflection, and the search for purpose. Frankl’s profound insights have resonated with countless individuals, making it an enduring work in the field of psychology and philosophy.
“Man’s Search for Meaning” is a thought-provoking and deeply profound book that invites readers to contemplate the fundamental questions of human existence. Viktor E. Frankl’s compelling narrative and insightful reflections remind us that, despite life’s inevitable challenges, we have the capacity to create meaning and find purpose. This masterpiece serves as a guiding light, illuminating the path toward a more fulfilling and meaningful life. As we turn the final page, we are left with a renewed sense of hope, reminding us to cherish the inherent beauty and purpose in every moment of our lives.

References:
Frankl, V. E. (1959). Man’s Search for Meaning. Beacon Press.

History Bytes: The Balkan Peninsula
by Vlad Nedelcu (Year 12)New Kosovo-Serbia clashes started in May, worrying the international community that the Balkans will again witness an outbreak of conflict. In the current geopolitical context, when European nations need to act united, that would be the last thing the region needs. Yet, it seems that buried old confrontations resurface time and again, making us seek answers and meaning in history. An ethical melting pot at the crossroads between Western and Eastern civilizations, the Balkan Peninsula has seen its share of conquerors ruling, independence wars, and national identity quests.
Numerous mighty empires have taken their shot at controlling the region, from the Romans to the Ottomans, not to mention the widespread wars Balkan states have waged between themselves. Despite all, one thing remained constant throughout time: the desire of the Balkan people to be the masters of their fate, the desire to be independent. So how exactly did the Balkans succeed? Moreover, what occurred on the road to independence?
The modern state map of the Balkan Peninsula started to be drawn in the period the region was ruled by the Ottoman Empire. The Ottoman Turks first moved into the region in the 15th century. After they conquered Constantinople (modern-day Istanbul), they set their sights on the rest of the Peninsula. While Balkan rulers like Vlad Țepeș, Ștefan Cel Mare, and Gjergj Kastrioti of Albania resisted for a time, the Turkish eventually established themselves as the hegemons of the region. This status quo remained unchanged, up until the 1800s. That’s not to say Ottoman rule was uncontested, as they still had to deal with local resistance, typically in the form of the Hajduks.
Like in the legend of Robin Hood, the Balkan Hajduks were usually portrayed as valiant heroic figures who stole from and often went to battle against the Ottoman authorities. Some notable Hajduks include Starina Novak and Hajduk Veljko of Serbia, Petko Voyvoda and

Deylo of Bulgaria, Iancu Jianu and Pintea Viteazul of Romania, and Nikitas Stamatelopolous from Greece. While most had died without accomplishing their goals, others would continue their fight.
In the 1800s, the idea of nationalism began to take hold within the peninsula, leading to several “national revivals” among the Balkan people. Some concepts emerged at that time, including the Greek Megali Idea, a Greek state holding all land that historically had a Greek population, Yugoslavia, the state of the Southern Slavs, the Greater Bulgarian Empire, and Greater Romania or “România Mare”. These ideas gained traction among the political class and the general population, subsequent steps being taken later on for their implementation.

The first major move came in 1821 when the Greek War of Independence broke out. After a long eight-year war, Greece gained its independence from the Ottoman Empire. It took another 50 years though before seeing major development in the Balkan Odyssey. In 1877-78 the Ottoman and Russian empires partook in one of their many wars. The Balkan states of Serbia, Montenegro, and Romania declared and won their independence during that war, which has been known ever since in Romania as the War of Independence. Bulgaria, on the other hand, was reduced to a mere autonomous province of the Ottoman Empire, although initially briefly gained its independence.
During the joint fight for independence, disagreements were already showing up between the Balkan states, mainly because the many unification projects often overlapped with each other. This led to multiple countries laying claim to the same area of land which often had multiple ethnic and religious groups of people. Still, the Balkan states came together one last time and formed The Balkan League in 1912 with Serbia, Bulgaria, Greece, and Montenegro as members. The First Balkan War between the League and the Ottomans lasted seven months, with the League emerging victorious. The Ottomans were forced to cede their last Balkan territories to the League’s members, while Albania was also liberated. This alliance was not to last, however. Various disagreements over territory in Macedonia led to the Second Balkan War in 1913. Bulgaria attacked its former Balkan allies and in the process, it left itself open to attack by Romania and the Ottomans. Not even a year later World War One began and the Balkans were divided again. Serbia, Montenegro, Romania, and Greece sided with the Allies while Bulgaria and the Ottomans supported the Central Powers.
The war ended with the collapse of the Ottoman Empire. Greece attempted to capitalise and achieve its Megali Idea but was beaten back and forced to give up its dream of owning land on both sides of the Aegean Sea. Bulgaria, having been on the losing side of the war, was downsized again and forced to abandon its dreams of a Third Bulgarian Empire. The main winners in the Balkans were Romania and Serbia, with the former managing to achieve its dream of “România Mare” while the latter united with Montenegro, Bosnia, Croatia, and Slovenia to form Yugoslavia, the state of Southern Slavs.
Greater Romania would only survive for 20 years before it was brought to an end by the Second World War (WWII). Yugoslavia, despite being invaded in WWII, survived and emerged from the conflict as a new communist nation, like Romania, Bulgaria, and Albania. However 50 years later, in the 1990s, a series of violent ethnic-based wars tore apart the union once based on brotherhood and unity. This leads us to the modern day, with the Balkan Peninsula as we know it today.
To conclude, what are the takeaways from the turbulent history of the Balkans in the past 200 years? Are great union projects destined to fail? Are the scars of the past still present? Maybe it is not for us to answer these questions, but we know that the number of disagreements and conflicts has decreased over time and the need for peace eventually prevails. Balkan nations have increased the levels of cooperation between themselves, and the younger generations are more and more beginning to distance themselves from the grudges and rivalries of the past. While issues are raised every now and then, it appears that the Balkans, after a tumultuous time in the past few centuries, are beginning to turn over a new leaf.

Is there a true value to art?
by Zo Nastase (Year 12)The creative is the only labour to that one is unable to attribute a ‘correct’ value. Unlike other forms of labour, the price of art is not necessarily quantifiable or universally agreed upon. I want to discuss the nature of creativity, explore the various perspectives on the function of art and highlight the significance of aesthetics and the issues with the monetary pricing of artwork.
Aristotle (in short), argued that art serves as an imitation of reality, aiming to teach moral and ethical lessons. According to him, art is not an end, in itself, but a means to an educational purpose. He views that art “presents us with a vivid realization of the better and worse elements in our moral life”[1] and by doing so can help citizens become better. It offers them both an example of what they should strive for, through the epic poem, or an outlet for their negative emotions, such as in tragedy. This view that art is meant to serve a specific goal is essentially a ‘functional’ view of the creative. Similarly to many functionalist theories, Aristotle defines the value of art through how well it is able to achieve “the function in terms of which they define art”[2]. Thus, enforcing the concept of ‘good’ art and ‘bad’ art depends on how well it achieves its goal.
Instead, many assert that art has often been utilised as a symbol of the prosperity of a nation. Examples include the Pyramids in Egypt, palaces of ancient civilizations, cathedrals of the Middle Ages, ect. In these cases, the value of art extends beyond its moral or instructional purpose, instead serving as a testament to the authority of those who commissioned it. Karl Marx would further comment on this view through the specifics of religious artwork. He viewed art as one of the tools used to further separate and alienate the proletariat from the prospering higher class. In his, now-lost, “On Religious Art” (1842) article, he agrees that Greek artwork is meant to imitate reality, however, views any religious attachment to art as a way to distract from its original role. Therefore, Marxist theory would argue that the

value of artwork is ideological in nature. Religious works deform “natural features into the terrorizing expression of idols by which submission of believers is enforced”[3]. While Marx makes his views on labour more than clear, the distinction between the Aristotelian, functionalist and Marxist views on the role of art only apply if we view the value of art through its benefit to society.
While art may possess instructive, symbolic or ideological aspects, the most bare-bones perception of art lies in its aesthetic role. Throughout human history, people have been drawn to the concept of beauty, perceiving it as a direct measure of value. While beauty is just as hard to define as artwork, due to its cultural, societal and moral differences, it is the main lens through which art is viewed.
Aestheticians argue that natural beauty cannot be equated to man-

made works of art, since they believe that art can only be valued in its expressiveness[4]. Art must convey a thought or feeling in order to be ‘beautiful’ and therefore have value. Furthermore, art must intend to be beautiful to have value. However, issues arise with the inherent aesthetic value of art. For example, many would choose to define beautiful ancient tools and artefacts as forms of art, despite them not being created to serve that purpose. We can therefore infer that ‘beauty’ and aesthetics aren’t so much the value of art, as is visual interest and cultural significance.
Attributing a concrete monetary price to creative labour, as many other topics brought up, is unable to be agreed upon. Unlike the quantifiable aspects of other labour forms, such as time and materials, the value of art encompasses a lot of other factors, including, as previously mentioned, historical context, cultural significance, emotional resonance, (and the artist’s reputation/status). These subjective elements make it difficult to determine a universally accepted price for a particular artwork or art as a concept. Even if reduced to previous quantifiable aspects, material aside, time in artwork cannot equate accurately to money. Time, in any other form of labour, often speaks to the quality of a product or service. However, ‘non-valuable’ artwork can still take decades to finish and ‘valuable’ artwork could be produced within a week. This further speaks to how value in art is not able to be correctly measured.
To end on, this article is not intended to answer the question of value possessed by art as that would be an impossible task. But instead suggests a broader look into the value of the creative and why manmade art can be seen as ‘priceless’. Inspired by the recent rise in Artificial Intelligence (AI) generated ‘artwork’, I wanted this short piece to encourage further thought into the ‘why’ of art.

Sources/Citations
[1] What Is Art According to Aristotle? - ATX Fine arts
[2] ABELL, C. (2012). Art: What it Is and Why it Matters. Philosophy and Phenomenological Research, 85(3), 671–691. http://www.jstor.org/stable/41721256
[3] Werckmeister, O. K. (1973). Marx on Ideology and Art. New Literary History, 4(3), 501–519. https://doi.org/10.2307/468532
[4] Zemach, E. M. (1966). The Ontological Status of Art Objects. The Journal of Aesthetics and Art Criticism, 25(2), 145–153. https://doi.org/10.2307/429385

LK-99: A Superconductor Tale
by Andrei Vernon (Year 13), Head BoyFor ages, scientists have been on a quest to find a material that works as a superconductor at room temperature and pressure. While many have considered it impossible, two preliminary papers have been released by a South Korean research team, claiming to have found one such “perfect superconductor”, named LK-99. So what does this mean, and how could it change our lives?
To understand why superconductors are such a big deal, you first have to understand how regular conductors work. When an electric current passes through a conductor, it is met with resistance, which causes some of its energy to be lost as heat. A superconductor allows electricity to flow effortlessly, without any resistance, and without any energy being lost. The only catch? The only superconducting materials found so far need to either be kept at hundreds of degrees below zero, or at incredibly high pressures. This makes them completely impractical to use for most applications.
The most important applications of a superconductor would be in the energy sector. With our current power transmission lines, lots of energy is lost as heat. This means that generators have to be kept close to human settlements, so less energy is lost in transmission between the two. A room-temperature superconductor could be used to create more efficient power lines, eliminating energy losses and allowing power to be sent across long distances. This could enable us to have larger solar fields and other renewable power sources in more remote areas where they won’t bother people, or even be able to send energy between countries or continents with advanced enough infrastructure.
Another application is in energy storage systems. Currently, power is constantly being generated for human use. When we generate more power than is needed, a lot of that energy is wasted, and the only way to save some of that energy for later is by using batteries. But with our current technology, batteries aren’t very efficient and require materials like lithium to work, which cause damage to the environment when extracted. A room-temperature superconductor could allow us to create less expensive, lower waste, and higher capacity batteries.

Room-temperature superconducting materials can allow for faster and more efficient electronic components and more reliable communication and data transmission. They would also simplify the production process of technologies that already need superconductors to work, such as quantum computers and nuclear fusion reactors, which are revolutionary in their own right.
What about transportation? Maglev trains, for example, could become more efficient and faster if room-temperature superconductors were used in their construction, reducing energy consumption and increasing speed. More efficient and powerful electric vehicles and aircraft could be created, reducing the transportation sector’s environmental impact. As you can see, the advantages a superconductor would bring are all about efficiency. This is why scientists theorize that such a material could be instrumental in helping us fight carbon emissions and climate change.

So what’s the deal with the South Korean papers? Well, they’re ‘preprints’, preliminary papers that haven’t been peer-reviewed, which is the gold standard for academic research. Research that hasn’t been peer-reviewed has very little credibility. These huge claims going completely unverified has caused a stir in the scientific community and pushed researchers from around the world to race to reproduce the team’s findings. Some scientists have already pointed out mistakes and inconsistencies in the paper, and Oxford University professors have described the findings as “interesting, but not yet wholly convincing”.
Dr. Mark Ainslie, a superconductors expert from King’s College London, says, “We’re cautious about these kinds of claims. It would be fantastic, but extraordinary claims require extraordinary proof. We’re waiting to see what happens with the replication efforts going on at the moment. Until we have that and some kind of formal paper that is peer-reviewed, we should be cautious.” So far, nobody else is believed to have had any luck reproducing the purported results.
While the idea of levitating trains and perfect energy grids is fascinating, it’s crucial to stay grounded. Even if LK-99 was the real deal, being able to produce it reliably is another step.
Dr. Ainslie reckons it would take “a decade or more to refine” a room-temperature superconductor for practical use. Many experts believe that even if LK-99 doesn’t live up to the hype, there’s still hope for making incremental improvements to existing superconductors. These improvements could lead to more efficient technologies and applications, even if they don’t give us the holy grail of room-temperature superconductivity.
In the end, the tale of LK-99 is a reminder of how science works: with skepticism, testing, and collaboration. So, as exciting as it is to imagine a world with superpowers for electricity, we’ll have to wait and see if LK-99 is truly the key to unlocking a new era of innovation.


Maximizing Your Summer Break: Practical Tips and Goal-Setting for a Successful Year Ahead
by Cristina Latcu, IBSB Student CounsellorMaximizing Your Summer Break: Practical Tips and Goal-Setting for a Successful Year Ahead
As we bid farewell to another academic year, the summer break beckons us with open arms, inviting us to embrace the joys of leisure and relaxation. As your trusted school counsellor, I want to emphasize the importance of making the most of this valuable time. Summer break offers a golden opportunity to recharge, explore new avenues, and prepare for the challenges of the upcoming school year.
In this article, I will share five practical examples on how to better utilize your free time, highlight the benefits of taking a break, and provide guidance on setting goals for the year ahead.
• Pursue Personal Passions: Whether it’s playing a musical instrument, painting, writing, or engaging in sports, find an activity that brings you joy and dedicate regular time to it. Cultivating your passions not only provides a sense of fulfillment, but it can also enhance your creativity, discipline, and self-confidence.
• Engage in Volunteering: Engaging in acts of service not only benefits others, but also fosters personal growth and empathy. Volunteer at a local charity, help out at a summer camp, or contribute to an environmental initiative. By dedicating your time and skills to meaningful causes, you’ll develop a stronger sense of social responsibility and gain valuable life experiences.
• Explore Reading and Learning: Challenge yourself to expand your knowledge and explore new horizons through reading. Select books that captivate your interest and cover a diverse range of genres. Fiction can transport you to magical worlds, while non-fiction can provide valuable insights into various subjects. Continuous learning throughout the summer break will keep your mind active and prepare you for the intellectual demands of the coming school year.
• Embrace Physical Activity: Summer break provides ample time to engage in outdoor activities such as swimming, hiking, biking, or joining a sports club. Regular exercise not only promotes physical fitness but also helps reduce stress, enhance concentration, and improve overall mood. Prioritize your health by setting aside dedicated time for physical activities each day.
• Nurture Relationships and Reflection: Use the summer break to strengthen your relationships with family and friends. Plan outings, engage in meaningful conversations, and create lasting memories. Furthermore, take time for self-reflection and personal growth. Consider journaling, meditation, or engaging in mindfulness exercises. Reflecting on your past achievements and challenges can provide valuable insights and help you set realistic goals for the future.


Benefits of Taking a Break: Taking a well-deserved break from the rigors of academic life is crucial for overall wellbeing. It allows you to recharge, rejuvenate, and return to school with renewed focus and energy. Benefits of summer break include reduced stress levels, increased creativity, improved cognitive abilities, enhanced problem-solving skills, and a stronger sense of personal identity.
Practical Goal-Setting for the Upcoming School Year: As the summer break draws to a close, it’s important to set practical and achievable goals for the upcoming school year. Here’s a step-by-step approach to setting effective goals:

1. Reflect on past achievements and challenges.
2. Identify areas for improvement or personal growth.
3. Set specific, measurable, achievable, relevant, and time-bound (SMART) goals.
4. Break down larger goals into smaller, manageable tasks.
5. Create a timeline and establish a system for tracking progress.
6. Seek support from teachers, parents, or mentors to help you stay accountable.
7. Celebrate milestones along the way and adjust goals as needed.
8. Remember, goal-setting is an ongoing process that requires commitment and flexibility. With clear objectives in mind, you can navigate the upcoming school year with confidence and purpose.
Wishing you all a memorable and enriching summer break!

Helping Your Children Navigating the Teenage Years
by Ilinca Birsan (Year 12), Senior Prefect1. Peer Pressure
One of the most prevalent challenges teenagers encounter is peer pressure. Adolescents often feel the need to conform to social norms and expectations, which can lead to risky behaviours or compromising their values. As these years are composed of high impulsivity and thoughtless decision-making, teenagers should be encouraged to develop a strong sense of self and assert their individuality. Teaching them about making independent choices, setting boundaries, and surrounding themselves with positive influences can help them resist negative peer pressure and make informed decisions, which is likely to help them in the long term.

2. Academic Pressure
The pressure to excel academically, meet deadlines, and perform well in exams can lead to anxiety and burnout, making it essential to emphasize the importance of balance and self-care. Encourage students to prioritize their mental and physical well-being, manage their time effectively, and seek help when needed. By fostering a supportive learning environment, schools can help attenuate academic pressure and promote holistic development.

3. Emotional Wellbeing
Teenagers often face a rollercoaster of emotions as they grapple with hormonal changes, increased responsibilities, and a quest for identity. This emotional turmoil can lead to mood swings, heightened sensitivity, and feelings of isolation. Teenagers should be encouraged to express their feelings, seek support from trusted adults or counsellors, and practice self-care activities like journaling, art, or engaging in hobbies that bring them joy. By normalising conversations about mental health, we can reduce the stigma created and ensure that teenagers receive the support they need.



4. Digital Challenges
In the digital age, teenagers are confronted with a host of challenges related to technology and social media. Cyberbullying, online harassment, and the pressure to present a flawless online persona can negatively impact their self-esteem and overall well-being. To avoid such problems, it is vital we encourage responsible internet usage and educate teenagers about online safety. Helping teenagers develop a healthy relationship with technology can promote their mental health and foster a sense of balance in their lives.

5. Future Uncertainty
As teenagers transition into adulthood, they often struggle with uncertainty about their future. Decisions about education, career paths, and life choices can be overwhelming; it is vital to provide guidance and support during this period. Teenagers should feel free and be encouraged to explore their interests, engage in career counselling, and seek mentorship opportunities. Promoting resilience and reminding them that it’s okay to change directions and adapt their plans as they grow while learning more about themselves may reduce their stress levels and other negative impacts that come alongside these uncertainties.

The teenage years are a time of growth, self-discovery, and overcoming challenges. By acknowledging and addressing the common hurdles faced by teenagers, we can empower them to navigate these years with confidence and resilience. Encouraging healthy relationships, promoting self-expression, fostering a supportive environment, and providing guidance can help teenagers embrace their journey and emerge as strong, wellrounded individuals. Let us celebrate the unique experiences and opportunities that adolescence brings, ensuring that teenagers feel supported and equipped to face any challenges that come their way!

RATS CAN MOVE OBJECTS IN VIRTUAL REALITY USING ONLY THEIR THOUGHTS
by Rianna Tanase (Year 12)THE EXPERIMENT
In a groundbreaking study conducted by researchers at the University of Chicago, rats were trained to move objects in a virtual reality environment using only their thoughts. The experiment involved implanting electrodes into the rats’ brains and attaching them to a computer.
The rats were then placed in front of a screen and trained to move a virtual object by thinking about it. The researchers found that the rats were able to successfully move the object using only their thoughts, demonstrating an impressive level of brain-computer interface.
IMPLICATIONS
The implications of this research are significant. It suggests that virtual reality could be used to help individuals with disabilities or injuries regain control of their movements through brain-computer interfaces.
Additionally, the study sheds light on the brain’s remarkable ability to adapt and learn new skills, even in the absence of physical movement. Further research could lead to new insights into how the brain controls movement and how this can be harnessed for therapeutic purposes.
CHALLENGES
While the study is certainly impressive, there are still significant challenges that need to be overcome before brain-computer interfaces become a practical reality. One major challenge is the risk of infection or other complications associated with implanting electrodes into the brain.
Additionally, there are ethical concerns surrounding the use of such technology, particularly in terms of privacy. As with any new technology, it will be important to carefully consider these issues as brain-computer interfaces continue to develop.

CONCLUSIONS
The ability of rats to move objects in virtual reality using only their thoughts is a remarkable achievement that has significant implications for the future of brain-computer interfaces. While there are still challenges to be overcome, this research opens up exciting new possibilities for medical treatments, education, and entertainment.

As virtual reality continues to evolve, it will be interesting to see how it is integrated into our lives, and what new discoveries and innovations emerge as a result!



The Importance of extracurricular enrichment
by Felix Daianu (Year 9), Middle School Debater, and Public Speaker ExtraordinaireAnything could be classified as extracurricular activity. Really! Anything from football to after school calligraphy classes. Of course, everyone subjectively thinks of every activity differently, but that is not important because in the end, they’re all valuable in one way or another.
A child is a complex creature. Any human is, to be fair, but that unpredictability of human nature is at its most potent in anything that goes to school and doesn’t pay taxes, so you’d expect at this stage in life to see someone moving from hobby to hobby, interest to interest, as the emotions and perspectives change along with the vicissitudes of life.
Thankfully these days, with the diversity and degree of specialisation greater than ever, it now seems that there is a course for almost everything, so club time is not just an hour away from the more serious examinable subjects, to relax and enjoy yourself, it is also importantly a chance to explore a new hobby or interest that could lead to a lifelong passion, or better still, a very interesting future career. Not to mention the fact that all American universities downright require extracurriculars and the Russell Group universities in the UK highly encourage extracurriculars.
As a student, I could sit here and tell you about the studies conducted by X or the ‘10 Benefits of Extracurricular Activities’ Buzzfeed Article, but that wouldn’t really make the point I’m trying to make here. I rather tell you about my personal experiences and share a few thoughts.
I have done everything from basketball (I know… Shocker! ‘I’ played basketball.) to art classes (2 months and I was still awful at art!). And despite the “waste of time” I perceived many of them to be, I have come to realize that somehow SOME of the skills learned in all activities came back to me in a useful way. Except for basketball. That

wasn’t for me. I’m not saying don’t try basketball - It’s a great sport - I’m just saying, I was irredeemably bad at the game to the point I learned nothing from it.
I don’t think that there is a single activity to beat out all of the others, because let’s face it, it all boils down to the individual’s interests and ability. That’s something I know some people think and in my opinion, it could stop a child from learning some really valuable skills from some rather obscure places or experiences.
My personal favourite from the many activities I’ve attempted so far was my drumming lessons. Despite my less than stellar performance, I learned three things from that experience, as short as it was:




Anything could be classified as extracurricular activity. Really! Anything from football to after school calligraphy classes. Of course, everyone subjectively thinks of every activity differently, but that is not important because in the end, they’re all valuable in one way or another.
1. I earned the confidence necessary to go up on stage and perform, even if I fail, which helps with debate and public speaking today. If you search for me on YouTube, you’ll find my old drumming performance, although I must warn you, I was the opposite of good.
The art classes, for instance, taught me patience and the ability to trust the process. Keep in mind, I was only going because my sister was going and my mom needed us to share a common commute. If I had never attempted these classes, I’d be way more impatient today and after having desecrated my brain with 7 months of Tik Tok in lockdown, this course really set me back on track.
A child is a complex creature. Any human is, to be fair, but that unpredictability of human nature is at its most potent in anything that goes to school and doesn’t pay taxes, so you’d expect at this stage in life to see someone moving from hobby to hobby, interest to interest, as the emotions and perspectives change along with the vicissitudes of life.
2. I developed one of the most important skills I have today. A sharp sense for rhythm. This has helped me tremendously in all of my music endeavours and is one of the only reasons that I can make whatever type of song I want today.
Thankfully these days, with the diversity and degree of specialisation greater than ever, it now seems that there is a course for almost everything, so club time is not just an hour away from the more serious examinable subjects, to relax and enjoy yourself, it is also importantly a chance to explore a new hobby or interest that could lead to a lifelong passion, or better still, a very interesting future career. Not to mention the fact that all American universities downright require extracurriculars and the Russell Group universities in the UK highly encourage extracurriculars.
3. I made valuable friends. I met some really famous singers and drummers at that school as well as generally great people! Through my enrolment at this school, I had the privilege of being invited to take part in a music video shoot for a Voltaj song. None of these things would’ve happened had I never attempted picking up the drums.
I also believe that you should give activities a go that aren’t necessarily linked to your usual hobbies or interests, because you never learn as much as when you are out of your comfort zone. I have done this many times and believe it or not, it has helped me out a lot.
The last thing to discuss is not as fun as the other ones. It is actually a looming threat for many kids who don’t even know it, especially at a young age. That foe is burnout. If you over schedule your child (even if it is their wish), they will quickly lose their grasp on the ability to balance their schoolwork and social life. I can speak from personal experience, because at one point there was a time when I had courses of some sort every day and I promise you that I wasn’t happy. What added to my sadness was the steady flow of trouble I was getting into for not doing my homework, so If there is one thing I’d suggest that everyone keeps in mind, it is to find the right balance.
As a student, I could sit here and tell you about the studies conducted by X or the ‘10 Benefits of Extracurricular Activities’ Buzzfeed Article, but that wouldn’t really make the point I’m trying to make here. I rather tell you about my personal experiences and share a few thoughts.
I believe that I have covered everything I know. This may not be the most scientifically sound or backed up text you’ve ever read but it was my experience and I think personal experience is really valuable. That being said, I thank you for reading, I thank Mr Peet for letting me write this, and I thank my mom for making me pick up all of those courses.
I have done everything from basketball (I know… Shocker! ‘I’ played basketball.) to art classes (2 months and I was still awful at art!). And despite the “waste of time” I perceived many of them to be, I have come to realize that somehow SOME of the skills learned in all activities came back to me in a useful way. Except for basketball. That wasn’t for me. I’m not saying don’t try basketball - It's a great sport - I’m just saying, I was irredeemably bad at the game to the point I learned nothing from it.
I don’t think that there is a single activity to beat out all of the others, because let's face it, it all boils down to the individual’s interests and ability. That’s something I know some people think and in my opinion, it could stop a child from learning some really valuable skills from some rather obscure places or experiences.
My personal favourite from the many activities I’ve attempted so far was my drumming lessons.

The Power of Play: Unleashing the full potential of your children
by Delia Ciobanu, IBSB Student CounsellorIn today’s digital world, where screens all too often dominate our daily lives, it’s crucial to recognise the importance of play for children. Play is a fundamental aspect of a child’s development, shaping their cognitive, emotional, physical, and social skills. Beyond mere entertainment, playtime offers a wealth of benefits that foster creativity, imagination, problem-solving, and social interaction.
Here are a few of the transformations associated with the power of play and why it should be prioritized over excessive screen time:
1. Enhancing Cognitive Development: play serves as a natural learning process, fuelling a child’s cognitive development. Though play, children engage in problemsolving, critical thinking, and decision-making. Building blocks, engaging in pretend play, or solving puzzles stimulates their imagination and strengthens their cognitive abilities. Play also supports language development as children engage in conversations, storytelling, and role-playing, fostering communication skills and expanding vocabulary.
2. Nurturing Emotional Intelligence: play provides a safe space for children to explore and express their emotions. Whether they engage in imaginative play, engage with toys, or participate in physical activities, playtime allows them to navigate different emotions, understand empathy, and develop emotional intelligence. It offers an outlet for emotional release, promoting resilience and self-regulation. By playing with others, children learn to cooperate, negotiate, and resolve conflicts, fostering healthy social and emotional developments.

3. Igniting Imagination and Creativity: playtime fuels a child’s imagination and creativity, acting as a springboard for self-expression. Whether they construct elaborate forts, engage in artistic pursuits, or engage in open-ended play, children tap into their imagination, creating new worlds, and ideas. Play sparks curiosity, encourages experimentation, and nurtures problem-solving skills, helping kids think outside of the box. By embracing play children become more adaptable, innovative, and resourceful individuals.


4. Promoting Physical Health and Well-being: play is synonymous with movement, offering children opportunities to engage in physical activities that promote health and well-being. Active play such as running and outdoors games, strengthens muscles, enhance coordination, and improves cardiovascular fitness. Regular physical play reduces the risk of obesity and promotes a healthy lifestyle. It also boosts selfconfidence and self-esteem as children experience the joy of physical accomplishment and develop a positive body image.
5. Fostering Social Skills and Relationships: play is a natural socializing agent, enabling children to interact, chare, and collaborate with their peers. It fosters the development of
important social skills such as communication, cooperation, and problem-solving. Through play, children learn to take turns, negotiate, and respect other’s boundaries, laying the foundation for healthy relationships. Play also creates opportunities for building friendships, empathy and understanding diverse perspectives, contributing to their emotional; well-being and social integration
In a world where screens dominate, it’s vital to preserve and prioritize playtime for children. Play is not only enjoyable ,but crucial for their holistic development, igniting their potential, and nurturing essential life skills.


The Value of Reading Consistently
by Haidar Mrad (Year 12), Senior PrefectReading consistently has been one of the habits which has helped me significantly improve my academic performance over the course of my time at IBSB. Now with the summer holidays upon us, it is the perfect time in which students can further build up the habit of reading on a daily basis.
The Advantages of Regular Reading
Reading regularly during the summer is an excellent way to develop your reading skills, increase comprehension, and broaden one’s horizons. The summer slide, or the loss of academic progress during lengthy vacations from school, can avoided with continued reading throughout the summer. Making reading a regular summertime activity is a good way for students to keep their minds active and create a love of learning that will last a lifetime.
FACT FLASH
Elon Musk read two books a day throughout his childhood, according to his brother, and before he became the owner of Tesla, said he read for 10 hours a day
Bill Gates likewise is another prolific reader, though less than Elon Musk, reading he says a minimum of 50 books year- he is also one of the world’s most wealthy and successful businessmen, who is reported to read 2-3 books a week.
Another of the world’s richest men, Warren Buffet, says he spends approximately 80% of his time reading
One of my favourite books: Deep Work by Cal Newport
Deep Work by Cal Newport is one of the books that has benefited me the most in my academic career. This fascinating book examines the value of single-tasking in our increasingly multitasking society.

In this digital age, Newport believes, the capacity to focus intently without interruption is more vital than ever. He offers concrete advice on how to train oneself for deep work or sustained concentration on mentally taxing activities.
Deep Work is highly valued because it leads to increased output, innovation, and satisfaction. This book is a resource for people of all ages who want to recover their focus and effectiveness in the workplace or the classroom.


Other books which have helped me:



Top 5 bands you should check out
by Andrei Urjan (Year 10) and Roman Tiderle (Year 10)Music has the power to transport us to different worlds, evoke emotions, and bring people together. With countless bands and artists creating incredible music across genres, it can be challenging to narrow down your playlist. However, if you’re looking for a selection of bands that have stood the test of time and continue to captivate audiences, here are the top five bands you should listen to right now.
Number 5. Dire Straits:
Kicking off our list is Dire Straits, a British rock band formed in 1977. Led by the exceptional guitar skills of Mark Knopfler, Dire Straits crafted a unique sound that blended rock, blues, and folk influences. Their iconic hits such as “Sultans of Swing”, “Money for Nothing” and “Brothers in Arms” showcase their melodic songwriting and Knopfler’s intricate guitar solos. Dire Straits’ music is timeless and continues to resonate with music lovers of all generations.

Number 4. Rage Against the Machine:
Known for their explosive blend of rock, rap, and political activism, Rage Against the Machine has left an indelible mark on the music scene. Formed in 1991, this American band combines heavy guitar riffs, powerful lyrics, and a fiercely rebellious spirit. Songs like “Killing in the Name” and “Bulls on Parade” are anthems of defiance that tackle social and political issues head-on. Rage Against the Machine’s music carries a raw energy that ignites a fire within its listeners.

Number 3. The Police:
Taking the third spot is The Police, an influential British band that dominated the late 1970s and early 1980s with their distinctive sound. Comprising Sting, Andy Summers, and Stewart Copeland, The Police merged elements of rock, reggae, and new wave to create a sound that was both catchy and innovative. Hits like “Message in a Bottle” and “Roxanne” showcase their ability to craft catchy melodies with thought-provoking lyrics. The Police’s music remains a timeless testament to their artistry and musicianship.


Number 2. Sublime:
Coming from Long Beach, California, Sublime is a band that effortlessly fused punk rock, reggae, ska, and hip-hop to create a laid-back yet energetic sound. With the late Bradley Nowell at the helm, their music captures the essence of Southern California’s beach culture. Tracks like “Santeria”, “What I Got” and “Same In The End” showcase their catchy melodies, infectious rhythms, and introspective lyrics. Sublime’s music is a perfect soundtrack for sunny days at the beach and carefree vibes.

Conclusion:
Number 1. Pink Floyd:
Topping our list is the legendary British progressive rock band, Pink Floyd. Known for their groundbreaking concept albums and immersive live performances, Pink Floyd pushed the boundaries of musical creativity. With their introspective lyrics, atmospheric soundscapes, and thought-provoking themes, their albums like “The Dark Side of the Moon” and “The Wall” are considered some of the greatest in rock history. Pink Floyd’s music transcends time and space, inviting listeners on a journey of self-discovery and introspection.

These five bands offer a diverse range of musical styles and genres that have left an indelible mark on the music industry. Whether you’re into classic rock, alternative, punk, or progressive sounds, Dire Straits, Rage Against the Machine, The Police, Sublime, and Pink Floyd have all contributed iconic songs that continue to resonate with audiences today. So, plug in your headphones, press play, and embark on a musical adventure with these extraordinary bands.






Unleashing Gaming Power: The Best Gaming GPU of 2023
by Victor Samolia Zamfirescu (Year 8)Introduction:
In the fast-evolving world of gaming, staying ahead of the curve requires cutting-edge technology. When it comes to delivering immersive visuals, lightning-fast performance, and unmatched gaming experiences, nothing is more crucial than having a powerful graphics processing unit (GPU). As we delve into 2023, the gaming landscape has been graced by a standout performer that has captured the hearts of gamers worldwide. In this article, we explore the best gaming GPU from 2023, one that has set new benchmarks and raised the bar for gaming enthusiasts.
The NVIDIA GeForce RTX 4080: A Quantum Leap in Gaming Performance




The NVIDIA GeForce RTX 4080 stands tall as the pinnacle of gaming GPUs in 2023. Built upon the foundation of technological advancements and breakthroughs, this GPU offers an unparalleled gaming experience that pushes the boundaries of what is possible in gaming graphics.
Ray Tracing Perfected:
Ray tracing, once a dream, has now become a reality in gaming thanks to the RTX 4080. This GPU showcases the epitome of ray-tracing technology, enabling incredibly lifelike lighting, reflections, and shadows. The RTX 4080’s dedicated ray-tracing cores, combined with advanced algorithms and AI-driven features, deliver a level of realism that transports gamers into a whole new dimension of visual splendor.
AI-Enhanced Super Resolution:
The RTX 4080 utilizes AI-powered deep learning algorithms to revolutionize image upscaling. With its DLSS (Deep Learning Super Sampling) technology, this GPU can upscale lower-resolution images in real-time, resulting in remarkably crisp and clear visuals without compromising performance. Gamers can now enjoy higher frame rates and improved image quality simultaneously.
Unmatched Performance:
Brimming with cutting-edge hardware, the RTX 4080 exhibits extraordinary power and performance. Equipped with a nextgeneration Ampere architecture and enhanced CUDA cores, this GPU delivers blistering frame rates, smooth gameplay, and remarkable graphics quality across a wide range of games. Gamers can finally immerse themselves in demanding titles with high settings, knowing that the RTX 4080 can handle the load effortlessly.
Advanced Cooling and Efficiency:
The RTX 4080 boasts an innovative cooling system that ensures optimal performance while maintaining lower temperatures. Featuring an advanced vapor chamber and redesigned cooling fans, this GPU keeps thermals in check, allowing gamers to push their systems to the limit without worrying about overheating. Additionally, the RTX 4080’s energy efficiency optimizations help conserve power, resulting in a greener and more cost-effective gaming experience.
Enhanced Connectivity and Support:
Keeping up with the demands of modern gaming, the RTX 4080 supports the latest connectivity standards. Gamers can enjoy high-speed data transfers, reduced latency, and seamless gameplay thanks to features such as HDMI 2.1 and DisplayPort 1.4a. Additionally, NVIDIA’s commitment to providing regular driver updates ensures ongoing performance enhancements and support for the latest gaming technologies.
Conclusion:
As we enter the gaming realm of 2023, the NVIDIA GeForce RTX 4080 reigns supreme as the best gaming GPU of its time. With its groundbreaking ray-tracing capabilities, AI-driven image upscaling, unmatched performance, efficient cooling, and advanced connectivity, the RTX 4080 sets a new benchmark for what a gaming GPU can achieve. Whether you’re a casual gamer seeking breathtaking visuals or a competitive player aiming for the utmost performance, the RTX 4080 delivers an unforgettable gaming experience. Get ready to immerse yourself in the future of gaming with the unrivaled power and innovation of the NVIDIA GeForce RTX 4080.

The Future Doctor Programme
by Dr Darren Laffar, HPL Secondary School CoordinatorThe future doctor program is an online course offered by Harvard University targeted at high-school students. The programme seeks to introduce students to the fundamentals of pre-medical studies, covering various topics, including content modules on genetic inheritance, hormones, immunology, and organic chemistry.
Sarmiza in year 10 has long held an interest in medicine, mainly because her mother is a doctor, and so she decided to apply. I asked her about the application process, which was extremely competitive, with thousands of applicants received from all over the world.


Sarmi:
The first step was to submit a 200-word letter answering the question: “Why do you want to join this course?” In the letter, I mentioned that I am interested in medicine because of my mother, although I am not necessarily interested in becoming a doctor – it is more about research into medicine that is important to me. I am particularly interested in improving both doctor and patient wellbeing and improving the treatments available to patients. I am also interested in looking at the differences in healthcare from different courses. Having passed this first step, the next step was a 15-minute interview with a Harvard student that is leading the course. They asked me a few questions about my application letter. I emphasised the fact that I am looking forward to meeting and working with new people and learning new things.
It didn’t finish there! After Sarmiza was accepted, her classmate, Rares Stanciu, decided to apply also. He is also interested in becoming a doctor, and Sarmiza gave him some advice on his application letter.


Rares:
My letter outlined what I found most interesting about being a doctor - it involves constant improvement and innovation in order to offer patients better treatment and healthcare to improve people’s quality of life and longevity. I love learning and would hate to end the learning process in a few years. I am highly interested in STEM and love learning about the intricacies of the human anatomy in biology. It fascinates me to discover how thousands of simple functions build into complex chain reactions.
Rares was accepted onto the course too, starting on the 15th of July and running over two weekends. Let us hope the course is fun, and they get a lot out of it. Well done to you both. WE look forward to reading your review of the course in the next issue of TIV.

University Destinations
by Jayne Baker, University CoordinatorDear Parents,
As mentioned in my previous letter about the workshops I am enclosing some further information about common countries that our students apply to, a brief overview of the application process and the costs involved in attending universities in these countries. Obviously, the university landscape is always changing, so this is just a general overview and further research would need to be conducted by you.
The United Kingdom
If anyone is British, or has pre-settled status, then the UK based fees are applicable. These are currently 9,250GBP per year. You would be entitled to funding through a student loan and also entitled to apply for additional maintenance funding. However, since Brexit, most of our students are no longer in this situation. The minimum international fee is roughly 15,000GBP and this can rise to anything up to 46,650GBP per year for some of the most competitive universities, with competitive courses. There are scholarships available, however, these are rare to come by for international students, but some universities like University of Essex offer an automatic annual 5,000GBP scholarship for any Romanian student, hence it has been a popular university destination for our students in the past.
The application process - This is conducted through a portal called UCAS, which the school collates on behalf of the students. The portal is open from mid May and the general application deadline is 31 January 2024. Anybody applying for Oxford, Cambridge, Veterinary, Dentistry or Medicine, needs to apply by mid October. Any student that is attending a University Workshop in May or June that wishes to apply to the UK, will start their UCAS application with me at this time. They will also receive advice on how to start their personal statement.



The Netherlands
This has become an equally popular choice as the UK, mainly because of the low fees. It costs EU students roughly 2,250EUR per year to attend most university courses. However, this can vary if a student decides to study Liberal Arts or Hotel Management. These courses cost more. There are two types of universities in The Netherlands - Research and Applied Science. The research universities are more rigorous in their demands of the students. Some of the research universities that have courses which are over subscribed, will offer applications through Numerus Fixus - this means that only a set number of students will be admitted, after their application has been received, so they may have to sit an entrance test. The Netherlands has become so popular that the Dutch government is worried about the spiraling cost of housing for their population - and this is a major issue for students to consider if applying to The Netherlands - especially for cities such as Amsterdam. Therefore, rent costs are high and waiting lists for accommodation are long, so this needs to be a consideration in applying.
The application for The Netherlands opens on 1st October, and I will run a dedicated session for students at this time. There is no set format of documents for The Netherlands either, so my suggestion if you are applying here, is to not prepare anything yet and wait to see what the university requests from you once you have completed your application on Studielink - the university will email you with the list of required documents.

Spain
The rising popularity of Spain over the last few years has led to an increase in courses offered in English to attract European students. The two popular cities are Barcelona and Madrid. Applications to these universities start in the summer and are allocated on a first come, first served basis. I do need to advise though, that the reservation fee is quite high (around 4,000EUR), so applying early, if it is not a first choice, may be something to avoid, as they require this fee to be paid within 2 weeks of being offered a place.
The average cost of a degree from one of the private universities is around 25,000EUR per year. There are scholarships available though, ranging from a percentage of fees paid to a full scholarship opportunity. The public universities are much more difficult to access. It is hard to find information about their degree programmes from their websites and we have not had anyone apply recently.
The application process for these universities is not portal based. Students need to apply individually to each university and course that they are interested in. The documents vary from university to university and I would highly recommend the students making an appointment with me individually to discuss their requirements.

Hong Kong
These universities are extremely competitive to get into. I would not recommend an application unless the student is studying 4 A levels of the highest caliber, have a faultless IGCSE profile and excellent English proficiency. The deadline date for application is the start of November, so if a student is applying here, they must identify themselves to me early as the application process is relatively complex. The applications are to each individual university and there is no portal. The average fee is 171,000HKD per year which is roughly 20,000EUR.


Canada
The USA is notoriously expensive to attend, however, there are plenty of scholarships available. The application is through a portal called Common App. It is a very cumbersome application process where many personal family details need to be included. It is recommended that students start this process in September or earlier, the deadline date is early January. If a student is applying to the USA, they should come to speak to me, so that the correct information is input, as matching the US system to the British system can be complicated. The average cost of a public university is $26,000 per year and the private universities are $36,000.

Italy
Many of our students are considering Italy now. Bocconi has become a popular choice. It has a high entry requirement and can be accessed either through SAT’s or through their own entrance exam. If Bocconi is of interest to a student, it is always worthwhile applying early, as they have a limited number of spaces available, but just like Spain, they will want a large reservation fee to be paid early, so this needs to be weighed up. The fees are approximately 15,000EUR per year. Other universities have been popular recently such as Humanitas and Instituto Marangoni. All of the Italian universities are applied to through the individual universities websites.

Although nobody has applied to Canada recently I believe that it is a good option to consider. The fees range from $10,000 to $60,000 CAD, but again, scholarships are readily available. Students apply to each university individually, the application process is explained on the relevant university website.

All other countries
As stated, the above are common countries for application, but they are not exhaustive. We have recently done applications to Sweden, Switzerland, Belgium, Ireland to name a few. As a school we thought it might be useful for you to know some of the common country information before starting the university application process.
As always, I am here to help you as a family. If you have any questions, please feel free to email me on jayne.baker@ibsb.ro, or also contact me if you would like to arrange a meeting. I know that I have met at least 5 families already this year for the current Year 12 group.



Ways To Spice Up Your Hot Chocolate
by Sandra Curtis (Year 9)Hot chocolate is winter’s staple beverage. Although we all know and love this drink, it’s easy to get tired of the same old recipe. Here are some ways to give your hot chocolate a delicious twist.
1. Salted caramel swirl
First of all, you need to start out with your standard hot chocolate recipe. Then, stir in a tablespoon (and save some to drizzle later) of store-bought caramel sauce. Put whipped cream, caramel drizzle, and a sprinkle of sea salt (optional) on top, and you’re done!

2. Add candy cane flavour
All you need to do is grab a candy cane and use it to stir your hot chocolate until it has melted slightly. This will cause your hot chocolate to have a minty essence. If you want a bolder flavor, you could try to add a few drops of peppermint oil to your drink.


3. Use a stick instead of powder
Instead of using your typical powder to make hot chocolate, use a hot chocolate stick instead. You can buy them from Lidl, or you can make them yourself (there are lots of recipes online). All you have to do is dip the stick into the warm milk, and wait for it to melt in there.

4. Use a hot chocolate bomb
You can buy one or you can make one yourself. Once you have your hot chocolate bomb, you just need to drop it in a glass of warm milk and wait for it to melt in there.

5. Add a bright pop of color
For a colorful upgrade, search your grocery store for any coloured marshmallows and sprinkles. Prepare your hot chocolate as you normally would and then add these colourful toppings! This recipe is perfect for any time of year and is especially good for birthday parties.

6. Add caffeine
For an extra dose of caffeine, all you need is a teaspoon or two of instant coffee. Stir it into your hot chocolate and you’re done. This can be helpful if you need a drink to help keep you awake but don’t like coffee.


7. Spice it up
If you’re a fan of more spicy flavors, try adding a pinch of nutmeg and/or a pinch of cinnamon to your hot chocolate. Take it a step further by adding a cinnamon stick to stir with.

8. Try a different flavored hot chocolate powder
You can buy a different flavoured hot chocolate powder, such as a white chocolate or peppermint flavoured hot chocolate powder. You can get those from Lidl.

You can buy a different flavoured hot chocolate powder, such as a white chocolate or peppermint flavoured hot chocolate powder. You can get those from Lidl.
Those were some of the ways that you can spice up your hot chocolate. I hope you enjoy them!


Creative Writers in the German Lesson
by Dinu Pietruschevici (Year 8)The Year 7 and 8 German group was tasked with writing a short story entitled “Das Känguruh und der Stier”. This translates to “The Kangaroo and the Bull”. Starting from three images, we had to use our creative skills and invent some stories in German and represent them graphically in Canvas.
In the first image, the kangaroo was struggling to keep its cub in the pouch and the Bull was getting more and more annoyed. In the second picture on the right side, it shows the bull picking up a sewage gutter whilst the mother is on the left side and has finally managed to put its cub in the pouch. In the third and final image we see the sewage gutter being put on top of the pouch, “imprisoning” the kangaroo’s cub whilst two hands are seen poking out. The bull is walking away very satisfied with himself and the adult kangaroo finally seems calm.




Der kangaroo und der stir
Dieser geschichte is im salzburg, das wetter war sehr schon und die temperatur war sehr heiß, die sonne scheint, das baby benimmt sich nicht und der rote bull ist sehr wuten, das baby ist gerannt von ihre mutter aber die mutter findet seine baby Die baby raus zu kommen, der rotes bull is sehr wutend, der rotes bull greift den gitter und er hat uber die beutel gestellen, der baby is trapped








How to Get out of a Creative Slump
by Sandra Curtis (Year 9)Are you ever just trying to write a story, but have zero ideas whatsoever? Or maybe you’re trying to draw something, but nothing seems satisfying enough. These are the times when we find ourselves in a creative slump, feeling stuck and lacking inspiration. It’s important to remember that creative slumps are a natural part of the creative process, and there are ways to navigate through them. This article will discuss the different ways to help you get out of a creative slump
Embrace the Break
Sometimes, pushing yourself to work harder when facing a creative block can only lead to frustration instead of something useful. Instead, simply just take a break from your creative pursuit. Try doing some activities that you enjoy, such as reading, spending time in nature, or trying out new hobbies. Stepping away from your creative project allows your mind to relax and opens up space for fresh ideas to emerge, and when you get back to what you were doing, you might be feeling a lot better and more motivated.
Seek Inspiration
Inspiration can be found in various forms, and seeking it out can be a great way to get some new ideas. You can explore different art forms, visit museums, watch movies, listen to music, read, or anything else along those lines. Even just going for a walk outside can help you feel inspired sometimes. Exposing yourself to new ideas and perspectives can stimulate your imagination and help you get new ideas.
For example, if you’re struggling to come up with an idea for what to write about, reading another author’s book might help you out. However, that does not mean that you should plagiarise their work. You can get inspiration from the plot or certain characters in the book, but then write a story of your own.
Change Your Environment
Sometimes, a change of scenery is all it takes to get back to where you were before. If you typically work in the same space, consider rearranging your workspace or finding a new location to work in. Go to a local café, library, or park to introduce a fresh environment that can stimulate your senses and inspire new ideas.
Practice mindfulness
Practicing mindfulness can help quiet the noise in your mind and allow creativity to flow more freely. Explore meditation, deep breathing exercises, or yoga to cultivate a sense of calm and clarity. Mindfulness practices can help you tap into your inner creativity and enhance your ability to focus on the present moment.
Collaborate and Seek Feedback
Connecting with fellow creatives or seeking feedback from trusted friends or mentors can provide valuable insights and perspectives. Engaging in collaborative projects or participating in creative communities allows you to bounce ideas off others, receive constructive criticism, and gain fresh insights that can spark your creativity.


Embrace Failure and Experimentation
Often, the fear of failure is what holds us back from trying out new and more challenging things. It is a good idea to embrace the mindset that failure is essential to growth and learning and stepping stone towardfuture success. Allow yourself to experiment, try out new techniques, and enjoy the process, rather than simply focusing on the outcome. Celebrate the lessons learned from each creative endeavor, whether successful or not.
Also, don’t try to focus on making your project perfect while doing it. The first draft, the first rough sketch, can always be edited and refined after it is completed. Trying to make your work perfect from the very beginning will make you feel stressed out and feel way less motivated than before.
Try working on a different project
Sometimes, it’s a good idea to drop the project you’re working on at the moment and try doing something different instead. It may turn into something better, and help you feel different again. Try drawing in a different art medium, or writing a different literary genre, or maybe playing a different style of music than you usually play.
Establish a Routine
While creativity thrives on spontaneity, establishing a creative routine can provide structure and discipline to overcome a creative slump. Set aside regular time for creative pursuits, even if you’re not feeling inspired. Committing to a routine creates a habit and sends a signal to your mind that it’s time to get into a creative mindset, increasing the likelihood of inspiration striking.
Conclusion
Experiencing a creative slump is a normal part of the creative journey, and it’s important to remember that it’s only temporary. By embracing breaks, seeking inspiration, changing your environment, practicing mindfulness, collaborating, embracing failure, establishing a routine, and trying out new things, you can get through a creative slump and rediscover your creative spark. Embrace the process, be patient with yourself, and things will be okay again.


Six of Crows by Leigh Bardugo: A Riveting Heist Adventure That Steals Hearts
by Maia Hagai (Year 12), Senior PrefectSix of Crows by Leigh Bardugo has swept the literary world by storm with its compelling mix of fantasy, adventure, and memorable characters. Six of Crows, the first of a planned duology, transports readers to a world where high-stakes heists are commonplace and people with murky morals are impossible to dislike. We will go into the details of this exciting book and discuss why it is a must-read for fantasy and adventure readers.
The novel’s amazingly diversified collection of characters is one of its strongest points. Bardugo skillfully creates six outcast protagonists, each with their own history, goals, and set of abilities. Each member of the team has something unique to offer the adventure, from the quick witted and sneaky Kaz Brekker to the deadly Jesper Fahey and the courageous Inej Ghafa. Despite their flaws, Bardugo’s characters are undeniably captivating, and she expertly weaves their stories together so that readers can empathise with them.
Six of Crows is centred on a daring heist for unfathomable prizes and is set in the seedy city of Ketterdam, a nexus of trade and crime. Kaz Brekker, the operation’s brains, gets an offer he can’t refuse and puts together an eclectic team of experts to do the impossible. As the gang overcomes countless challenges, double-crosses, and unexpected turns, readers are kept on the edge of their seats by Bardugo’s brilliant narrative.
The world that Leigh Bardugo creates in Six of Crows is fantastic. Set in the same world as the Grisha Trilogy, Bardugo transports us to the thriving metropolis of Ketterdam, where wealth and sectarianism rule the day. Everything from the sordid depths of the Barrel to the luxurious heights of the merchant area is described in exquisite detail by Bardugo. Ketterdam is a fantasy yet realistic setting thanks to the author’s careful attention to detail, the city’s distinctive cultural influences, and the complexity of its social relations.

Six of Crows explores many serious ideas in addition to its exciting plot. Bardugo explores themes of loyalty, identity, and people’s willingness to resort to extreme measures for their own survival. The characters, each carrying the weight of their own secrets and traumas, must face their histories and make difficult decisions in order to go forward. The themes of forgiveness, love, and friendship that Bardugo explores make this more than just an action story.
One of the best parts of Six of Crows is the banter between the various characters. Trust, friendship, and love tension are just few of the elements that Bardugo uses to effectively build evolving relationships throughout the novel. The dialogue between the characters is humorous and insightful, and the bonds they create with one another emotionally make the reader care deeply about their adventures. Bardugo weaves a complex web of relationships between the main characters while still advancing the plot of the heist.
The fantasy novel Six of Crows by Leigh Bardugo is a masterwork full of exciting heist scenes, well-developed settings, and memorable characters. It’s a page-turner that will leave you breathless with its colourful cast, exciting plot, and probing of deep subjects.



A Comparative Analysis of “Shadow and Bone” TV Show and Books
by Maia Hagai (Year 12), Senior PrefectThe habit of turning popular novels into a television series has gained popularity in recent years. The film “Shadow and Bone,” based on Leigh Bardugo’s best-selling Grishaverse books, is one such adaptation that has become very successful. The Netflix drama brings to life the enchanted realm full of shadowy powers, political intrigue, and unforgettable personalities. In this piece, we examine how the “Shadow and Bone” TV programme and the original novels both stay true to the Grishaverse, while also introducing new ideas.
When it comes to film adaptations of renowned books, audiences place a high value on authenticity to the original work. In this respect, “Shadow and Bone” is successful in its adaptation of the novels, remaining faithful to the original plot, characters, and the magically enhanced world of Ravka. The TV programme successfully adapts the novels’ rich visuals and intricate world-building for the small screen, providing an engrossing experience for viewers old and new.
The characters’ depictions are always a highlight of any film adaptation. The legendary figures of the Grishaverse come to life in “Shadow and Bone,” completely realised and given rich characterizations. Jessie Mei Li’s portrayal of Alina Starkov, the Sun Summoner, is spot-on in terms of capturing the character’s fragility and resolve as written. Supporting characters are likewise well done, with standout performances from Ben Barnes as the mysterious Darkling and Freddy Carter as the charming rogue Kaz Brekker.
While staying true to the source material, the TV programme adds new elements to the Grishaverse that will please both new and old viewers. The programme builds a more interwoven world by combining themes from Bardugo’s earlier novels, such as the “Six of Crows” duology, which helps the audience better grasp the complicated political environment and introduces beloved characters from across the books. Fans of the novels will find this new material to be a welcome addition, adding depth and excitement to the plot.
The visuals of “Shadow and Bone” are fantastic, vividly evoking the enchanted universe of the Grishaverse. The show’s set, costumes, and visual effects come together to create an atmosphere that is both realistic and fantastic. The TV programme brilliantly depicts the striking contrast between the splendour of the Little Palace and the grime of the streets of Ketterdam. The novels’ vibrant vision is complemented by the films’ meticulous attention to detail and aesthetic appeal.
The TV programme “Shadow and Bone” likewise is an impressive adaptation of Leigh Bardugo’s Grishaverse books. While staying true to the spirit of the original books, the adaptation also adds new material and brings in fan favourites from elsewhere in the series. Fans of the novels and those who haven’t read them yet should see it because of the film’s fidelity to the original material, the strong performances, and the immersive world-building. It’s a credit to the staying power of literature and the enchantment of television that this programme has paved the way for future adaptations of the Grishaverse.




















TIV #2 2022-2023 List of contributors
Student Editor: Medeea Constantinescu
IBSB Staff
Kendall Peet, Head of School
Lee Hawkins, Primary School Teacher
Darren Laffar, Secondary School Teacher
Matthew Tansley, Head of Secondary
Janitha Jayathas, PTF President
Alexandru Lacraru, PE Teacher
Carmen Raducanu, Secondary School Teacher
Ioana Anghel, Secondary School Teacher
Jayne Baker, Secondary School Teacher
Alan Cornish, Head of Primary School
Madalina Soare & Deborah Fergurson, Teacher
Victoria Fay, Primary School Teacher
Orla O’Dwyer, Primary School Teacher
Alsion Tansley, Primary School Teacher
Aliviana Sanders, Primary School Teacher
Robin Morrison, Primary School Teacher
Tom Wilson, Primary School Teacher
Daniela Momirleanu, Primary&Seconday School Teacher
Alexandra Ivascu, Primary School Teacher
Aydin Korucuoglu, Secondary School Teacher
Cristina Latcu, Student Counsellor
Delia Ciobanu, Student Counsellor
IBSB Students
Medeea Constantinescu
Maria Sticlea
Teodora Albu
Luca Pietruschievici Balan
Dinu Pietruschievici Balan
Maria Timbolschi Preoteasa
Sara Scarlatescu
Horia Nitu
Alex Serban
Rares Stanciu
Giulia Canale
Lucas Cornish
Carola Canale
Malina Stoica
Antonia Gradinariu
Ana Mihaescu
Andrei Stere
Sandra Curtis
David Kiiovschi
Vlad Nedelcu
Zo Nastase
Andrei Vernon
Ilinca Birsan
Rianna Tanase
Felix Daianu
Haidar Mrad
Andrei Urjan
Roman Tiderle
Victor Samoila Zamfirescu
Maia Hagai


